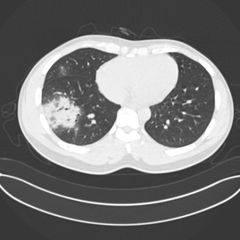

Coronavirus News Review at 10 a.m. EST Daily
Coronavirus Current News:
https://www.inoreader.com/stream/user/1006407045/tag/Coronavirus%20News/view/html?cs=m&sb=y
Selected Articles Review From The News And Times -
https://thenewsandtimes.blogspot.com/
Current Selected Articles: https://www.inoreader.com/stream/user/1006407045/tag/user-favorites/view/html
All Current Articles: https://www.inoreader.com/stream/user/1006407045/tag/all-articles/view/html |
 | Beijing locks down some areas as COVID-19 cases mount - Star Tribune |
| Beijing locks down some areas as COVID-19 cases mount Star Tribune |
 "Covid-19" - Google News 3m "Covid-19" - Google News 3m |
| Nine Omicron symptoms affecting fully vaccinated — and two early signs you might... |
| Nine Omicron symptoms affecting fully vaccinated — and two early signs you might have it The Independent |
 "Omicron" - Google News 5m "Omicron" - Google News 5m |
| Disease X-19 Epidemiology from Michael_Novakhov (39 sites): Google Alert - Coronavirus... |
| ... health expert who has helped the federal government with its COVID-19 ... Director of HIV, TB and... |
 Disease X-19 from Michael_Novakhov (12 sites) 9m Disease X-19 from Michael_Novakhov (12 sites) 9m |
| Disease X-19 Epidemiology from Michael_Novakhov (39 sites): Google Alert - Coronavirus... |
| The Republican Party convention showed both its opportunities and challenges ... cut health care benefits... |
 Disease X-19 from Michael_Novakhov (12 sites) 9m Disease X-19 from Michael_Novakhov (12 sites) 9m |
| Disease X-19 Epidemiology from Michael_Novakhov (39 sites): Google Alert - Coronavirus... |
| ... high-quality care, but how frequently they use it varies widely. ... dramatic eruption in its adoption... |
 Disease X-19 from Michael_Novakhov (12 sites) 9m Disease X-19 from Michael_Novakhov (12 sites) 9m |
| Disease X-19 Epidemiology from Michael_Novakhov (39 sites): Google Alert - Coronavirus... |
| Shortages of COVID in-home testing kits became rampant in late 2021 ... Californians this year will decide... |
 Disease X-19 from Michael_Novakhov (12 sites) 9m Disease X-19 from Michael_Novakhov (12 sites) 9m |
| Disease X-19 Epidemiology from Michael_Novakhov (39 sites): Google Alert - Coronavirus... |
| NPR: How COVID's Deadly ... withhold services or refuse jobs to ... Google Alert - Coronavirus in health... |
 Disease X-19 from Michael_Novakhov (12 sites) 9m Disease X-19 from Michael_Novakhov (12 sites) 9m |
| Disease X-19 Epidemiology from Michael_Novakhov (39 sites): Google Alert - Coronavirus... |
| THE PHILIPPINES might experience another surge in coronavirus infections by ... those living with HIV,... |
 Disease X-19 from Michael_Novakhov (12 sites) 9m Disease X-19 from Michael_Novakhov (12 sites) 9m |
| Disease X-19 Epidemiology from Michael_Novakhov (39 sites): Google Alert - coronavirus... |
| This photo illustration shows how Van Duyn nursing home paid about $60 ... Two-thirds of Onondaga County's... |
 Disease X-19 from Michael_Novakhov (12 sites) 9m Disease X-19 from Michael_Novakhov (12 sites) 9m |
| Disease X-19 Epidemiology from Michael_Novakhov (39 sites): Google Alert - coronavirus... |
| PolitiFact: Fact Check: COVID-19 Is Snake Venom, Claims Anti-Vax ... the mRNA COVID-19 vaccines and drinking... |
 Disease X-19 from Michael_Novakhov (12 sites) 9m Disease X-19 from Michael_Novakhov (12 sites) 9m |
| Disease X-19 Epidemiology from Michael_Novakhov (39 sites): Google Alert - Coronavirus... |
| Meanwhile, Beijing districts were placed under lockdown as COVID cases in the Chinese capital mount.... |
 Disease X-19 from Michael_Novakhov (12 sites) 9m Disease X-19 from Michael_Novakhov (12 sites) 9m |
| Disease X-19 Epidemiology from Michael_Novakhov (39 sites): Google Alert - covid-19... |
| Rapid antigen Covid-19 tests, better known as home tests, have become more common in households across... |
 Disease X-19 from Michael_Novakhov (12 sites) 9m Disease X-19 from Michael_Novakhov (12 sites) 9m |
| Barcelona 2022: Week of news kicks off with Fish Pool/ DNB salmon seminar - Undercurrent... |
| Barcelona 2022: Week of news kicks off with Fish Pool/ DNB salmon seminar Undercurrent News |
 "Coronavirus in fish and seafood" - Google News 12m "Coronavirus in fish and seafood" - Google News 12m |
| SHIELD T3 opens new COVID-testing lab in Texas - PR Newswire |
| SHIELD T3 opens new COVID-testing lab in Texas PR Newswire |
 "COVID" - Google News 26m "COVID" - Google News 26m |
| Illinois rolls out new method for COVID vaccine reminders as cases rise - Rockford... |
| Illinois rolls out new method for COVID vaccine reminders as cases rise Rockford Register Star |
 "COVID" - Google News 26m "COVID" - Google News 26m |
| Fulgent Agrees to Buy Texas Testing Firm Inform Diagnostics for $170M, boosting its... |
| Fulgent Agrees to Buy Texas Testing Firm Inform Diagnostics for $170M, boosting its non-Covid testing... |
 "COVID" - Google News 26m "COVID" - Google News 26m |
| Biden administration to promote availability of COVID antiviral pill - KOMO News |
| Biden administration to promote availability of COVID antiviral pill KOMO News |
 "COVID" - Google News 26m "COVID" - Google News 26m |
| COVID-19 Was Third Leading Cause of Death in US | CDC Online Newsroom - cdc.gov |
| COVID-19 Was Third Leading Cause of Death in US | CDC Online Newsroom cdc.gov |
 "COVID" - Google News 26m "COVID" - Google News 26m |
 | RPI professor collaborating to develop nasal spray to combat COVID-19 - Troy Record |
| RPI professor collaborating to develop nasal spray to combat COVID-19 Troy Record |
 "Covid-19" - Google News 33m "Covid-19" - Google News 33m |
| Beijing Locks Down Some Areas as COVID-19 Cases Mount - U.S. News & World Report |
| Beijing Locks Down Some Areas as COVID-19 Cases Mount U.S. News & World Report |
 "Covid-19" - Google News 33m "Covid-19" - Google News 33m |
| 3 Critically Endangered Sumatran Tigers Lost to Animal Traps - WIBX AM 950 |
| 3 Critically Endangered Sumatran Tigers Lost to Animal Traps WIBX AM 950 |
 "Coronavirus in rodents" - Google News 35m "Coronavirus in rodents" - Google News 35m |
| So far, 'stealth' omicron is proving to be mild in hospitals, despite uptick in cases... |
| So far, 'stealth' omicron is proving to be mild in hospitals, despite uptick in cases Bangor Daily News |
 "Omicron" - Google News 35m "Omicron" - Google News 35m |
| All Kentucky counties in green on state COVID map - 14 News WFIE Evansville |
| All Kentucky counties in green on state COVID map 14 News WFIE Evansville |
 "coronavirus news" - Google News 36m "coronavirus news" - Google News 36m |
| US markets point to losses following sharp global declines - News-Gazette |
| US markets point to losses following sharp global declines News-Gazette |
 "coronavirus news" - Google News 36m "coronavirus news" - Google News 36m |
| Immigration Ties Up Covid Relief Bill As Congress Returns - Kaiser Health News |
| Immigration Ties Up Covid Relief Bill As Congress Returns Kaiser Health News |
 "coronavirus news" - Google News 36m "coronavirus news" - Google News 36m |
| Australia commemorates war dead with few COVID restrictions - The Associated Press |
| Australia commemorates war dead with few COVID restrictions The Associated Press |
 "coronavirus news" - Google News 36m "coronavirus news" - Google News 36m |
| Disease X-19 and Security from Michael_Novakhov (10 sites): Google Alert - Coronavirus... |
| The health department reported zero new COVID-positive deaths. There have been 156 overall ... He was... |
 Disease X-19 from Michael_Novakhov (12 sites) 39m Disease X-19 from Michael_Novakhov (12 sites) 39m |
| Disease X-19 Epidemiology from Michael_Novakhov (39 sites): Google Alert - covid-19... |
| ... County Board of Supervisors could end its Local Disaster Proclamation Resolution that was put in... |
 Disease X-19 from Michael_Novakhov (12 sites) 39m Disease X-19 from Michael_Novakhov (12 sites) 39m |
| Disease X-19 Epidemiology from Michael_Novakhov (39 sites): Google Alert - Coronavirus... |
| A coronavirus outbreak in Beijing is spooking investors worried about the ... The wave of selling continued... |
 Disease X-19 from Michael_Novakhov (12 sites) 39m Disease X-19 from Michael_Novakhov (12 sites) 39m |
| Disease X-19 Epidemiology from Michael_Novakhov (39 sites): Google Alert - covid-19... |
| KEY TAKEAWAYS. Moral distress was the primary emotion experienced by frontline nurses in the early days... |
 Disease X-19 from Michael_Novakhov (12 sites) 39m Disease X-19 from Michael_Novakhov (12 sites) 39m |
| Disease X-19 Epidemiology from Michael_Novakhov (39 sites): Google Alert - Covid-19:... |
| HealthPartners hopes this research will help lower the cost of health care for everyone in the future.... |
 Disease X-19 from Michael_Novakhov (12 sites) 39m Disease X-19 from Michael_Novakhov (12 sites) 39m |
| Disease X-19 Epidemiology from Michael_Novakhov (39 sites): Google Alert - covid-19... |
| A mass COVID-19 testing order in Beijing's biggest district prompted ... to stock up on vegetables, fresh... |
 Disease X-19 from Michael_Novakhov (12 sites) 39m Disease X-19 from Michael_Novakhov (12 sites) 39m |
| Disease X-19 Epidemiology from Michael_Novakhov (39 sites): Google Alert - coronavirus... |
| While coronavirus shots are among the greatest medical achievements of all time, reaching the market... |
 Disease X-19 from Michael_Novakhov (12 sites) 39m Disease X-19 from Michael_Novakhov (12 sites) 39m |
| Disease X-19 Epidemiology from Michael_Novakhov (39 sites): Google Alert - coronavirus... |
| Two reports released in the MMWR use CDC's National Vital Statistics System to look at death rates in... |
 Disease X-19 from Michael_Novakhov (12 sites) 39m Disease X-19 from Michael_Novakhov (12 sites) 39m |
| Disease X-19 Epidemiology from Michael_Novakhov (39 sites): Google Alert - Covid-19:... |
| NeoGenomics, Inc. specializes in cancer genetics testing and ... continue gaining new customers, respond... |
 Disease X-19 from Michael_Novakhov (12 sites) 39m Disease X-19 from Michael_Novakhov (12 sites) 39m |
| Disease X-19 and Security from Michael_Novakhov (10 sites): Google Alert - Coronavirus... |
| WASHINGTON — The nationwide coronavirus death toll is nearing the 1 million mark more than two years... |
 Disease X-19 from Michael_Novakhov (12 sites) 39m Disease X-19 from Michael_Novakhov (12 sites) 39m |
| COVID mitigation for the World Games in Birmingham uncertain - Alabama Political... |
| COVID mitigation for the World Games in Birmingham uncertain Alabama Political Reporter |
 "COVID" - Google News 54m "COVID" - Google News 54m |
| COVID shots still work but researchers hunt new improvements - Tampa Bay Times |
| COVID shots still work but researchers hunt new improvements Tampa Bay Times |
 "COVID" - Google News 54m "COVID" - Google News 54m |
| Smartwatches Track Physiological Changes After COVID-19 Vaccination - Medical Device... |
| Smartwatches Track Physiological Changes After COVID-19 Vaccination Medical Device and Diagnostics Industry |
 "COVID" - Google News 54m "COVID" - Google News 54m |
 | Iberville Parish reports 9 new COVID cases; Louisiana cases surge 24.1% - Post South |
| Iberville Parish reports 9 new COVID cases; Louisiana cases surge 24.1% Post South |
 "Covid-19" - Google News 1h "Covid-19" - Google News 1h |
 | Valneva says the EMA wants additional data about its experimental COVID-19 shot -... |
| Valneva says the EMA wants additional data about its experimental COVID-19 shot MarketWatch |
 "Covid-19" - Google News 1h "Covid-19" - Google News 1h |
 | Canada's Covid-19 Entry Rules Are Changing (Again) Today - Forbes |
| Canada's Covid-19 Entry Rules Are Changing (Again) Today Forbes |
 "Covid-19" - Google News 1h "Covid-19" - Google News 1h |
| Beijing locks down some areas as COVID-19 cases mount - CBS17.com |
| Beijing locks down some areas as COVID-19 cases mount CBS17.com |
 "Covid-19" - Google News 1h "Covid-19" - Google News 1h |
| What doctors wish patients knew about the BA.2 Omicron subvariant - American Medical... |
| What doctors wish patients knew about the BA.2 Omicron subvariant American Medical Association |
 "Omicron" - Google News 1h "Omicron" - Google News 1h |
| Pattern Of Declining NYC Covid Cases Offers Encouragement - Kaiser Health News |
| Pattern Of Declining NYC Covid Cases Offers Encouragement Kaiser Health News |
 "coronavirus news" - Google News 1h "coronavirus news" - Google News 1h |
| The Race-Based Medical Formula Keeping Some Black Men in Prison - The New York Times |
| The Race-Based Medical Formula Keeping Some Black Men in Prison The New York Times |
 "Coronavirus Origins Are Still Uncertain - US Intel Probe" - Google News 1h "Coronavirus Origins Are Still Uncertain - US Intel Probe" - Google News 1h |
| Covid-19 data reporting is becoming less frequent, making trends harder to track... |
| Covid-19 data reporting is becoming less frequent, making trends harder to track WDJT |
 "COVID" - Google News 1h "COVID" - Google News 1h |
| Stock market news live updates: Stock futures fall amid China's COVID restrictions,... |
| Stock market news live updates: Stock futures fall amid China's COVID restrictions, packed earnings week Yahoo... |
 "COVID" - Google News 1h "COVID" - Google News 1h |
| Yes, wearing a mask can help protect you from getting COVID, even if others around... |
| Yes, wearing a mask can help protect you from getting COVID, even if others around you are not wearing... |
 "COVID" - Google News 1h "COVID" - Google News 1h |
| China's pursuit of zero Covid driving expats away - FRANCE 24 English |
| China's pursuit of zero Covid driving expats away FRANCE 24 English |
 "COVID" - Google News 1h "COVID" - Google News 1h |
| One Grim Statistic Lays Bare The Truly Relentless Grip of Long COVID - ScienceAlert |
| One Grim Statistic Lays Bare The Truly Relentless Grip of Long COVID ScienceAlert |
 "COVID" - Google News 1h "COVID" - Google News 1h |
 | COVID-19: What you need to know about the coronavirus pandemic - World Economic Forum |
| COVID-19: What you need to know about the coronavirus pandemic World Economic Forum |
 "Covid-19" - Google News 1h "Covid-19" - Google News 1h |
 | Opinion: More Covid-19 funding is needed to stay ahead in the next battle - Channel3000.com... |
| Opinion: More Covid-19 funding is needed to stay ahead in the next battle Channel3000.com - WISC-TV3 |
 "Covid-19" - Google News 1h "Covid-19" - Google News 1h |
 | Despite COVID-19 entering endemic phase, health experts urge caution - ktvo.com |
| Despite COVID-19 entering endemic phase, health experts urge caution ktvo.com |
 "Covid-19" - Google News 1h "Covid-19" - Google News 1h |
| Omicron XE is being watched by scientists as 1,179 are infected - Kent Online |
| Omicron XE is being watched by scientists as 1,179 are infected Kent Online |
 "Omicron" - Google News 1h "Omicron" - Google News 1h |
| Spike in COVID cases could be a flare-up of Omicron subvariant - Health Dept - CapeTalk |
| Spike in COVID cases could be a flare-up of Omicron subvariant - Health Dept CapeTalk |
 "Omicron" - Google News 1h "Omicron" - Google News 1h |
| What Are Symptoms of 'Stealth' Omicron or BA.2 as Subvariant Now Dominant Strain... |
| What Are Symptoms of 'Stealth' Omicron or BA.2 as Subvariant Now Dominant Strain NBC Chicago |
 "Omicron" - Google News 1h "Omicron" - Google News 1h |
| COVID-19: What you need to know about the coronavirus pandemic - World Economic Forum |
| COVID-19: What you need to know about the coronavirus pandemic World Economic Forum |
 "coronavirus news" - Google News 1h "coronavirus news" - Google News 1h |
| Unvaccinated people increase risk of COVID-19 infection among vaccinated: new study... |
| Unvaccinated people increase risk of COVID-19 infection among vaccinated: new study Global News |
 "coronavirus news" - Google News 1h "coronavirus news" - Google News 1h |
| Disease X-19 Publications from Michael_Novakhov (5 sites): Google Alert - coronavirus... |
| Twitter's board and Tesla CEO Elon Musk negotiated into the early hours of Monday over his bid to buy... |
 Disease X-19 from Michael_Novakhov (12 sites) 1h Disease X-19 from Michael_Novakhov (12 sites) 1h |
| Disease X-19 Epidemiology from Michael_Novakhov (39 sites): Google Alert - Sars Cov-2... |
| ... the Biden administration's coronavirus response team, about the latest on mask requirements and the... |
 Disease X-19 from Michael_Novakhov (12 sites) 1h Disease X-19 from Michael_Novakhov (12 sites) 1h |
| Disease X-19 Epidemiology from Michael_Novakhov (39 sites): Google Alert - Sars Cov-2... |
| Upon completion of these steps, animal and then clinical trials will be ... Even though sales rise was... |
 Disease X-19 from Michael_Novakhov (12 sites) 1h Disease X-19 from Michael_Novakhov (12 sites) 1h |
| Disease X-19 Epidemiology from Michael_Novakhov (39 sites): Google Alert - covid-19... |
| People in Beijing have stockpiled food and other supplies, as the city's biggest district began mass... |
 Disease X-19 from Michael_Novakhov (12 sites) 1h Disease X-19 from Michael_Novakhov (12 sites) 1h |
| Disease X-19 and Security from Michael_Novakhov (10 sites): Google Alert - Coronavirus... |
| Two large fires have broken out at multiple oil facilities in the Russian city of Bryansk overnight,... |
 Disease X-19 from Michael_Novakhov (12 sites) 1h Disease X-19 from Michael_Novakhov (12 sites) 1h |
| Disease X-19 Epidemiology from Michael_Novakhov (39 sites): Google Alert - coronavirus... |
| Apr 25, 2022 Coronavirus Outbreak on Optical Transceivers Market, ... Alopecia Areata Market Size, Epidemiology,... |
 Disease X-19 from Michael_Novakhov (12 sites) 1h Disease X-19 from Michael_Novakhov (12 sites) 1h |
| Disease X-19 Epidemiology from Michael_Novakhov (39 sites): Google Alert - coronavirus... |
| Those who have already received three doses of the COVID-19 vaccine and have also been infected with... |
 Disease X-19 from Michael_Novakhov (12 sites) 1h Disease X-19 from Michael_Novakhov (12 sites) 1h |
| Disease X-19 and Security from Michael_Novakhov (10 sites): Google Alert - coronavirus... |
| And we see the real Mafia get involved in the making of the movie about the Mafia, with some trying to... |
 Disease X-19 from Michael_Novakhov (12 sites) 1h Disease X-19 from Michael_Novakhov (12 sites) 1h |
| Disease X-19 Epidemiology from Michael_Novakhov (39 sites): Google Alert - coronavirus... |
| In March 2020, as the pandemic gripped the country and no vaccines were available, Congress passed the... |
 Disease X-19 from Michael_Novakhov (12 sites) 1h Disease X-19 from Michael_Novakhov (12 sites) 1h |
| Disease X-19 Regions from Michael_Novakhov (8 sites): Google Alert - coronavirus... |
| Beginning two weeks ago, upon the reopening of the universities after a two-year lockdown due to the... |
 Disease X-19 from Michael_Novakhov (12 sites) 1h Disease X-19 from Michael_Novakhov (12 sites) 1h |
| Disease X-19 Epidemiology from Michael_Novakhov (39 sites): Google Alert - coronavirus... |
| Schooling in a Pandemic ... in Philadelphia public schools were required to wear masks for the week after... |
 Disease X-19 from Michael_Novakhov (12 sites) 1h Disease X-19 from Michael_Novakhov (12 sites) 1h |
| Disease X-19 Epidemiology from Michael_Novakhov (39 sites): Google Alert - coronavirus... |
| People who are unvaccinated against COVID-19 not only place themselves at greater ... the study's lead... |
 Disease X-19 from Michael_Novakhov (12 sites) 1h Disease X-19 from Michael_Novakhov (12 sites) 1h |
| Disease X-19 Epidemiology from Michael_Novakhov (39 sites): Google Alert - covid-19... |
| According to data from the National COVID-19 Vaccination Dashboard, ... Aside from superspreader events,... |
 Disease X-19 from Michael_Novakhov (12 sites) 1h Disease X-19 from Michael_Novakhov (12 sites) 1h |
| Disease X-19 Epidemiology from Michael_Novakhov (39 sites): Google Alert - coronavirus... |
| Trade fair Design Shanghai has rescheduled this year's event as the city is in lockdown following a coronavirus... |
 Disease X-19 from Michael_Novakhov (12 sites) 1h Disease X-19 from Michael_Novakhov (12 sites) 1h |
| Disease X-19 and Security from Michael_Novakhov (10 sites): Google Alert - Coronavirus... |
| Part of that new military assistance funding will help Ukraine transition to NATO-capable systems, the... |
 Disease X-19 from Michael_Novakhov (12 sites) 1h Disease X-19 from Michael_Novakhov (12 sites) 1h |
| Disease X-19 Regions from Michael_Novakhov (8 sites): Google Alert - coronavirus... |
| TEHRAN Tasnim ndash The number of coronavirus patients admitted to the hospital across Iran over the... |
 Disease X-19 from Michael_Novakhov (12 sites) 1h Disease X-19 from Michael_Novakhov (12 sites) 1h |
| Disease X-19 and Security from Michael_Novakhov (10 sites): Google Alert - Coronavirus... |
| "The President has been very clear there will be no US troops fighting in Ukraine and that includes the... |
 Disease X-19 from Michael_Novakhov (12 sites) 1h Disease X-19 from Michael_Novakhov (12 sites) 1h |
| Disease X-19 Regions from Michael_Novakhov (8 sites): Google Alert - coronavirus... |
| TEHRAN (Tasnim) – The number of coronavirus patients admitted to the hospital across Iran over the past... |
 Disease X-19 from Michael_Novakhov (12 sites) 1h Disease X-19 from Michael_Novakhov (12 sites) 1h |
| Disease X-19 Regions from Michael_Novakhov (8 sites): Google Alert - coronavirus... |
| US President Joe Biden has accepted Israeli Prime Minister Naftali Bennett's ... Even during these difficult... |
 Disease X-19 from Michael_Novakhov (12 sites) 1h Disease X-19 from Michael_Novakhov (12 sites) 1h |
| Disease X-19 Regions from Michael_Novakhov (8 sites): Google Alert - coronavirus... |
| As part of the government's roadmap out of Covid restrictions and into a gradual return to normality,... |
 Disease X-19 from Michael_Novakhov (12 sites) 1h Disease X-19 from Michael_Novakhov (12 sites) 1h |
| Sea Bass Market Growth Size is Estimated to Grow at Incredible CAGR till 2030 – Ripon... |
| Sea Bass Market Growth Size is Estimated to Grow at Incredible CAGR till 2030 – Ripon College Days Ripon... |
 "Coronavirus in fish and seafood" - Google News 1h "Coronavirus in fish and seafood" - Google News 1h |
| Yuan Plunges 1% for Second Day as China Covid Outbreak Worsens - Bloomberg |
| Yuan Plunges 1% for Second Day as China Covid Outbreak Worsens Bloomberg |
 "COVID" - Google News 1h "COVID" - Google News 1h |
| Valneva Stock Falls as Drug Regulator Seeks Data on Covid Shot - Bloomberg |
| Valneva Stock Falls as Drug Regulator Seeks Data on Covid Shot Bloomberg |
 "COVID" - Google News 1h "COVID" - Google News 1h |
| COVID-19 cases on the rise in King County in recent weeks - KIRO Seattle |
| COVID-19 cases on the rise in King County in recent weeks KIRO Seattle |
 "COVID" - Google News 1h "COVID" - Google News 1h |
| Weekly Scientific Discussion Thread - April 25, 2022 |
| This weekly thread is for scientific discussion pertaining to COVID-19. Please post questions about the... |
 COVID-19 1h COVID-19 1h |
 | Covid-19 data reporting is becoming less frequent, making trends harder to track... |
| Covid-19 data reporting is becoming less frequent, making trends harder to track CNN |
 "Covid-19" - Google News 2h "Covid-19" - Google News 2h |
 | Can you use an expired at-home Covid-19 test? - CNN |
| Can you use an expired at-home Covid-19 test? CNN |
 "Covid-19" - Google News 2h "Covid-19" - Google News 2h |
| Supervisors could terminate local disaster proclamation from COVID-19 - Chico Enterprise-Record |
| Supervisors could terminate local disaster proclamation from COVID-19 Chico Enterprise-Record |
 "Covid-19" - Google News 2h "Covid-19" - Google News 2h |
| IDPH adopts new federal guidelines for reporting COVID-19 data - Metropolis Planet |
| IDPH adopts new federal guidelines for reporting COVID-19 data Metropolis Planet |
 "Covid-19" - Google News 2h "Covid-19" - Google News 2h |
| Iron ore prices crash as Omicron grips Beijing - News24 |
| Iron ore prices crash as Omicron grips Beijing News24 |
 "Omicron" - Google News 2h "Omicron" - Google News 2h |
| Coronavirus: US COVID-19 death toll nears 1 million - KIRO Seattle |
| Coronavirus: US COVID-19 death toll nears 1 million KIRO Seattle |
 "coronavirus news" - Google News 2h "coronavirus news" - Google News 2h |
| COVID: Vaccinated boost risk being with unvaccinated: study - CTV News |
| COVID: Vaccinated boost risk being with unvaccinated: study CTV News |
 "coronavirus news" - Google News 2h "coronavirus news" - Google News 2h |
| Disease X-19 Epidemiology from Michael_Novakhov (39 sites): Google Alert - covid-19... |
| The restaurant went into "hibernation" during the height of the COVID-19 pandemic. Now it's back, offering... |
 Disease X-19 from Michael_Novakhov (12 sites) 2h Disease X-19 from Michael_Novakhov (12 sites) 2h |
| Disease X-19 Epidemiology from Michael_Novakhov (39 sites): Google Alert - coronavirus... |
| Trade fair Design Shanghai has rescheduled this year's event as the city is in lockdown due to coronavirus.... |
 Disease X-19 from Michael_Novakhov (12 sites) 2h Disease X-19 from Michael_Novakhov (12 sites) 2h |
| Disease X-19 Epidemiology from Michael_Novakhov (39 sites): Google Alert - coronavirus... |
| SHANGHAI: Shanghai's COVID-19 lockdown misery dragged into a fourth week, as orders on Monday (Apr 25)... |
 Disease X-19 from Michael_Novakhov (12 sites) 2h Disease X-19 from Michael_Novakhov (12 sites) 2h |
| Disease X-19 Epidemiology from Michael_Novakhov (39 sites): Google Alert - covid-19... |
| Global Frozen Cha Siu Bao(Barbecue Pork Buns) Market from 2022 to 2028 just published a study on the... |
 Disease X-19 from Michael_Novakhov (12 sites) 2h Disease X-19 from Michael_Novakhov (12 sites) 2h |
| Disease X-19 Epidemiology from Michael_Novakhov (39 sites): Google Alert - coronavirus... |
| A new outbreak of COVID-19 in China's capital Beijing had investors fretting early Monday as officials... |
 Disease X-19 from Michael_Novakhov (12 sites) 2h Disease X-19 from Michael_Novakhov (12 sites) 2h |
| Disease X-19 Epidemiology from Michael_Novakhov (39 sites): Google Alert - coronavirus... |
| Half of healthcare facilities in LDCs lack basic water services. ... gap in water and sanitation services... |
 Disease X-19 from Michael_Novakhov (12 sites) 2h Disease X-19 from Michael_Novakhov (12 sites) 2h |
| Disease X-19 Epidemiology from Michael_Novakhov (39 sites): Google Alert - coronavirus... |
| A man takes nucleic acid test at a mobile testing site following the coronavirus disease (COVID-19) outbreak... |
 Disease X-19 from Michael_Novakhov (12 sites) 2h Disease X-19 from Michael_Novakhov (12 sites) 2h |
| Disease X-19 Epidemiology from Michael_Novakhov (39 sites): Google Alert - mink:... |
| Uninhabited island gets new residents as American mink moves in · CalMac says 'ageing fleet' to blame... |
 Disease X-19 from Michael_Novakhov (12 sites) 2h Disease X-19 from Michael_Novakhov (12 sites) 2h |
| Disease X-19 Epidemiology from Michael_Novakhov (39 sites): Google Alert - coronavirus... |
| "Obviously if you have to choose between getting a vaccine versus getting COVID, I would highly recommend... |
 Disease X-19 from Michael_Novakhov (12 sites) 2h Disease X-19 from Michael_Novakhov (12 sites) 2h |
| Disease X-19 Epidemiology from Michael_Novakhov (39 sites): Google Alert - coronavirus... |
| The latest outbreak in Shanghai, first detected in late March, has seen more than 400,000 cases recorded... |
 Disease X-19 from Michael_Novakhov (12 sites) 2h Disease X-19 from Michael_Novakhov (12 sites) 2h |
| Disease X-19 Publications from Michael_Novakhov (5 sites): Google Alert - coronavirus... |
| When Elon Musk offered to buy Twitter for $43 billion 10 days ago, the platform didn't welcome him with... |
 Disease X-19 from Michael_Novakhov (12 sites) 2h Disease X-19 from Michael_Novakhov (12 sites) 2h |
| Disease X-19 Publications from Michael_Novakhov (5 sites): Google Alert - new york... |
| The New York Times reports that Twitter's board and Tesla CEO Elon Musk are negotiating over his bid... |
 Disease X-19 from Michael_Novakhov (12 sites) 2h Disease X-19 from Michael_Novakhov (12 sites) 2h |
| Disease X-19 Publications from Michael_Novakhov (5 sites): Google Alert - new york... |
| China is meddling with free enterprise as it hasn't in decades. The results are familiar to those old... |
 Disease X-19 from Michael_Novakhov (12 sites) 2h Disease X-19 from Michael_Novakhov (12 sites) 2h |
| Disease X-19 Publications from Michael_Novakhov (5 sites): Google Alert - new york... |
| Mary Ann Neilsen holds her last Paxlovid pills while recovering from COVID-19 in Santa Barara, Calif.... |
 Disease X-19 from Michael_Novakhov (12 sites) 2h Disease X-19 from Michael_Novakhov (12 sites) 2h |
| Disease X-19 Publications from Michael_Novakhov (5 sites): Google Alert - coronavirus... |
| Photo: Sarahbeth Maney/The New York Times/Bloomberg via Getty Images. The U.S. and Israel will hold a... |
 Disease X-19 from Michael_Novakhov (12 sites) 2h Disease X-19 from Michael_Novakhov (12 sites) 2h |
| Disease X-19 Publications from Michael_Novakhov (5 sites): Google Alert - coronavirus... |
| NYC Gilded Age mansion lists for the first time in 40 years, ... According to the New York Post, the... |
 Disease X-19 from Michael_Novakhov (12 sites) 2h Disease X-19 from Michael_Novakhov (12 sites) 2h |
| CDC urges masks in Monroe County due to rising COVID levels. The latest - Democrat... |
| CDC urges masks in Monroe County due to rising COVID levels. The latest Democrat & Chronicle |
 "COVID" - Google News 2h "COVID" - Google News 2h |
| Digital, deliveries took on bigger role at area libraries during COVID pandemic -... |
| Digital, deliveries took on bigger role at area libraries during COVID pandemic Marshall Independent |
 "COVID" - Google News 2h "COVID" - Google News 2h |
| Hunter Biden and His Laptop Are Prime Targets If Republicans Win Congress - Bloomberg |
| Hunter Biden and His Laptop Are Prime Targets If Republicans Win Congress Bloomberg |
 "covid -19 origins" - Google News 2h "covid -19 origins" - Google News 2h |
| 5 things to know for April 25: Ukraine, French elections, Covid-19, Twitter, Nigeria... |
| 5 things to know for April 25: Ukraine, French elections, Covid-19, Twitter, Nigeria - ABC17NEWS ABC17News.com |
 "Covid-19" - Google News 2h "Covid-19" - Google News 2h |
| Under the Currrent Effect of Regional Omicron Outbreaks, How Will Silicon Price Progress... |
| Under the Currrent Effect of Regional Omicron Outbreaks, How Will Silicon Price Progress in Q2/2022 and... |
 "Omicron" - Google News 2h "Omicron" - Google News 2h |
| Prices for groceries, gas and more are rising fast. Here's how that's impacting consumers... |
| Prices for groceries, gas and more are rising fast. Here's how that's impacting consumers and how they're... |
 "Coronavirus in fish and seafood" - Google News 2h "Coronavirus in fish and seafood" - Google News 2h |
| Roche sees slowdown in COVID-driven sales growth - Reuters |
| Roche sees slowdown in COVID-driven sales growth Reuters |
 "COVID" - Google News 2h "COVID" - Google News 2h |
| Hawaii doctors prescribing antiviral pills for COVID - Honolulu Star-Advertiser |
| Hawaii doctors prescribing antiviral pills for COVID Honolulu Star-Advertiser |
 "COVID" - Google News 2h "COVID" - Google News 2h |
| Berks COVID cases up by 15 in latest report - Reading Eagle |
| Berks COVID cases up by 15 in latest report Reading Eagle |
 "COVID" - Google News 2h "COVID" - Google News 2h |
| Moderna recalls thousands of COVID vaccine doses in Europe - Reuters |
| Moderna recalls thousands of COVID vaccine doses in Europe Reuters |
 "COVID" - Google News 2h "COVID" - Google News 2h |
| Hunter Biden is prime target if Republicans win Congress - Spectrum News 1 |
| Hunter Biden is prime target if Republicans win Congress Spectrum News 1 |
 "covid -19 origins" - Google News 2h "covid -19 origins" - Google News 2h |
 | Anti-SARS-CoV-2 spike antibody levels following COVID-19 BNT162b2 vaccination - News-Medical.Net |
| Anti-SARS-CoV-2 spike antibody levels following COVID-19 BNT162b2 vaccination News-Medical.Net |
 "COVID-19" - Google News 3h "COVID-19" - Google News 3h |
 | 5 things to know for April 25: Ukraine, French elections, Covid-19, Twitter, Nigeria... |
| 5 things to know for April 25: Ukraine, French elections, Covid-19, Twitter, Nigeria CNN |
 "COVID-19" - Google News 3h "COVID-19" - Google News 3h |
| Risk of hospitalisation associated with infection with SARS-CoV-2 omicron variant... |
| Risk of hospitalisation associated with infection with SARS-CoV-2 omicron variant versus delta variant... |
 "Omicron" - Google News 3h "Omicron" - Google News 3h |
| Disease X-19 General Issues from Michael_Novakhov (5 sites): Google Alert - Covid-19:... |
| The university is urging to move events outdoors and use the grab-and-go option for on-campus meals.... |
 Disease X-19 from Michael_Novakhov (12 sites) 3h Disease X-19 from Michael_Novakhov (12 sites) 3h |
| Disease X-19 General Issues from Michael_Novakhov (5 sites): Google Alert - Latest... |
| The Chaoyang district reported 26 cases over the weekend - the highest number so far in Beijing's latest... |
 Disease X-19 from Michael_Novakhov (12 sites) 3h Disease X-19 from Michael_Novakhov (12 sites) 3h |
| Disease X-19 General Issues from Michael_Novakhov (5 sites): Google Alert - Covid-19:... |
| The Tunisian authorities' response to the Covid-19 pandemic, particularly their management of the country's... |
 Disease X-19 from Michael_Novakhov (12 sites) 3h Disease X-19 from Michael_Novakhov (12 sites) 3h |
| Disease X-19 General Issues from Michael_Novakhov (5 sites): Google Alert - sars... |
| These new data showed an antiviral effect: S-217622 demonstrated rapid clearance of the infectious SARS-CoV-2... |
 Disease X-19 from Michael_Novakhov (12 sites) 3h Disease X-19 from Michael_Novakhov (12 sites) 3h |
| Disease X-19 General Issues from Michael_Novakhov (5 sites): Google Alert - sars... |
| The authors further explain that this is one of the first studies to examine the effectiveness of booster... |
 Disease X-19 from Michael_Novakhov (12 sites) 3h Disease X-19 from Michael_Novakhov (12 sites) 3h |
| Biden administration to promote availability of COVID antiviral pill - WKRC TV Cincinnati |
| Biden administration to promote availability of COVID antiviral pill WKRC TV Cincinnati |
 "COVID" - Google News 3h "COVID" - Google News 3h |
| WHO: 1 child has died in mystery liver disease outbreak - WIFR |
| WHO: 1 child has died in mystery liver disease outbreak WIFR |
 "covid -19 origins" - Google News 3h "covid -19 origins" - Google News 3h |
 | CDC Says COVID-19 PCR Swabs Are Sent For 'Genomic Sequencing' |
| submitted by /u/Gawrila [link] [comments] |
 COVID-19 3h COVID-19 3h |
 | Millions of COVID-19 shots set to go to waste, as vaccine rollout slows - ABC News |
| Millions of COVID-19 shots set to go to waste, as vaccine rollout slows ABC News |
 "COVID-19" - Google News 3h "COVID-19" - Google News 3h |
| Vaccine effectiveness against symptomatic disease caused by the Omicron and Delta... |
| Vaccine effectiveness against symptomatic disease caused by the Omicron and Delta variants in England News-Medical.Net |
 "Omicron" - Google News 3h "Omicron" - Google News 3h |
| What is Omicron XE? Symptoms of the new Covid variant as hundreds of cases found... |
| What is Omicron XE? Symptoms of the new Covid variant as hundreds of cases found in UK The Independent |
 "Omicron" - Google News 3h "Omicron" - Google News 3h |
| European stocks fall 2% as global sell-off, China Covid concerns batter sentiment... |
| European stocks fall 2% as global sell-off, China Covid concerns batter sentiment CNBC |
 "coronavirus news" - Google News 3h "coronavirus news" - Google News 3h |
| Disease X-19 Epidemiology from Michael_Novakhov (39 sites): Google Alert - Covid-19:... |
| We are regularly tracking the direct effect of COVID-19 on the market, along with the indirect influence... |
 Disease X-19 from Michael_Novakhov (12 sites) 3h Disease X-19 from Michael_Novakhov (12 sites) 3h |
| Disease X-19 Epidemiology from Michael_Novakhov (39 sites): Google Alert - coronavirus... |
| SHANGHAI – Shanghai authorities battling an outbreak of COVID-19 have erected fences outside residential... |
 Disease X-19 from Michael_Novakhov (12 sites) 3h Disease X-19 from Michael_Novakhov (12 sites) 3h |
| Disease X-19 Epidemiology from Michael_Novakhov (39 sites): Google Alert - coronavirus... |
| As vaccine makers rush to stamp out new Covid-19 variants, some scientists have set their sights higher,... |
 Disease X-19 from Michael_Novakhov (12 sites) 3h Disease X-19 from Michael_Novakhov (12 sites) 3h |
| Disease X-19 Epidemiology from Michael_Novakhov (39 sites): Google Alert - Sars Cov-2... |
| As vaccine makers rush to stamp out new Covid-19 variants, ... jump from animals to humans this century:... |
 Disease X-19 from Michael_Novakhov (12 sites) 3h Disease X-19 from Michael_Novakhov (12 sites) 3h |
| Disease X-19 Epidemiology from Michael_Novakhov (39 sites): Google Alert - coronavirus... |
| "Elderly people's immunity drops along with age and they usually have one ... Currently, the promotion... |
 Disease X-19 from Michael_Novakhov (12 sites) 3h Disease X-19 from Michael_Novakhov (12 sites) 3h |
| Disease X-19 Epidemiology from Michael_Novakhov (39 sites): Google Alert - coronavirus... |
| As vaccine makers rush to stamp out new Covid-19 variants, ... now starting to mutate specifically to... |
 Disease X-19 from Michael_Novakhov (12 sites) 3h Disease X-19 from Michael_Novakhov (12 sites) 3h |
| Disease X-19 Epidemiology from Michael_Novakhov (39 sites): Google Alert - coronavirus... |
| ... COVID vaccination rates are high, said Dr. David Fisman, the study's lead author and professor of... |
 Disease X-19 from Michael_Novakhov (12 sites) 3h Disease X-19 from Michael_Novakhov (12 sites) 3h |
| Disease X-19 Epidemiology from Michael_Novakhov (39 sites): Google Alert - coronavirus... |
| Despite evidence relating effectiveness of the current crop of vaccines used against coronavirus disease... |
 Disease X-19 from Michael_Novakhov (12 sites) 3h Disease X-19 from Michael_Novakhov (12 sites) 3h |
| Disease X-19 Epidemiology from Michael_Novakhov (39 sites): Google Alert - Covid-19:... |
| DNA Analysis; Genetic Studies; Anthropology; Others. To Understand How COVID-19 Impact is Covered in... |
 Disease X-19 from Michael_Novakhov (12 sites) 3h Disease X-19 from Michael_Novakhov (12 sites) 3h |
| Disease X-19 Epidemiology from Michael_Novakhov (39 sites): Google Alert - Covid-19:... |
| Shanghai, a vast city of 26 million people, has reported 2,472 positive cases and 16,983 asymptomatic... |
 Disease X-19 from Michael_Novakhov (12 sites) 3h Disease X-19 from Michael_Novakhov (12 sites) 3h |
| U.S. stock futures and oil tumble as China's COVID spread adds to Fed rate-hike worries... |
| U.S. stock futures and oil tumble as China's COVID spread adds to Fed rate-hike worries MarketWatch |
 "COVID" - Google News 3h "COVID" - Google News 3h |
| Cathay Adds Hong Kong-London Flights as City Eases Covid Rules - Bloomberg |
| Cathay Adds Hong Kong-London Flights as City Eases Covid Rules Bloomberg |
 "COVID" - Google News 3h "COVID" - Google News 3h |
| The challenges of Omicron - News-Medical.Net |
| The challenges of Omicron News-Medical.Net |
 "Omicron" - Google News 4h "Omicron" - Google News 4h |
| Covid-19 tests limits of Shanghai hospitals as very ill, elderly infected - South... |
| Covid-19 tests limits of Shanghai hospitals as very ill, elderly infected South China Morning Post |
 "Omicron" - Google News 4h "Omicron" - Google News 4h |
| What is Omicron XE? Symptoms of the new Covid variant as hundreds of cases found... |
| What is Omicron XE? Symptoms of the new Covid variant as hundreds of cases found in UK The Independent |
 "Omicron" - Google News 4h "Omicron" - Google News 4h |
| Omicron XE variant: What is omicron XE? Is it a new COVID variant? - Deseret News |
| Omicron XE variant: What is omicron XE? Is it a new COVID variant? Deseret News |
 "Omicron" - Google News 4h "Omicron" - Google News 4h |
 | Local restaurant describes challenges they still face due to COVID-19 - WHIO |
| Local restaurant describes challenges they still face due to COVID-19 WHIO |
 "COVID-19" - Google News 4h "COVID-19" - Google News 4h |
 | Covid-19 forces cancellation of final 'Anastasia' show - Buffalo News |
| Covid-19 forces cancellation of final 'Anastasia' show Buffalo News |
 "COVID-19" - Google News 4h "COVID-19" - Google News 4h |
| Coronavirus News Live Updates: India reports 2,541 fresh Covid-19 cases, slightly... |
| Coronavirus News Live Updates: India reports 2,541 fresh Covid-19 cases, slightly lower than yesterday;... |
 "coronavirus news" - Google News 4h "coronavirus news" - Google News 4h |
| Washtenaw County health officials keeping an eye on rising COVID-19 cases - WXYZ... |
| Washtenaw County health officials keeping an eye on rising COVID-19 cases WXYZ 7 Action News Detroit |
 "coronavirus news" - Google News 4h "coronavirus news" - Google News 4h |
| COVID cases rise; face masks are urged - Peninsula Daily News |
| COVID cases rise; face masks are urged Peninsula Daily News |
 "coronavirus news" - Google News 4h "coronavirus news" - Google News 4h |
| Disease X-19 Regions from Michael_Novakhov (8 sites): Google Alert - coronavirus... |
| According to China's National Health Commission, 19 new Covid-19 cases were ... spread of Covid-19 in... |
 Disease X-19 from Michael_Novakhov (12 sites) 4h Disease X-19 from Michael_Novakhov (12 sites) 4h |
| Disease X-19 and Security from Michael_Novakhov (10 sites): Google Alert - Coronavirus... |
| "But the impact of cyberattacks carries enormous financial, reputational and ... understanding the impact... |
 Disease X-19 from Michael_Novakhov (12 sites) 4h Disease X-19 from Michael_Novakhov (12 sites) 4h |
| Disease X-19 and Security from Michael_Novakhov (10 sites): Google Alert - Coronavirus... |
| The US remains by far the biggest spender, with $801 billion allocated to the armed forces in 2021, according... |
 Disease X-19 from Michael_Novakhov (12 sites) 4h Disease X-19 from Michael_Novakhov (12 sites) 4h |
| Disease X-19 and Security from Michael_Novakhov (10 sites): Google Alert - Coronavirus... |
| Blinken and Austin discussed the Biden administration's intention to provide $713 million in additional... |
 Disease X-19 from Michael_Novakhov (12 sites) 4h Disease X-19 from Michael_Novakhov (12 sites) 4h |
| Disease X-19 and Security from Michael_Novakhov (10 sites): Google Alert - Coronavirus... |
| Minister for Health Stephen Donnelly said Covid hospital admissions had fallen ... Iran says it thwarted... |
 Disease X-19 from Michael_Novakhov (12 sites) 4h Disease X-19 from Michael_Novakhov (12 sites) 4h |
| Disease X-19 and Security from Michael_Novakhov (10 sites): Google Alert - Coronavirus... |
| They told Zelenskyy and his advisers that the U.S. would provide more than $300 million in foreign military... |
 Disease X-19 from Michael_Novakhov (12 sites) 4h Disease X-19 from Michael_Novakhov (12 sites) 4h |
| Disease X-19 and Security from Michael_Novakhov (10 sites): Google Alert - Coronavirus... |
| NEAR THE POLISH-UKRAINIAN BORDER (AP) — American Secretary of State Antony Blinken and Defense Secretary... |
 Disease X-19 from Michael_Novakhov (12 sites) 4h Disease X-19 from Michael_Novakhov (12 sites) 4h |
| Disease X-19 Regions from Michael_Novakhov (8 sites): Google Alert - coronavirus... |
| Israel's foreign minister on Sunday accused the Hamas militant group of orchestrating recent unrest at... |
 Disease X-19 from Michael_Novakhov (12 sites) 4h Disease X-19 from Michael_Novakhov (12 sites) 4h |
| Disease X-19 and Security from Michael_Novakhov (10 sites): Google Alert - Coronavirus... |
| While only just over 40 cases of Covid-19 have been found in the Chinese capital, authorities have implemented... |
 Disease X-19 from Michael_Novakhov (12 sites) 4h Disease X-19 from Michael_Novakhov (12 sites) 4h |
| Oil joins tumbling commodities as China COVID spread triggers fresh demand worries... |
| Oil joins tumbling commodities as China COVID spread triggers fresh demand worries MarketWatch |
 "COVID" - Google News 4h "COVID" - Google News 4h |
| Biden administration to promote availability of COVID antiviral pill - NBC Montana |
| Biden administration to promote availability of COVID antiviral pill NBC Montana |
 "COVID" - Google News 4h "COVID" - Google News 4h |
 | Tunisia: Barriers to Covid-19 vaccines expose stark disparities in access to health... |
| Tunisia: Barriers to Covid-19 vaccines expose stark disparities in access to health Amnesty International |
 "COVID-19" - Google News 4h "COVID-19" - Google News 4h |
| Gilead Science Says Several Studies Confirm Remdesivir Activity In Treating COVID-19... |
| Gilead Science Says Several Studies Confirm Remdesivir Activity In Treating COVID-19 Nasdaq |
 "COVID-19" - Google News 4h "COVID-19" - Google News 4h |
| Beijing kicks off mass testing after spike in Covid cases - BBC |
| Beijing kicks off mass testing after spike in Covid cases BBC |
 "coronavirus news" - Google News 4h "coronavirus news" - Google News 4h |
| Asian shares fall amid interest rate, earnings worries - News-Gazette |
| Asian shares fall amid interest rate, earnings worries News-Gazette |
 "coronavirus news" - Google News 4h "coronavirus news" - Google News 4h |
| Disease X-19 Epidemiology from Michael_Novakhov (39 sites): Google Alert - covid... |
| The onset of a global pandemic saw women's sport shunted from competition schedules and broadcast agendas.... |
 Disease X-19 from Michael_Novakhov (12 sites) 4h Disease X-19 from Michael_Novakhov (12 sites) 4h |
| Disease X-19 Epidemiology from Michael_Novakhov (39 sites): Google Alert - coronavirus... |
| ... without the restrictions made necessary by the coronavirus pandemic. ... called 'botides,' that involves... |
 Disease X-19 from Michael_Novakhov (12 sites) 4h Disease X-19 from Michael_Novakhov (12 sites) 4h |
| Disease X-19 Epidemiology from Michael_Novakhov (39 sites): Google Alert - Coronavirus... |
| Dr. Taner is a co-author of the study. Related Stories. Evaluating serological responses to repeated... |
 Disease X-19 from Michael_Novakhov (12 sites) 4h Disease X-19 from Michael_Novakhov (12 sites) 4h |
| Disease X-19 Epidemiology from Michael_Novakhov (39 sites): Google Alert - coronavirus... |
| The first recommendation in the report calls for nationwide vaccinations, which will lead to herd immunity.... |
 Disease X-19 from Michael_Novakhov (12 sites) 4h Disease X-19 from Michael_Novakhov (12 sites) 4h |
| Disease X-19 Epidemiology from Michael_Novakhov (39 sites): Google Alert - Coronavirus... |
| Beijingers were flooding supermarkets to stock up on food on Monday, hoping to avoid Shanghai-style shortages... |
 Disease X-19 from Michael_Novakhov (12 sites) 4h Disease X-19 from Michael_Novakhov (12 sites) 4h |
| Disease X-19 Epidemiology from Michael_Novakhov (39 sites): Google Alert - Coronavirus... |
| ... including COVID-19-associated deaths!). At the same time, infectious diseases for which no vaccines... |
 Disease X-19 from Michael_Novakhov (12 sites) 4h Disease X-19 from Michael_Novakhov (12 sites) 4h |
| Disease X-19 Epidemiology from Michael_Novakhov (39 sites): Google Alert - covid-19... |
| INQUIRER.net / 04:19 PM April 25, 2022. MANILA, Philippines — In a bid to lower the price of pork, presidential... |
 Disease X-19 from Michael_Novakhov (12 sites) 4h Disease X-19 from Michael_Novakhov (12 sites) 4h |
| Disease X-19 Epidemiology from Michael_Novakhov (39 sites): Google Alert - Coronavirus... |
| HIV/AIDS patients; Patients with primary immunodeficiencies. The country's FDA granted an EUA for the... |
 Disease X-19 from Michael_Novakhov (12 sites) 4h Disease X-19 from Michael_Novakhov (12 sites) 4h |
| Disease X-19 Epidemiology from Michael_Novakhov (39 sites): Google Alert - Coronavirus... |
| The team at Shropshire Cat Rescue has confirmed that the 'Paws for ... lockers on the lorry-full of crates... |
 Disease X-19 from Michael_Novakhov (12 sites) 4h Disease X-19 from Michael_Novakhov (12 sites) 4h |
| Disease X-19 Epidemiology from Michael_Novakhov (39 sites): Google Alert - COVID-19... |
| The COVID-19 outbreak is now traveling around the world, ... discusses the impact of the virus on leading... |
 Disease X-19 from Michael_Novakhov (12 sites) 4h Disease X-19 from Michael_Novakhov (12 sites) 4h |
| Disease X-19 Publications from Michael_Novakhov (5 sites): Google Alert - coronavirus... |
| And Twitter has reportedly begun negotiations with Elon Musk after pressure from ... Traders are balking... |
 Disease X-19 from Michael_Novakhov (12 sites) 4h Disease X-19 from Michael_Novakhov (12 sites) 4h |
| Disease X-19 Publications from Michael_Novakhov (5 sites): Google Alert - new york... |
| The crisis on public transit systems threatens the nation's recovery from the coronavirus pandemic: Restoring... |
 Disease X-19 from Michael_Novakhov (12 sites) 4h Disease X-19 from Michael_Novakhov (12 sites) 4h |
| Disease X-19 Publications from Michael_Novakhov (5 sites): Google Alert - new york... |
| Macron's unusual achievement in securing five more years in power reflected his effective stewardship... |
 Disease X-19 from Michael_Novakhov (12 sites) 4h Disease X-19 from Michael_Novakhov (12 sites) 4h |
| Disease X-19 Publications from Michael_Novakhov (5 sites): Google Alert - coronavirus... |
| The crisis on public transit systems threatens the nation's recovery from the coronavirus pandemic: Restoring... |
 Disease X-19 from Michael_Novakhov (12 sites) 4h Disease X-19 from Michael_Novakhov (12 sites) 4h |
| White House's Jen Psaki offered a binder full of Covid spending details. Taking a... |
| White House's Jen Psaki offered a binder full of Covid spending details. Taking a peek was a process STAT |
 "COVID" - Google News 4h "COVID" - Google News 4h |
| New COVID omicron subvariants will cause surge: OCTA - ABS-CBN News |
| New COVID omicron subvariants will cause surge: OCTA ABS-CBN News |
 "Omicron" - Google News 4h "Omicron" - Google News 4h |
 | What science journalism can't tell us about Covid-19 deaths - STAT |
| What science journalism can't tell us about Covid-19 deaths STAT |
 "COVID-19" - Google News 5h "COVID-19" - Google News 5h |
| Disease X-19 Regions from Michael_Novakhov (8 sites): Google Alert - coronavirus... |
| The World Health Organisation (WHO) says Africa reported more than ... of the first vaccine against malaria,... |
 Disease X-19 from Michael_Novakhov (12 sites) 5h Disease X-19 from Michael_Novakhov (12 sites) 5h |
| Disease X-19 Regions from Michael_Novakhov (8 sites): Google Alert - coronavirus... |
| What is Tim Noakes Keto Extreme South Africa? Tim Noakes Keto Extreme South Africa is a ketogenic supplement... |
 Disease X-19 from Michael_Novakhov (12 sites) 5h Disease X-19 from Michael_Novakhov (12 sites) 5h |
| Disease X-19 Regions from Michael_Novakhov (8 sites): Google Alert - Coronavirus... |
| Earlier this month, a shooting on a subway train in Brooklyn injured 23 ... reluctant to go back to the... |
 Disease X-19 from Michael_Novakhov (12 sites) 5h Disease X-19 from Michael_Novakhov (12 sites) 5h |
| Disease X-19 Regions from Michael_Novakhov (8 sites): Google Alert - Coronavirus... |
| Ontario's Progressive Conservatives are campaigning as if COVID-19 is over ... House fire in Brooklyn... |
 Disease X-19 from Michael_Novakhov (12 sites) 5h Disease X-19 from Michael_Novakhov (12 sites) 5h |
| Disease X-19 Regions from Michael_Novakhov (8 sites): Google Alert - coronavirus... |
| Panic buying has gripped the Chinese capital as local Covid-19 cases rise and residents brace for a Shanghai-style... |
 Disease X-19 from Michael_Novakhov (12 sites) 5h Disease X-19 from Michael_Novakhov (12 sites) 5h |
| Disease X-19 General Issues from Michael_Novakhov (5 sites): Google Alert - Latest... |
| Covid-19 News Live: With 2541 new coronavirus infections being reported in ... who had visited from Delhi... |
 Disease X-19 from Michael_Novakhov (12 sites) 5h Disease X-19 from Michael_Novakhov (12 sites) 5h |
| Disease X-19 Regions from Michael_Novakhov (8 sites): Google Alert - coronavirus... |
| Every year, hundreds of thousands of people, mostly children living in Africa, succumb to malaria, an... |
 Disease X-19 from Michael_Novakhov (12 sites) 5h Disease X-19 from Michael_Novakhov (12 sites) 5h |
| Disease X-19 Regions from Michael_Novakhov (8 sites): Google Alert - coronavirus... |
| Congress returns to face two major funding requests from the Biden administration. Republicans are trying... |
 Disease X-19 from Michael_Novakhov (12 sites) 5h Disease X-19 from Michael_Novakhov (12 sites) 5h |
| Disease X-19 Regions from Michael_Novakhov (8 sites): Google Alert - coronavirus... |
| Qatar on Saturday announced 98 new COVID-19 cases, the Qatar News Agency ... war: Food insecurity triggers... |
 Disease X-19 from Michael_Novakhov (12 sites) 5h Disease X-19 from Michael_Novakhov (12 sites) 5h |
| Disease X-19 Regions from Michael_Novakhov (8 sites): Google Alert - coronavirus... |
| Beijing has kicked off three rounds of COVID-19 testing for all residents of its ... Italy reported 56,263... |
 Disease X-19 from Michael_Novakhov (12 sites) 5h Disease X-19 from Michael_Novakhov (12 sites) 5h |
| Disease X-19 Regions from Michael_Novakhov (8 sites): Google Alert - coronavirus... |
| South Africa. Your Covid-19 questions answered ... The rollout of Covid-19 vaccinations and population... |
 Disease X-19 from Michael_Novakhov (12 sites) 5h Disease X-19 from Michael_Novakhov (12 sites) 5h |
| Shanghai's COVID lockdown drags into 4th week, fears flicker Beijing could be next... |
| Shanghai's COVID lockdown drags into 4th week, fears flicker Beijing could be next Reuters |
 "COVID" - Google News 5h "COVID" - Google News 5h |
| UVA Health experts share insight on timing for COVID-19 booster - WHSV |
| UVA Health experts share insight on timing for COVID-19 booster WHSV |
 "COVID" - Google News 5h "COVID" - Google News 5h |
| New nasal spray to protect people from all Covid variants to start human trials -... |
| New nasal spray to protect people from all Covid variants to start human trials North Wales Live |
 "Omicron and rodents" - Google News 5h "Omicron and rodents" - Google News 5h |
| Severity of omicron variant of concern and effectiveness of vaccine boosters against... |
| Severity of omicron variant of concern and effectiveness of vaccine boosters against symptomatic disease... |
 "Omicron" - Google News 5h "Omicron" - Google News 5h |
| Valneva Provides Regulatory Update on its inactivated COVID-19 Vaccine Candidate... |
| Valneva Provides Regulatory Update on its inactivated COVID-19 Vaccine Candidate – Valneva Valneva |
 "COVID-19" - Google News 5h "COVID-19" - Google News 5h |
 | Some cases of long COVID-19 may be caused by an abnormally suppressed immune system,... |
| Some cases of long COVID-19 may be caused by an abnormally suppressed immune system, research suggests:... |
 "COVID-19" - Google News 5h "COVID-19" - Google News 5h |
| Disease X-19 General Issues from Michael_Novakhov (5 sites): Google Alert - sars... |
| The findings may be relevant to future waves of SARS-CoV-2 or to the behaviour of new variants, according... |
 Disease X-19 from Michael_Novakhov (12 sites) 5h Disease X-19 from Michael_Novakhov (12 sites) 5h |
| Lansing parks got fourth-largest slice of COVID relief funding. How they're spending... |
| Lansing parks got fourth-largest slice of COVID relief funding. How they're spending it. Lansing State... |
 "COVID" - Google News 5h "COVID" - Google News 5h |
| Australia COVID: Omicron mortality rate raises questions over pandemic death measurement... |
| Australia COVID: Omicron mortality rate raises questions over pandemic death measurement Sydney Morning... |
 "Omicron" - Google News 5h "Omicron" - Google News 5h |
 | Impact of population mixing between vaccinated and unvaccinated subpopulations on... |
| submitted by /u/caj_gol [link] [comments] |
 COVID-19 5h COVID-19 5h |
 | Covid-19: Scrap masks for outdoor activities, Hong Kong experts urge; gov't health... |
| Covid-19: Scrap masks for outdoor activities, Hong Kong experts urge; gov't health official advises against Hong... |
 "COVID-19" - Google News 6h "COVID-19" - Google News 6h |
| Disease X-19 and Security from Michael_Novakhov (10 sites): Google Alert - Coronavirus... |
| The US is proving $713million in assistance to war-ravaged Ukraine. ... them for the meeting, for security... |
 Disease X-19 from Michael_Novakhov (12 sites) 6h Disease X-19 from Michael_Novakhov (12 sites) 6h |
| Disease X-19 Epidemiology from Michael_Novakhov (39 sites): Google Alert - Sars-Cov-2... |
| More on this. Beefmaster has beef with Covid-19 restrictions knocking economic growth · 65 farms inspected... |
 Disease X-19 from Michael_Novakhov (12 sites) 6h Disease X-19 from Michael_Novakhov (12 sites) 6h |
| Disease X-19 Epidemiology from Michael_Novakhov (39 sites): Google Alert - Coronavirus... |
| To provide a conducive environment to food delivery aggregators to ... The segment witnessed a significant... |
 Disease X-19 from Michael_Novakhov (12 sites) 6h Disease X-19 from Michael_Novakhov (12 sites) 6h |
| Disease X-19 Epidemiology from Michael_Novakhov (39 sites): Google Alert - Covid-19:... |
| ... Study identifies risk factors for severe COVID-19 in hospitalized ... possible genetic differences... |
 Disease X-19 from Michael_Novakhov (12 sites) 6h Disease X-19 from Michael_Novakhov (12 sites) 6h |
| Disease X-19 Epidemiology from Michael_Novakhov (39 sites): Google Alert - Covid-19:... |
| ... like those that protect against SARS-CoV2 the virus that causes COVID-19. ... MS is caused by a combination... |
 Disease X-19 from Michael_Novakhov (12 sites) 6h Disease X-19 from Michael_Novakhov (12 sites) 6h |
| Disease X-19 Epidemiology from Michael_Novakhov (39 sites): Google Alert - Coronavirus... |
| FIRST ON FOX: Hunter Biden sent an email to his brother's widow, Hallie Biden, pressuring her to get... |
 Disease X-19 from Michael_Novakhov (12 sites) 6h Disease X-19 from Michael_Novakhov (12 sites) 6h |
| Disease X-19 and Security from Michael_Novakhov (10 sites): Google Alert - Coronavirus... |
| Multiple aircraft fly in formation over the USS Ronald Reagan, a U.S. Navy aircraft carrier [Credit:... |
 Disease X-19 from Michael_Novakhov (12 sites) 6h Disease X-19 from Michael_Novakhov (12 sites) 6h |
| Disease X-19 Epidemiology from Michael_Novakhov (39 sites): Google Alert - Coronavirus... |
| Health Secretary Francisco T. Duque III, meanwhile, defined immunocompromised individuals as those diagnosed... |
 Disease X-19 from Michael_Novakhov (12 sites) 6h Disease X-19 from Michael_Novakhov (12 sites) 6h |
| Disease X-19 Epidemiology from Michael_Novakhov (39 sites): Google Alert - coronavirus... |
| Tags: Education, Epidemiology, Hernia, Kidney, Kidney Transplant, ... Evaluating serological responses... |
 Disease X-19 from Michael_Novakhov (12 sites) 6h Disease X-19 from Michael_Novakhov (12 sites) 6h |
| Disease X-19 Epidemiology from Michael_Novakhov (39 sites): Google Alert - coronavirus... |
| "That is what we have seen in the sickest patients," she said. Adrian Esterman, a professor of biostatistics... |
 Disease X-19 from Michael_Novakhov (12 sites) 6h Disease X-19 from Michael_Novakhov (12 sites) 6h |
| Disease X-19 Epidemiology from Michael_Novakhov (39 sites): Google Alert - Coronavirus... |
| Of the 750000 hospitalised, many report fatigue, muscle pain, insomnia and breathlessness, with women... |
 Disease X-19 from Michael_Novakhov (12 sites) 6h Disease X-19 from Michael_Novakhov (12 sites) 6h |
| Disease X-19 and Security from Michael_Novakhov (10 sites): Google Alert - Coronavirus... |
| A Trump-era policy that forces asylum-seekers to wait in Mexico for hearings in U.S. immigration court... |
 Disease X-19 from Michael_Novakhov (12 sites) 6h Disease X-19 from Michael_Novakhov (12 sites) 6h |
| NAACP to hold COVID vigil | News, Sports, Jobs - Martins Ferry Times Leader |
| NAACP to hold COVID vigil | News, Sports, Jobs Martins Ferry Times Leader |
 "COVID" - Google News 6h "COVID" - Google News 6h |
 | Congress returns to big fights over Ukraine aid, Title 42, COVID-19 relief - USA... |
| Congress returns to big fights over Ukraine aid, Title 42, COVID-19 relief USA TODAY |
 "COVID-19" - Google News 6h "COVID-19" - Google News 6h |
| Disease X-19 Regions from Michael_Novakhov (8 sites): Google Alert - Coronavirus... |
| Brooklyn's Democratic-Socialist Senators on State Budget Wins and Losses and What's Next - by Anna Kaufman... |
 Disease X-19 from Michael_Novakhov (12 sites) 6h Disease X-19 from Michael_Novakhov (12 sites) 6h |
| Disease X-19 Regions from Michael_Novakhov (8 sites): Google Alert - Coronavirus... |
| CANARSIE, Brooklyn (WABC) -- FDNY Firefighter Timothy Klein died while battling flames at a fire in Brooklyn... |
 Disease X-19 from Michael_Novakhov (12 sites) 6h Disease X-19 from Michael_Novakhov (12 sites) 6h |
| Disease X-19 and Security from Michael_Novakhov (10 sites): Google Alert - coronavirus... |
| New Delhi: India continues to witness a surge in Coronavirus cases as the ... Somaiya alleges 'Thackeray... |
 Disease X-19 from Michael_Novakhov (12 sites) 6h Disease X-19 from Michael_Novakhov (12 sites) 6h |
| Disease X-19 Regions from Michael_Novakhov (8 sites): Google Alert - Coronavirus... |
| $59 MILLION FOR CLEAN GREEN SCHOOLS INITIATIVE: Governor Kathy Hochul has made available $59 million... |
 Disease X-19 from Michael_Novakhov (12 sites) 6h Disease X-19 from Michael_Novakhov (12 sites) 6h |
| Disease X-19 and Security from Michael_Novakhov (10 sites): Google Alert - Coronavirus... |
| ... April 25 — the date in 1915 when the Australia and New Zealand Army Corps landed ... Mask mandates... |
 Disease X-19 from Michael_Novakhov (12 sites) 6h Disease X-19 from Michael_Novakhov (12 sites) 6h |
| Disease X-19 Regions from Michael_Novakhov (8 sites): Google Alert - Coronavirus... |
| Health officials say 2,344 patients are hospitalized due to COVID-19, ... House fire in Brooklyn leaves... |
 Disease X-19 from Michael_Novakhov (12 sites) 6h Disease X-19 from Michael_Novakhov (12 sites) 6h |
| Disease X-19 and Security from Michael_Novakhov (10 sites): Google Alert - Coronavirus... |
| The United States announced new military assistance for Ukraine and a renewed diplomatic push in the... |
 Disease X-19 from Michael_Novakhov (12 sites) 6h Disease X-19 from Michael_Novakhov (12 sites) 6h |
| Disease X-19 and Security from Michael_Novakhov (10 sites): Google Alert - coronavirus... |
| CANBERRA, Australia (AP) — Large crowds gathered in Australia on Monday to pay tribute to their war dead... |
 Disease X-19 from Michael_Novakhov (12 sites) 6h Disease X-19 from Michael_Novakhov (12 sites) 6h |
| Disease X-19 Publications from Michael_Novakhov (5 sites): Google Alert - coronavirus... |
| 3 House Republican Elise Stefanik of New York, tried to move the ... former intelligence officials released... |
 Disease X-19 from Michael_Novakhov (12 sites) 6h Disease X-19 from Michael_Novakhov (12 sites) 6h |
| China Lockdown Angst Rips Through Markets as Stocks, Yuan Plunge - Bloomberg |
| China Lockdown Angst Rips Through Markets as Stocks, Yuan Plunge Bloomberg |
 "coronavirus news" - Google News 6h "coronavirus news" - Google News 6h |
 | Researchers hunt for improvements in COVID-19 vaccines - Portland Press Herald -... |
| Researchers hunt for improvements in COVID-19 vaccines - Portland Press Herald Press Herald |
 "COVID-19" - Google News 7h "COVID-19" - Google News 7h |
| Disease X-19 Epidemiology from Michael_Novakhov (39 sites): Google Alert - coronavirus... |
| Beijing residents undergo testing for Covid-19 at a swab collection site on ... reports of uncounted... |
 Disease X-19 from Michael_Novakhov (12 sites) 7h Disease X-19 from Michael_Novakhov (12 sites) 7h |
| Disease X-19 Epidemiology from Michael_Novakhov (39 sites): Google Alert - covid-19... |
| Food Processing Equipment Market Size, Share & COVID-19 Impact Analysis, ... By Application (Bakery... |
 Disease X-19 from Michael_Novakhov (12 sites) 7h Disease X-19 from Michael_Novakhov (12 sites) 7h |
| Disease X-19 Epidemiology from Michael_Novakhov (39 sites): Google Alert - Coronavirus... |
| ... COVID-19, so we want to honor the people who have passed with a candlelight vigil and also we want... |
 Disease X-19 from Michael_Novakhov (12 sites) 7h Disease X-19 from Michael_Novakhov (12 sites) 7h |
| Disease X-19 Epidemiology from Michael_Novakhov (39 sites): Google Alert - coronavirus... |
| A popular at-home program has ended, but saliva tests are still widely used. Google Alert - coronavirus... |
 Disease X-19 from Michael_Novakhov (12 sites) 7h Disease X-19 from Michael_Novakhov (12 sites) 7h |
| Disease X-19 Epidemiology from Michael_Novakhov (39 sites): Google Alert - coronavirus... |
| Fewer people died from COVID-19 in March than in the previous months of 2022, ... data by the Australian... |
 Disease X-19 from Michael_Novakhov (12 sites) 7h Disease X-19 from Michael_Novakhov (12 sites) 7h |
| Disease X-19 Epidemiology from Michael_Novakhov (39 sites): Google Alert - Sars Cov-2... |
| Covid-19 took in its grip not only humans, but also pets like dogs and milch animals like cows and buffaloes,... |
 Disease X-19 from Michael_Novakhov (12 sites) 7h Disease X-19 from Michael_Novakhov (12 sites) 7h |
| Disease X-19 Epidemiology from Michael_Novakhov (39 sites): Google Alert - Sars Cov-2... |
| Connecticut schools should brace for an increase in COVID-19 cases, the state Department · State warns... |
 Disease X-19 from Michael_Novakhov (12 sites) 7h Disease X-19 from Michael_Novakhov (12 sites) 7h |
| Disease X-19 Epidemiology from Michael_Novakhov (39 sites): Google Alert - Sars Cov-2... |
| Janelle Berry, left, and Aileen Morales perform a COVID-19 test at Broadview · No plans for new mandates... |
 Disease X-19 from Michael_Novakhov (12 sites) 7h Disease X-19 from Michael_Novakhov (12 sites) 7h |
| Disease X-19 Epidemiology from Michael_Novakhov (39 sites): Google Alert - covid-19... |
| Plenty of experiments have been conducted to see whether plants can ... Keep up to date with the latest... |
 Disease X-19 from Michael_Novakhov (12 sites) 7h Disease X-19 from Michael_Novakhov (12 sites) 7h |
| Disease X-19 Epidemiology from Michael_Novakhov (39 sites): Google Alert - Sars Cov-2... |
| It was the latest killing of endangered animals on Sumatra island. Conservationists say the coronavirus... |
 Disease X-19 from Michael_Novakhov (12 sites) 7h Disease X-19 from Michael_Novakhov (12 sites) 7h |
| COVID shots still work, but researchers seek improvements - Williamsport Sun-Gazette |
| COVID shots still work, but researchers seek improvements Williamsport Sun-Gazette |
 "COVID" - Google News 7h "COVID" - Google News 7h |
| COVID Cases Still Rising, Bernards Health Official Urges Continued Mask Wearing While... |
| COVID Cases Still Rising, Bernards Health Official Urges Continued Mask Wearing While Traveling and In... |
 "COVID" - Google News 7h "COVID" - Google News 7h |
| Coronavirus daily news updates, April 8: What to know today about COVID-19 in the... |
| Coronavirus daily news updates, April 8: What to know today about COVID-19 in the Seattle area, Washington... |
 "COVID" - Google News 7h "COVID" - Google News 7h |
 | Several New Studies Presented at ECCMIC 2022 Confirm Veklury® (Remdesivir) Activity... |
| Several New Studies Presented at ECCMIC 2022 Confirm Veklury® (Remdesivir) Activity in Treating COVID-19 Gilead... |
 "Covid-19" - Google News 7h "Covid-19" - Google News 7h |
| (3rd LD) New infections below 100000 for 4th day as omicron slows - Yonhap News Agency |
| (3rd LD) New infections below 100000 for 4th day as omicron slows Yonhap News Agency |
 "Omicron" - Google News 7h "Omicron" - Google News 7h |
| Disease X-19 General Issues from Michael_Novakhov (5 sites): Google Alert - sars... |
| ... of which two on the SeptiCyte RAPID (developed in collaboration with Immunexpress) and one on the... |
 Disease X-19 from Michael_Novakhov (12 sites) 7h Disease X-19 from Michael_Novakhov (12 sites) 7h |
| Disease X-19 General Issues from Michael_Novakhov (5 sites): Google Alert - sars... |
| Colorized scanning electron micrograph of an apoptotic cell (purple) infected with SARS-COV-2 virus particles... |
 Disease X-19 from Michael_Novakhov (12 sites) 7h Disease X-19 from Michael_Novakhov (12 sites) 7h |
| Disease X-19 General Issues from Michael_Novakhov (5 sites): Google Alert - Covid-19:... |
| CHICAGO (CBS) -- There is growing concern about a rise in COVID-19 cases across the nation and in Illinois.... |
 Disease X-19 from Michael_Novakhov (12 sites) 7h Disease X-19 from Michael_Novakhov (12 sites) 7h |
| Disease X-19 General Issues from Michael_Novakhov (5 sites): Google Alert - Covid-19:... |
| MAHOMET, Ill. (WCIA) – As many people feel like things are getting back to normal, others are dealing... |
 Disease X-19 from Michael_Novakhov (12 sites) 7h Disease X-19 from Michael_Novakhov (12 sites) 7h |
| EMEA Morning Briefing: Fed, China Covid Fears to Hit Shares Again - Morningstar |
| EMEA Morning Briefing: Fed, China Covid Fears to Hit Shares Again Morningstar |
 "COVID" - Google News 7h "COVID" - Google News 7h |
| Experts say U.S. suspension of international COVID aid will prolong pandemic - PBS... |
| Experts say U.S. suspension of international COVID aid will prolong pandemic PBS NewsHour |
 "COVID" - Google News 7h "COVID" - Google News 7h |
| 13 Virginia localities rank as medium, updated CDC COVID Community Levels map shows... |
| 13 Virginia localities rank as medium, updated CDC COVID Community Levels map shows CBS 6 News Richmond... |
 "coronavirus news" - Google News 7h "coronavirus news" - Google News 7h |
| Israel lifts indoor mask mandate as coronavirus cases drop - FOX 31 Denver |
| Israel lifts indoor mask mandate as coronavirus cases drop FOX 31 Denver |
 "coronavirus news" - Google News 7h "coronavirus news" - Google News 7h |
| Spike in COVID cases could be a flare-up of Omicron subvariant - Health Dept - 702 |
| Spike in COVID cases could be a flare-up of Omicron subvariant - Health Dept 702 |
 "Omicron" - Google News 7h "Omicron" - Google News 7h |
| 12 new Omicron community cases in Cambodia - The Phnom Penh Post |
| 12 new Omicron community cases in Cambodia The Phnom Penh Post |
 "Omicron" - Google News 7h "Omicron" - Google News 7h |
| Batter and Breader Premixes Market Share, Size, Opportunity, Demand and Forecast... |
| Batter and Breader Premixes Market Share, Size, Opportunity, Demand and Forecast 2027 Digital Journal |
 "Coronavirus in fish and seafood" - Google News 7h "Coronavirus in fish and seafood" - Google News 7h |
| Disease X-19 Regions from Michael_Novakhov (8 sites): Google Alert - coronavirus... |
| Read more about Global Covid caseload tops 509.4 million, ... Russia (17,872,625), South Korea (16,929,564),... |
 Disease X-19 from Michael_Novakhov (12 sites) 8h Disease X-19 from Michael_Novakhov (12 sites) 8h |
| Disease X-19 Regions from Michael_Novakhov (8 sites): Google Alert - coronavirus... |
| ... tension between employees and employers and COVID-19 panic only just ... That made her the fourth... |
 Disease X-19 from Michael_Novakhov (12 sites) 8h Disease X-19 from Michael_Novakhov (12 sites) 8h |
| Disease X-19 Regions from Michael_Novakhov (8 sites): Google Alert - coronavirus... |
| ... Napoli's Mario Rui during the Serie A soccer match between Empoli and Napoli at Castellani Stadium,... |
 Disease X-19 from Michael_Novakhov (12 sites) 8h Disease X-19 from Michael_Novakhov (12 sites) 8h |
| Disease X-19 Regions from Michael_Novakhov (8 sites): Google Alert - coronavirus... |
| The global Covid caseload has topped 509.4 million, while the deaths have ... Russia (17,872,625), South... |
 Disease X-19 from Michael_Novakhov (12 sites) 8h Disease X-19 from Michael_Novakhov (12 sites) 8h |
| Disease X-19 Regions from Michael_Novakhov (8 sites): Google Alert - coronavirus... |
| Canada declared war on Italy in 1940. The report says an apology should be made during Italian Heritage... |
 Disease X-19 from Michael_Novakhov (12 sites) 8h Disease X-19 from Michael_Novakhov (12 sites) 8h |
| Disease X-19 Regions from Michael_Novakhov (8 sites): Google Alert - coronavirus... |
| According to the health ministry, Italy reported 56263 new COVID-19-related cases on Sunday, down from... |
 Disease X-19 from Michael_Novakhov (12 sites) 8h Disease X-19 from Michael_Novakhov (12 sites) 8h |
| Disease X-19 Regions from Michael_Novakhov (8 sites): Google Alert - coronavirus... |
| But the city reported its first deaths as a result of the new outbreak on Monday, after three people... |
 Disease X-19 from Michael_Novakhov (12 sites) 8h Disease X-19 from Michael_Novakhov (12 sites) 8h |
| Australia commemorates war dead with few COVID restrictions - NEWS10 ABC |
| Australia commemorates war dead with few COVID restrictions NEWS10 ABC |
 "COVID" - Google News 8h "COVID" - Google News 8h |
| Couple caught in COVID outbreak on cruise ship - NewsNation Now |
| Couple caught in COVID outbreak on cruise ship NewsNation Now |
 "COVID" - Google News 8h "COVID" - Google News 8h |
| Agriculture Equipment Market Worth USD 253.28 Billion by 2028 | Agriculture Equipment... |
| Agriculture Equipment Market Worth USD 253.28 Billion by 2028 | Agriculture Equipment Industry Exhibiting... |
 "Coronavirus in meat plants" - Google News 8h "Coronavirus in meat plants" - Google News 8h |
 | Thio '22: Moving on from COVID-19 shouldn't mean doing nothing - The Brown Daily... |
| Thio '22: Moving on from COVID-19 shouldn't mean doing nothing The Brown Daily Herald |
 "COVID-19" - Google News 8h "COVID-19" - Google News 8h |
| Disease X-19 and Security from Michael_Novakhov (10 sites): Google Alert - coronavirus... |
| The 30 new fatalities include 24 from Kerala, two each from Maharashtra and Uttar Pradesh and one each... |
 Disease X-19 from Michael_Novakhov (12 sites) 8h Disease X-19 from Michael_Novakhov (12 sites) 8h |
| Disease X-19 and Security from Michael_Novakhov (10 sites): Google Alert - coronavirus... |
| What the Police Commissioner is doing? How are so many mafia Sena goondas allowed to gather in the police... |
 Disease X-19 from Michael_Novakhov (12 sites) 8h Disease X-19 from Michael_Novakhov (12 sites) 8h |
| Disease X-19 and Security from Michael_Novakhov (10 sites): Google Alert - coronavirus... |
| What's behind the latest political hit in Jacob Zuma's mafia province? Maverick Life. Signs that you... |
 Disease X-19 from Michael_Novakhov (12 sites) 8h Disease X-19 from Michael_Novakhov (12 sites) 8h |
| Disease X-19 General Issues from Michael_Novakhov (5 sites): Google Alert - Latest... |
| New Delhi: India's steady uptick in new Covid-19 cases continued on Sunday as well as several states... |
 Disease X-19 from Michael_Novakhov (12 sites) 8h Disease X-19 from Michael_Novakhov (12 sites) 8h |
| Disease X-19 General Issues from Michael_Novakhov (5 sites): Google Alert - Latest... |
| News · Consumer Watch · Crime and Courts · Tornado Recovery · Coronavirus · This is Our Shot · Local... |
 Disease X-19 from Michael_Novakhov (12 sites) 8h Disease X-19 from Michael_Novakhov (12 sites) 8h |
| Disease X-19 General Issues from Michael_Novakhov (5 sites): Google Alert - coronavirus:... |
| A subsidiary of Apple supplier Foxconn Technology Group has closed two factories outside of Shanghai... |
 Disease X-19 from Michael_Novakhov (12 sites) 8h Disease X-19 from Michael_Novakhov (12 sites) 8h |
| Disease X-19 General Issues from Michael_Novakhov (5 sites): Google Alert - coronavirus:... |
| All New Yorkers age 5 or older are now eligible to receive the COVID-19 vaccine. Appointments are available... |
 Disease X-19 from Michael_Novakhov (12 sites) 8h Disease X-19 from Michael_Novakhov (12 sites) 8h |
| Coronavirus News Live Updates: India reports 2,541 fresh Covid-19 cases, slightly... |
| Coronavirus News Live Updates: India reports 2,541 fresh Covid-19 cases, slightly lower than yesterday;... |
 "coronavirus news" - Google News 8h "coronavirus news" - Google News 8h |
| Cross-reactive coronavirus antibodies might not be cross-neutralizing - News-Medical.Net |
| Cross-reactive coronavirus antibodies might not be cross-neutralizing News-Medical.Net |
 "coronavirus news" - Google News 8h "coronavirus news" - Google News 8h |
 | Prior COVID-19 protects against subsequent infections - News-Medical.Net |
| Prior COVID-19 protects against subsequent infections News-Medical.Net |
 "Covid-19" - Google News 8h "Covid-19" - Google News 8h |
| Why was the Omicron variant less severe than other Covid-19 strains? - TimesLIVE |
| Why was the Omicron variant less severe than other Covid-19 strains? TimesLIVE |
 "Omicron" - Google News 8h "Omicron" - Google News 8h |
| Hunter Biden is prime target if Republicans win Congress - The Washington Post |
| Hunter Biden is prime target if Republicans win Congress The Washington Post |
 "covid -19 origins" - Google News 9h "covid -19 origins" - Google News 9h |
 | BCG vaccination of Diversity Outbred mice induces cross-reactive antibodies to SARS-CoV-2... |
| submitted by /u/SigmaEuler [link] [comments] |
 COVID-19 9h COVID-19 9h |
 | Histamine Potentiates SARS-CoV-2 Spike Protein Entry Into Endothelial Cells |
| submitted by /u/JaneSteinberg [link] [comments] |
 COVID-19 9h COVID-19 9h |
 | Shanghai adds 51 new Covid-19 deaths amid rise in symptomatic cases - South China... |
| Shanghai adds 51 new Covid-19 deaths amid rise in symptomatic cases South China Morning Post |
 "COVID-19" - Google News 9h "COVID-19" - Google News 9h |
| Disease X-19 Epidemiology from Michael_Novakhov (39 sites): Google Alert - coronavirus... |
| Dodgers pitcher David Price was put on the injured list Sunday after testing positive for COVID-19. ... |
 Disease X-19 from Michael_Novakhov (12 sites) 9h Disease X-19 from Michael_Novakhov (12 sites) 9h |
| Disease X-19 Epidemiology from Michael_Novakhov (39 sites): Google Alert - Coronavirus... |
| As the COVID pandemic stressed our hospital systems in 2020, personal care assistants — who are among... |
 Disease X-19 from Michael_Novakhov (12 sites) 9h Disease X-19 from Michael_Novakhov (12 sites) 9h |
| Disease X-19 Epidemiology from Michael_Novakhov (39 sites): Google Alert - Coronavirus... |
| Healthcare worker Azucena Estrada collects nasal swab samples at a drive-thru Covid-19 testing site in... |
 Disease X-19 from Michael_Novakhov (12 sites) 9h Disease X-19 from Michael_Novakhov (12 sites) 9h |
| Disease X-19 Epidemiology from Michael_Novakhov (39 sites): Google Alert - Coronavirus... |
| The capital reported 22 new local cases on Saturday, national health authorities said Sunday morning.... |
 Disease X-19 from Michael_Novakhov (12 sites) 9h Disease X-19 from Michael_Novakhov (12 sites) 9h |
| Disease X-19 Epidemiology from Michael_Novakhov (39 sites): Google Alert - coronavirus... |
| India's daily coronavirus count has been climbing over the past few days, primarily due to the surge... |
 Disease X-19 from Michael_Novakhov (12 sites) 9h Disease X-19 from Michael_Novakhov (12 sites) 9h |
| Australia commemorates war dead with few COVID restrictions - The Seattle Times |
| Australia commemorates war dead with few COVID restrictions The Seattle Times |
 "COVID" - Google News 9h "COVID" - Google News 9h |
| Opinion | Covid on TV, in Movies and in Books: What Will the 'Covid Plot' Be? - The... |
| Opinion | Covid on TV, in Movies and in Books: What Will the 'Covid Plot' Be? The New York Times |
 "COVID" - Google News 9h "COVID" - Google News 9h |
| China's capital city warns of more Covid cases and begins mass testing in the central... |
| China's capital city warns of more Covid cases and begins mass testing in the central business district CNBC |
 "coronavirus news" - Google News 9h "coronavirus news" - Google News 9h |
| Sussex County COVID-19 April 24, 2022 | Sparta, NJ News TAPinto - TAPinto.net |
| Sussex County COVID-19 April 24, 2022 | Sparta, NJ News TAPinto TAPinto.net |
 "coronavirus news" - Google News 9h "coronavirus news" - Google News 9h |
| Shanghai erects metal barriers in fight against COVID-19 - Cumberland Times-News |
| Shanghai erects metal barriers in fight against COVID-19 Cumberland Times-News |
 "coronavirus news" - Google News 9h "coronavirus news" - Google News 9h |
| No patients in Beloit hospital's COVID unit | Covid-19 | beloitdailynews.com - Beloit... |
| No patients in Beloit hospital's COVID unit | Covid-19 | beloitdailynews.com Beloit Daily News |
 "Covid-19" - Google News 9h "Covid-19" - Google News 9h |
| ANA parent forecasts steeper loss on Omicron, fuel impact - Flightglobal |
| ANA parent forecasts steeper loss on Omicron, fuel impact Flightglobal |
 "Omicron" - Google News 9h "Omicron" - Google News 9h |
 | The Role of COVID-19 Vaccinal Status in Admitted Children during OMICRON Variant... |
| submitted by /u/JaneSteinberg [link] [comments] |
 COVID-19 9h COVID-19 9h |
 | Right Ventricular Abnormality in Patients Hospitalized With COVID-19 Infection During... |
| submitted by /u/JaneSteinberg [link] [comments] |
 COVID-19 9h COVID-19 9h |
 | This Week in COVID-19: Tufts reaches highest number of recorded cases in a day, students... |
| This Week in COVID-19: Tufts reaches highest number of recorded cases in a day, students isolate in dorms Tufts... |
 "COVID-19" - Google News 9h "COVID-19" - Google News 9h |
| China Covid Shock Sees Beijing Consider Risky Debt Option Again - Bloomberg |
| China Covid Shock Sees Beijing Consider Risky Debt Option Again Bloomberg |
 "COVID" - Google News 9h "COVID" - Google News 9h |
| What is East Lansing doing with over $12 million in federal COVID-19 funds? - Lansing... |
| What is East Lansing doing with over $12 million in federal COVID-19 funds? Lansing State Journal |
 "COVID" - Google News 9h "COVID" - Google News 9h |
| Australia commemorates war dead with few COVID restrictions - The Washington Post |
| Australia commemorates war dead with few COVID restrictions The Washington Post |
 "COVID" - Google News 9h "COVID" - Google News 9h |
| Boston-area COVID wastewater data starts dropping: 'I'm cautiously optimistic' -... |
| Boston-area COVID wastewater data starts dropping: 'I'm cautiously optimistic' Boston Herald |
 "COVID" - Google News 9h "COVID" - Google News 9h |
| Disease X-19 Regions from Michael_Novakhov (8 sites): Google Alert - Coronavirus... |
| Klein and a civilian died today in a Brooklyn house fire, in New York, ... Click here to see our full... |
 Disease X-19 from Michael_Novakhov (12 sites) 9h Disease X-19 from Michael_Novakhov (12 sites) 9h |
| Disease X-19 Publications from Michael_Novakhov (5 sites): Google Alert - coronavirus... |
| It appears police forces around Western New York have more than a few bad apples. Charlie Specht of The... |
 Disease X-19 from Michael_Novakhov (12 sites) 9h Disease X-19 from Michael_Novakhov (12 sites) 9h |
| Disease X-19 Regions from Michael_Novakhov (8 sites): Google Alert - Coronavirus... |
| apple - Brooklyn, Florida. Apr 25, 2022 ... 396 Ave Z Brooklyn NewYork USA 11223. Brooklyn, Florida 11223.... |
 Disease X-19 from Michael_Novakhov (12 sites) 9h Disease X-19 from Michael_Novakhov (12 sites) 9h |
| Disease X-19 Regions from Michael_Novakhov (8 sites): Google Alert - Coronavirus... |
| A New York firefighter died Sunday responding to a house fire in Brooklyn where a ceiling collapsed,... |
 Disease X-19 from Michael_Novakhov (12 sites) 9h Disease X-19 from Michael_Novakhov (12 sites) 9h |
| Disease X-19 Regions from Michael_Novakhov (8 sites): Google Alert - coronavirus... |
| ... Cook Islands reported its first coronavirus-related death on Sunday, ... Tehran: Iran's Revolutionary... |
 Disease X-19 from Michael_Novakhov (12 sites) 9h Disease X-19 from Michael_Novakhov (12 sites) 9h |
| Disease X-19 Publications from Michael_Novakhov (5 sites): Google Alert - new york... |
| A prominent Maryland doctor overseeing coronavirus testing at ... Sign up for The Morning newsletter... |
 Disease X-19 from Michael_Novakhov (12 sites) 9h Disease X-19 from Michael_Novakhov (12 sites) 9h |
| Disease X-19 Publications from Michael_Novakhov (5 sites): Google Alert - coronavirus... |
| At an August ribbon-cutting for the new clini. ... Sign up for The Morning newsletter from the New York... |
 Disease X-19 from Michael_Novakhov (12 sites) 9h Disease X-19 from Michael_Novakhov (12 sites) 9h |
| Disease X-19 Publications from Michael_Novakhov (5 sites): Google Alert - Coronavirus... |
| Ron Elfenbein, 47, has been a frequent guest on local and national television news during broadcasts... |
 Disease X-19 from Michael_Novakhov (12 sites) 9h Disease X-19 from Michael_Novakhov (12 sites) 9h |
| Disease X-19 Publications from Michael_Novakhov (5 sites): Google Alert - coronavirus... |
| "This Will Not Pass: Trump, Biden, and the Battle for America's Future" by Jonathan Martin and Alexander... |
 Disease X-19 from Michael_Novakhov (12 sites) 9h Disease X-19 from Michael_Novakhov (12 sites) 9h |
| Monoclonal-antibody combination AZD7442 prevents COVID-19 - News-Medical.Net |
| Monoclonal-antibody combination AZD7442 prevents COVID-19 News-Medical.Net |
 "coronavirus news" - Google News 9h "coronavirus news" - Google News 9h |
| Elderly continue to be hardest hit by coronavirus - The Sun Chronicle |
| Elderly continue to be hardest hit by coronavirus The Sun Chronicle |
 "coronavirus news" - Google News 9h "coronavirus news" - Google News 9h |
 | Northwestern COVID-19 positivity rate declines, still one of the highest reported... |
| Northwestern COVID-19 positivity rate declines, still one of the highest reported since beginning of... |
 "Covid-19" - Google News 9h "Covid-19" - Google News 9h |
 | WHO backs Paxlovid for milder COVID-19 cases; users tell of odd rebound symptoms... |
| WHO backs Paxlovid for milder COVID-19 cases; users tell of odd rebound symptoms - McKnight's Long Term... |
 "Covid-19" - Google News 9h "Covid-19" - Google News 9h |
| COVID-19 Two Year Review | Campus Life | crimson.fit.edu - Crimson |
| COVID-19 Two Year Review | Campus Life | crimson.fit.edu Crimson |
 "COVID-19" - Google News 10h "COVID-19" - Google News 10h |
| Disease X-19 Epidemiology from Michael_Novakhov (39 sites): Google Alert - coronavirus... |
| Oil pushed lower at the start of the week on concerns that a spreading Covid-19 outbreak in China will... |
 Disease X-19 from Michael_Novakhov (12 sites) 10h Disease X-19 from Michael_Novakhov (12 sites) 10h |
| Disease X-19 Epidemiology from Michael_Novakhov (39 sites): Google Alert - coronavirus... |
| Lee credited Singapore's resilient healthcare system, an effective public health response and a high... |
 Disease X-19 from Michael_Novakhov (12 sites) 10h Disease X-19 from Michael_Novakhov (12 sites) 10h |
| Disease X-19 Epidemiology from Michael_Novakhov (39 sites): Google Alert - coronavirus... |
| A new study describes a novel COVID-19 detection technique based on T-cell ... SARS-CoV-2 initiates both... |
 Disease X-19 from Michael_Novakhov (12 sites) 10h Disease X-19 from Michael_Novakhov (12 sites) 10h |
| Disease X-19 Epidemiology from Michael_Novakhov (39 sites): Google Alert - covid-19... |
| Lee credited Singapore's resilient healthcare system, an effective public health response and a high... |
 Disease X-19 from Michael_Novakhov (12 sites) 10h Disease X-19 from Michael_Novakhov (12 sites) 10h |
| Disease X-19 Epidemiology from Michael_Novakhov (39 sites): Google Alert - covid-19... |
| Latest data released by National Health Commission by midnight, April 24, 2022. - Chinese mainland reports... |
 Disease X-19 from Michael_Novakhov (12 sites) 10h Disease X-19 from Michael_Novakhov (12 sites) 10h |
| Disease X-19 and Security from Michael_Novakhov (10 sites): Google Alert - Coronavirus... |
| The drugmaker said in March it would launch a global Phase III trial worldwide for the drug with U.S.... |
 Disease X-19 from Michael_Novakhov (12 sites) 10h Disease X-19 from Michael_Novakhov (12 sites) 10h |
| Disease X-19 Epidemiology from Michael_Novakhov (39 sites): Google Alert - Coronavirus... |
| Operations halted at factories in eastern China's Kunshan after COVID-19 cases reported, report says.... |
 Disease X-19 from Michael_Novakhov (12 sites) 10h Disease X-19 from Michael_Novakhov (12 sites) 10h |
| Disease X-19 Epidemiology from Michael_Novakhov (39 sites): Google Alert - Covid-19:... |
| 3billion provides rare disease diagnosis services through genetic testing. Keum Chang-won, who majored... |
 Disease X-19 from Michael_Novakhov (12 sites) 10h Disease X-19 from Michael_Novakhov (12 sites) 10h |
| Disease X-19 Epidemiology from Michael_Novakhov (39 sites): Google Alert - Covid-19:... |
| RNA was extracted from stool samples and assayed for four target genes in the SARS-CoV-2 genomic RNA... |
 Disease X-19 from Michael_Novakhov (12 sites) 10h Disease X-19 from Michael_Novakhov (12 sites) 10h |
| Disease X-19 Epidemiology from Michael_Novakhov (39 sites): Google Alert - Covid-19:... |
| RNA was extracted from stool samples and assayed for four target genes in the SARS-CoV-2 genomic RNA... |
 Disease X-19 from Michael_Novakhov (12 sites) 10h Disease X-19 from Michael_Novakhov (12 sites) 10h |
| Disease X-19 and Security from Michael_Novakhov (10 sites): Google Alert - Coronavirus... |
| Australia and New Zealand commemorate Anzac Day every April 25 — the date in 1915 when the Australia... |
 Disease X-19 from Michael_Novakhov (12 sites) 10h Disease X-19 from Michael_Novakhov (12 sites) 10h |
| Disease X-19 and Security from Michael_Novakhov (10 sites): Google Alert - Coronavirus... |
| Europe News: Despite the economic fallout of the global Covid pandemic, ... Over the past decade, US... |
 Disease X-19 from Michael_Novakhov (12 sites) 10h Disease X-19 from Michael_Novakhov (12 sites) 10h |
| Disease X-19 and Security from Michael_Novakhov (10 sites): Google Alert - Coronavirus... |
| The U.S. remains by far the biggest spender, with $801 billion allocated to the armed forces in 2021,... |
 Disease X-19 from Michael_Novakhov (12 sites) 10h Disease X-19 from Michael_Novakhov (12 sites) 10h |
| Disease X-19 and Security from Michael_Novakhov (10 sites): Google Alert - Coronavirus... |
| As America approaches a million deaths from COVID-19, many thousands of families ... Arnold had just... |
 Disease X-19 from Michael_Novakhov (12 sites) 10h Disease X-19 from Michael_Novakhov (12 sites) 10h |
| Disease X-19 and Security from Michael_Novakhov (10 sites): Google Alert - Coronavirus... |
| China's demonstration comes after a US Navy carrier strike group conducted routine drills off of the... |
 Disease X-19 from Michael_Novakhov (12 sites) 10h Disease X-19 from Michael_Novakhov (12 sites) 10h |
| Disease X-19 and Security from Michael_Novakhov (10 sites): Google Alert - Coronavirus... |
| COVID-19 vaccines still offer strong protection against severe illness and ... an adviser to the U.S.... |
 Disease X-19 from Michael_Novakhov (12 sites) 10h Disease X-19 from Michael_Novakhov (12 sites) 10h |
| Coronavirus News LIVE Updates: India Reports 2,541 New Covid Infections; K'taka to... |
| Coronavirus News LIVE Updates: India Reports 2,541 New Covid Infections; K'taka to Issue Fresh Guidelines... |
 "coronavirus news" - Google News 10h "coronavirus news" - Google News 10h |
| Maryland doctor charged with defrauding Medicare, other insurers by $1.5 million... |
| Maryland doctor charged with defrauding Medicare, other insurers by $1.5 million The Washington Post |
 "coronavirus news" - Google News 10h "coronavirus news" - Google News 10h |
| Covid-19 still a leading cause of death; families grapple with loss - wcia.com |
| Covid-19 still a leading cause of death; families grapple with loss wcia.com |
 "Covid-19" - Google News 10h "Covid-19" - Google News 10h |
| Oil Sinks Below $100 as China's Lockdowns Imperil Demand Outlook - Bloomberg |
| Oil Sinks Below $100 as China's Lockdowns Imperil Demand Outlook Bloomberg |
 "COVID" - Google News 10h "COVID" - Google News 10h |
| Disease X-19 Regions from Michael_Novakhov (8 sites): Google Alert - coronavirus... |
| Many wells were abandoned over the last century and are difficult to find and properly plug. VESTAL,... |
 Disease X-19 from Michael_Novakhov (12 sites) 10h Disease X-19 from Michael_Novakhov (12 sites) 10h |
| Disease X-19 and Security from Michael_Novakhov (10 sites): Google Alert - coronavirus... |
| ... the prosecution's investigative powers, his spokesperson said. ... investigate right to two crime... |
 Disease X-19 from Michael_Novakhov (12 sites) 10h Disease X-19 from Michael_Novakhov (12 sites) 10h |
| Disease X-19 Regions from Michael_Novakhov (8 sites): Google Alert - coronavirus... |
| Apple Inc's prime supplier Foxconn Technology Group halted operations at two of its factories in eastern... |
 Disease X-19 from Michael_Novakhov (12 sites) 10h Disease X-19 from Michael_Novakhov (12 sites) 10h |
| Disease X-19 Epidemiology from Michael_Novakhov (39 sites): Google Alert - coronavirus... |
| Operations halted at factories in eastern China's Kunshan after COVID-19 cases reported, report says.... |
 Disease X-19 from Michael_Novakhov (12 sites) 10h Disease X-19 from Michael_Novakhov (12 sites) 10h |
| Disease X-19 Epidemiology from Michael_Novakhov (39 sites): Google Alert - Sars-Cov-2... |
| Cows killed in Sydney cattle truck crash · Aussies urged: be COVID-safe on Anzac Day · Australians are... |
 Disease X-19 from Michael_Novakhov (12 sites) 10h Disease X-19 from Michael_Novakhov (12 sites) 10h |
| Disease X-19 Epidemiology from Michael_Novakhov (39 sites): Google Alert - Sars-Cov-2... |
| Several cows have died after a cattle truck overturned in Sydney's west. ... Aussies urged: be COVID-safe... |
 Disease X-19 from Michael_Novakhov (12 sites) 10h Disease X-19 from Michael_Novakhov (12 sites) 10h |
| Disease X-19 Epidemiology from Michael_Novakhov (39 sites): Google Alert - coronavirus... |
| LA County residents are once again reaching for their masks following a new local COVID-19 health order... |
 Disease X-19 from Michael_Novakhov (12 sites) 10h Disease X-19 from Michael_Novakhov (12 sites) 10h |
| Disease X-19 Epidemiology from Michael_Novakhov (39 sites): Google Alert - coronavirus... |
| 'It is with great sadness that I announce that we have just recorded our first in-country death attributed... |
 Disease X-19 from Michael_Novakhov (12 sites) 10h Disease X-19 from Michael_Novakhov (12 sites) 10h |
| Disease X-19 Epidemiology from Michael_Novakhov (39 sites): Google Alert - coronavirus... |
| Green fences used in Shanghai COVID-19 lockdown ... the people inside, using metal barriers to enclose... |
 Disease X-19 from Michael_Novakhov (12 sites) 10h Disease X-19 from Michael_Novakhov (12 sites) 10h |
| Disease X-19 Epidemiology from Michael_Novakhov (39 sites): Google Alert - Sars-Cov-2... |
| A cattle truck has overturned in western Sydney, killing several cows and leaving the driver ... Aussies... |
 Disease X-19 from Michael_Novakhov (12 sites) 10h Disease X-19 from Michael_Novakhov (12 sites) 10h |
| Disease X-19 Epidemiology from Michael_Novakhov (39 sites): Google Alert - coronavirus... |
| If you're wondering when to get that next COVID-19 shot you are not alone. Google Alert - coronavirus... |
 Disease X-19 from Michael_Novakhov (12 sites) 10h Disease X-19 from Michael_Novakhov (12 sites) 10h |
| Disease X-19 Epidemiology from Michael_Novakhov (39 sites): Google Alert - Sars-Cov-2... |
| Several cows have died after a cattle truck overturned in Sydney's west. ... COVID cases falling, but... |
 Disease X-19 from Michael_Novakhov (12 sites) 10h Disease X-19 from Michael_Novakhov (12 sites) 10h |
| Disease X-19 Epidemiology from Michael_Novakhov (39 sites): Google Alert - Sars-Cov-2... |
| Several cows have died after a cattle truck overturned in Sydney's west. ... Anzac dawn ceremonies in... |
 Disease X-19 from Michael_Novakhov (12 sites) 10h Disease X-19 from Michael_Novakhov (12 sites) 10h |
| Disease X-19 Regions from Michael_Novakhov (8 sites): Google Alert - coronavirus... |
| An experimental treatment from Shionogi & Co. has shown rapid clearance of the virus that causes... |
 Disease X-19 from Michael_Novakhov (12 sites) 10h Disease X-19 from Michael_Novakhov (12 sites) 10h |
| Disease X-19 Regions from Michael_Novakhov (8 sites): Google Alert - coronavirus... |
| Iranian Supreme Leader Ayatollah Khamenei's relationship with his closest superpower ally, Vladimir Putin,... |
 Disease X-19 from Michael_Novakhov (12 sites) 10h Disease X-19 from Michael_Novakhov (12 sites) 10h |
| Australia commemorates war dead with few COVID restrictions - ABC News |
| Australia commemorates war dead with few COVID restrictions ABC News |
 "coronavirus news" - Google News 10h "coronavirus news" - Google News 10h |
| COVID-19 hospitalizations increase by 12 in Maine - CentralMaine.com - Kennebec Journal... |
| COVID-19 hospitalizations increase by 12 in Maine - CentralMaine.com Kennebec Journal and Morning Sentinel |
 "Covid-19" - Google News 10h "Covid-19" - Google News 10h |
| Doctors weigh in on COVID-19 therapeutics - WKOW |
| Doctors weigh in on COVID-19 therapeutics WKOW |
 "COVID-19" - Google News 11h "COVID-19" - Google News 11h |
 | China Covid-19 tsar pushed treatments without revealing business ties - Financial... |
| China Covid-19 tsar pushed treatments without revealing business ties Financial Times |
 "COVID-19" - Google News 11h "COVID-19" - Google News 11h |
 | 'I have decided to place my trust in God.' How UC students, staff avoided COVID-19... |
| 'I have decided to place my trust in God.' How UC students, staff avoided COVID-19 mandate The Cincinnati... |
 "Covid-19" - Google News 11h "Covid-19" - Google News 11h |
| New Mississippi Law Bans COVID-19 Vaccine Mandates - U.S. News & World Report |
| New Mississippi Law Bans COVID-19 Vaccine Mandates U.S. News & World Report |
 "coronavirus news" - Google News 11h "coronavirus news" - Google News 11h |
| Capital University brings back mask requirement as COVID-19 cases rise - 10TV |
| Capital University brings back mask requirement as COVID-19 cases rise 10TV |
 "COVID" - Google News 11h "COVID" - Google News 11h |
| Australia commemorates war dead with few COVID restrictions - Star Tribune |
| Australia commemorates war dead with few COVID restrictions Star Tribune |
 "COVID" - Google News 11h "COVID" - Google News 11h |
 | Suburban DuPage County, others in elevated risk category as COVID-19 cases rise -... |
| Suburban DuPage County, others in elevated risk category as COVID-19 cases rise CBS News |
 "COVID-19" - Google News 11h "COVID-19" - Google News 11h |
| Disease X-19 General Issues from Michael_Novakhov (5 sites): Google Alert - sars... |
| Study Rundown: Patients with COVID-19 have been shown to develop acute ... Fewer hospital admissions... |
 Disease X-19 from Michael_Novakhov (12 sites) 11h Disease X-19 from Michael_Novakhov (12 sites) 11h |
| Disease X-19 General Issues from Michael_Novakhov (5 sites): Google Alert - Latest... |
| Shanghai authorities battling an outbreak of COVID-19 have erected fences outside ... April 24, 20222:11... |
 Disease X-19 from Michael_Novakhov (12 sites) 11h Disease X-19 from Michael_Novakhov (12 sites) 11h |
| Disease X-19 General Issues from Michael_Novakhov (5 sites): Google Alert - Latest... |
| Hospitalizations from COVID are up over 30% in the last two weeks in New York State, said Dr. Céline... |
 Disease X-19 from Michael_Novakhov (12 sites) 11h Disease X-19 from Michael_Novakhov (12 sites) 11h |
| Disease X-19 General Issues from Michael_Novakhov (5 sites): Google Alert - Latest... |
| Here's a quick wrap of each Australian jurisdiction's latest COVID-19 statistics today — Monday, April... |
 Disease X-19 from Michael_Novakhov (12 sites) 11h Disease X-19 from Michael_Novakhov (12 sites) 11h |
| Disease X-19 General Issues from Michael_Novakhov (5 sites): Google Alert - sars... |
| The pill, S-217622, "demonstrated rapid clearance of the infectious SARS-CoV-2 virus," Shionogi &... |
 Disease X-19 from Michael_Novakhov (12 sites) 11h Disease X-19 from Michael_Novakhov (12 sites) 11h |
 | US study suggests COVID-19 pandemic may be accelerating antimicrobial resistance... |
| US study suggests COVID-19 pandemic may be accelerating antimicrobial resistance EurekAlert |
 "Covid-19" - Google News 11h "Covid-19" - Google News 11h |
 | Pregnant women with COVID-19 face greater risk of hospitalisation and ICU admission,... |
| Pregnant women with COVID-19 face greater risk of hospitalisation and ICU admission, strengthening case... |
 "Covid-19" - Google News 11h "Covid-19" - Google News 11h |
| 4% patients with COVID-19 shed fecal viral RNA 10 months after diagnosis - News-Medical.Net |
| 4% patients with COVID-19 shed fecal viral RNA 10 months after diagnosis News-Medical.Net |
 "coronavirus news" - Google News 11h "coronavirus news" - Google News 11h |
| Impact of COVID-19 vaccination on anti-nucleocapsid antibody levels - News-Medical.Net |
| Impact of COVID-19 vaccination on anti-nucleocapsid antibody levels News-Medical.Net |
 "coronavirus news" - Google News 11h "coronavirus news" - Google News 11h |
| Georgia's Kemp and Perdue clash over elections in debate - News-Gazette |
| Georgia's Kemp and Perdue clash over elections in debate News-Gazette |
 "coronavirus news" - Google News 11h "coronavirus news" - Google News 11h |
| COVID didn't bum out these talented Kiester cooks - Faribault County Register |
| COVID didn't bum out these talented Kiester cooks Faribault County Register |
 "coronavirus news" - Google News 11h "coronavirus news" - Google News 11h |
| Live: 5690 Covid cases, 10 people die with virus, 514 in hospital - New Zealand Herald |
| Live: 5690 Covid cases, 10 people die with virus, 514 in hospital New Zealand Herald |
 "Omicron" - Google News 11h "Omicron" - Google News 11h |
| 'Stealth omicron': What we know so far? - NewsNation Now |
| 'Stealth omicron': What we know so far? NewsNation Now |
 "Omicron" - Google News 11h "Omicron" - Google News 11h |
| MA's COVID infection rate uncertain as many at-home tests go unreported - WWLP.com |
| MA's COVID infection rate uncertain as many at-home tests go unreported WWLP.com |
 "COVID" - Google News 12h "COVID" - Google News 12h |
| Italy reports 56263 new coronavirus cases, 79 deaths - Reuters |
| Italy reports 56263 new coronavirus cases, 79 deaths Reuters |
 "coronavirus news" - Google News 12h "coronavirus news" - Google News 12h |
| People who live, work in Beijing's Chaoyang will have to take 3 COVID tests in coming... |
| People who live, work in Beijing's Chaoyang will have to take 3 COVID tests in coming week Reuters |
 "coronavirus news" - Google News 12h "coronavirus news" - Google News 12h |
| S. Korea's new infections drop to 30,000s amid slowdown of omicron wave - The Korea... |
| S. Korea's new infections drop to 30,000s amid slowdown of omicron wave The Korea Herald |
 "Omicron" - Google News 12h "Omicron" - Google News 12h |
| Govt poorly supported disabled people in Omicron outbreak - inquiry - RNZ |
| Govt poorly supported disabled people in Omicron outbreak - inquiry RNZ |
 "Omicron" - Google News 12h "Omicron" - Google News 12h |
| WHO: 1 child has died in mystery liver disease outbreak - Eyewitness News 3 |
| WHO: 1 child has died in mystery liver disease outbreak Eyewitness News 3 |
 "covid -19 origins" - Google News 12h "covid -19 origins" - Google News 12h |
| Disease X-19 Epidemiology from Michael_Novakhov (39 sites): Google Alert - Coronavirus... |
| The 25th annual Wiener Dog Races returned after a two-year hiatus due to the COVID-19 ... Waterloo's... |
 Disease X-19 from Michael_Novakhov (12 sites) 12h Disease X-19 from Michael_Novakhov (12 sites) 12h |
| Disease X-19 Epidemiology from Michael_Novakhov (39 sites): Google Alert - covid-19... |
| The 25th annual Wiener Dog Races returned after a two-year hiatus due to the COVID-19 pandemic. Google... |
 Disease X-19 from Michael_Novakhov (12 sites) 12h Disease X-19 from Michael_Novakhov (12 sites) 12h |
| Disease X-19 Epidemiology from Michael_Novakhov (39 sites): Google Alert - coronavirus... |
| Waning Immunity: Study Shows Declining Effectiveness of 3rd Dose of mRNA COVID Vaccines. Regenstrief... |
 Disease X-19 from Michael_Novakhov (12 sites) 12h Disease X-19 from Michael_Novakhov (12 sites) 12h |
| Disease X-19 Epidemiology from Michael_Novakhov (39 sites): Google Alert - coronavirus... |
| The Inspectir COVID-19 Breathalyzer quickly detects the virus. ... and information about the coronavirus... |
 Disease X-19 from Michael_Novakhov (12 sites) 12h Disease X-19 from Michael_Novakhov (12 sites) 12h |
| Disease X-19 Epidemiology from Michael_Novakhov (39 sites): Google Alert - Sars Cov-2... |
| Hicks says the 15th annual Pet Expo is for animal lovers and pets. It comes as the U. S. saw record numbers... |
 Disease X-19 from Michael_Novakhov (12 sites) 12h Disease X-19 from Michael_Novakhov (12 sites) 12h |
| Disease X-19 Epidemiology from Michael_Novakhov (39 sites): Google Alert - coronavirus... |
| International travel should be protected in future pandemics, MPs have urged, describing the Covid restrictions... |
 Disease X-19 from Michael_Novakhov (12 sites) 12h Disease X-19 from Michael_Novakhov (12 sites) 12h |
 | UVA Health experts share insight on timing for COVID-19 booster - NBC 29 |
| UVA Health experts share insight on timing for COVID-19 booster NBC 29 |
 "Covid-19" - Google News 12h "Covid-19" - Google News 12h |
| COVID-19 case numbers from around the states and territories - ABC News |
| COVID-19 case numbers from around the states and territories ABC News |
 "coronavirus news" - Google News 12h "coronavirus news" - Google News 12h |
| CDC: COVID 3rd-highest cause of death in 2021 - KXAN.com |
| CDC: COVID 3rd-highest cause of death in 2021 KXAN.com |
 "COVID" - Google News 13h "COVID" - Google News 13h |
| Dodgers News: David Price Tested Positive For COVID - DodgerBlue.com |
| Dodgers News: David Price Tested Positive For COVID DodgerBlue.com |
 "COVID" - Google News 13h "COVID" - Google News 13h |
| St. Anthony: Humble Minneapolis entrepreneurs on the mend after COVID downturns -... |
| St. Anthony: Humble Minneapolis entrepreneurs on the mend after COVID downturns Star Tribune |
 "COVID" - Google News 13h "COVID" - Google News 13h |
| Baystate Health reports 53 COVID-19 patients - WWLP.com |
| Baystate Health reports 53 COVID-19 patients WWLP.com |
 "COVID-19" - Google News 13h "COVID-19" - Google News 13h |
| Disease X-19 Epidemiology from Michael_Novakhov (39 sites): Google Alert - coronavirus... |
| ... COVID are up over 30% in the last two weeks in New York State, said Dr. Céline Gounder, an infectious... |
 Disease X-19 from Michael_Novakhov (12 sites) 13h Disease X-19 from Michael_Novakhov (12 sites) 13h |
| Disease X-19 Regions from Michael_Novakhov (8 sites): Google Alert - coronavirus... |
| Juventus' Federico Bernardeschi, center obscured, celebrates after scoring during the Italian Cup semifinal... |
 Disease X-19 from Michael_Novakhov (12 sites) 13h Disease X-19 from Michael_Novakhov (12 sites) 13h |
| Disease X-19 Epidemiology from Michael_Novakhov (39 sites): Google Alert - coronavirus... |
| The study however clarified that there is no evidence that the infected animals can be carriers for humans... |
 Disease X-19 from Michael_Novakhov (12 sites) 13h Disease X-19 from Michael_Novakhov (12 sites) 13h |
| Disease X-19 Regions from Michael_Novakhov (8 sites): Google Alert - coronavirus... |
| He's called himself "the face of the new Democratic party." New York City Mayor Eric Adams talks to 60... |
 Disease X-19 from Michael_Novakhov (12 sites) 13h Disease X-19 from Michael_Novakhov (12 sites) 13h |
| Disease X-19 Regions from Michael_Novakhov (8 sites): Google Alert - Coronavirus... |
| The Brooklyn mother of an 11-year-old girl who was killed when a state police officer rammed their car... |
 Disease X-19 from Michael_Novakhov (12 sites) 13h Disease X-19 from Michael_Novakhov (12 sites) 13h |
| Disease X-19 Epidemiology from Michael_Novakhov (39 sites): Google Alert - coronavirus... |
| Hicks says the 15th annual Pet Expo is for animal lovers and pets. It comes as the U. S. saw record numbers... |
 Disease X-19 from Michael_Novakhov (12 sites) 13h Disease X-19 from Michael_Novakhov (12 sites) 13h |
| Disease X-19 Epidemiology from Michael_Novakhov (39 sites): Google Alert - coronavirus... |
| ... and Pfizer are testing 2-in-1 COVID-19 protection that they hope to offer this fall. Each bivalent... |
 Disease X-19 from Michael_Novakhov (12 sites) 13h Disease X-19 from Michael_Novakhov (12 sites) 13h |
| Disease X-19 Epidemiology from Michael_Novakhov (39 sites): Google Alert - covid-19... |
| Lawrence County reported seven new COVID-19 cases over the weekend, state health officials said. Google... |
 Disease X-19 from Michael_Novakhov (12 sites) 13h Disease X-19 from Michael_Novakhov (12 sites) 13h |
| Disease X-19 Epidemiology from Michael_Novakhov (39 sites): Google Alert - coronavirus... |
| While the incidence and positivity rate of COVID-19 in Puerto Rico, ... of the Office of Health Epidemiology,... |
 Disease X-19 from Michael_Novakhov (12 sites) 13h Disease X-19 from Michael_Novakhov (12 sites) 13h |
| Disease X-19 Epidemiology from Michael_Novakhov (39 sites): Google Alert - Sars-Cov-2... |
| A number of cows are believed to have died after a cattle truck ... Queensland to end COVID-19 isolation... |
 Disease X-19 from Michael_Novakhov (12 sites) 13h Disease X-19 from Michael_Novakhov (12 sites) 13h |
| Disease X-19 Epidemiology from Michael_Novakhov (39 sites): Google Alert - coronavirus... |
| But can the virus also spread to other animals? A recent state-based study answers in affirmative – with... |
 Disease X-19 from Michael_Novakhov (12 sites) 13h Disease X-19 from Michael_Novakhov (12 sites) 13h |
| Disease X-19 Epidemiology from Michael_Novakhov (39 sites): Google Alert - covid-19... |
| San Francisco Giants outfielder Mike Yastrzemski was placed on the COVID-19 list Sunday after testing... |
 Disease X-19 from Michael_Novakhov (12 sites) 13h Disease X-19 from Michael_Novakhov (12 sites) 13h |
| Disease X-19 Epidemiology from Michael_Novakhov (39 sites): Google Alert - Coronavirus... |
| "In a sense, my career to date has been bookended by these two pandemics: HIV and COVID," Fitzgerald-Boscarly... |
 Disease X-19 from Michael_Novakhov (12 sites) 13h Disease X-19 from Michael_Novakhov (12 sites) 13h |
| Disease X-19 Regions from Michael_Novakhov (8 sites): Google Alert - coronavirus... |
| New York City Mayor Eric Adams told Anderson Cooper "we have to remain vigilant" about COVID-19 but the... |
 Disease X-19 from Michael_Novakhov (12 sites) 13h Disease X-19 from Michael_Novakhov (12 sites) 13h |
 | China's Travel Industry Hurt by Continued COVID-19 Measures - VOA Learning English |
| China's Travel Industry Hurt by Continued COVID-19 Measures VOA Learning English |
 "Covid-19" - Google News 13h "Covid-19" - Google News 13h |
| Ashish Jha on the omicron BA.2 variant wave: 'We're going to get through this without... |
| Ashish Jha on the omicron BA.2 variant wave: 'We're going to get through this without disruption' Boston... |
 "Omicron" - Google News 13h "Omicron" - Google News 13h |
| Covid-19 Omicron outbreak: Latest hospital, case numbers due as vaccinations lag,... |
| Covid-19 Omicron outbreak: Latest hospital, case numbers due as vaccinations lag, XE looms New Zealand... |
 "Omicron" - Google News 13h "Omicron" - Google News 13h |
| EDITORIAL | Don't wait to seek COVID meds - Star Tribune |
| EDITORIAL | Don't wait to seek COVID meds Star Tribune |
 "COVID" - Google News 13h "COVID" - Google News 13h |
| Disease X-19 Epidemiology from Michael_Novakhov (39 sites): Google Alert - covid-19... |
| Online grocery orders surged during the COVID-19 pandemic, but consumers are becoming ... Switch regular... |
 Disease X-19 from Michael_Novakhov (12 sites) 13h Disease X-19 from Michael_Novakhov (12 sites) 13h |
| Disease X-19 Epidemiology from Michael_Novakhov (39 sites): Google Alert - coronavirus... |
| Channel 3 has been making calls to nursing homes in the Panhandle to see if they are able to take in... |
 Disease X-19 from Michael_Novakhov (12 sites) 13h Disease X-19 from Michael_Novakhov (12 sites) 13h |
| Disease X-19 Epidemiology from Michael_Novakhov (39 sites): Google Alert - Sars Cov-2... |
| But can the virus also spread to other animals? A recent state-based study answers in affirmative – with... |
 Disease X-19 from Michael_Novakhov (12 sites) 13h Disease X-19 from Michael_Novakhov (12 sites) 13h |
| Disease X-19 Epidemiology from Michael_Novakhov (39 sites): Google Alert - Coronavirus... |
| The U.S. government is rapidly moving Paxlovid to pharmacies, hospitals, nursing homes and other facilities... |
 Disease X-19 from Michael_Novakhov (12 sites) 13h Disease X-19 from Michael_Novakhov (12 sites) 13h |
| Disease X-19 Epidemiology from Michael_Novakhov (39 sites): Google Alert - Coronavirus... |
| The NSGEU, meanwhile, represents 18,000 health-care workers including nurses, support services and admin... |
 Disease X-19 from Michael_Novakhov (12 sites) 13h Disease X-19 from Michael_Novakhov (12 sites) 13h |
| Disease X-19 Epidemiology from Michael_Novakhov (39 sites): Google Alert - Coronavirus... |
| PARIS — Emmanuel Macron has become the first French president in two decades to win a second term, holding... |
 Disease X-19 from Michael_Novakhov (12 sites) 13h Disease X-19 from Michael_Novakhov (12 sites) 13h |
| Disease X-19 Epidemiology from Michael_Novakhov (39 sites): Google Alert - Coronavirus... |
| COVID-19 cases and hospitalizations are rising once again across the country, driven by more contagious... |
 Disease X-19 from Michael_Novakhov (12 sites) 13h Disease X-19 from Michael_Novakhov (12 sites) 13h |
| Disease X-19 Epidemiology from Michael_Novakhov (39 sites): Google Alert - covid-19... |
| ... to travel in the biggest numbers since the start of the pandemic. ... increase in COVID-19 cases... |
 Disease X-19 from Michael_Novakhov (12 sites) 13h Disease X-19 from Michael_Novakhov (12 sites) 13h |
| Disease X-19 Epidemiology from Michael_Novakhov (39 sites): Google Alert - covid-19... |
| Nearly one year to the day after receiving my first dose of the COVID-19 vaccine, I tested positive for... |
 Disease X-19 from Michael_Novakhov (12 sites) 13h Disease X-19 from Michael_Novakhov (12 sites) 13h |
| Disease X-19 Epidemiology from Michael_Novakhov (39 sites): Google Alert - rats in... |
| New York City Mayor Eric Adams attends a screening of the film "Equiano's ... a vat of drowned rats to... |
 Disease X-19 from Michael_Novakhov (12 sites) 13h Disease X-19 from Michael_Novakhov (12 sites) 13h |
| Buda Wiener Dog Races return after COVID-19 hiatus - KXAN.com |
| Buda Wiener Dog Races return after COVID-19 hiatus KXAN.com |
 "Covid-19" - Google News 13h "Covid-19" - Google News 13h |
| School Takes Precautions For Hillsdale High Prom Due to COVID Concerns - ABC17NEWS... |
| School Takes Precautions For Hillsdale High Prom Due to COVID Concerns - ABC17NEWS ABC17News.com |
 "coronavirus news" - Google News 13h "coronavirus news" - Google News 13h |
| Shanghai, China Covid Lockdown: Residents Complain Online - Bloomberg |
| Shanghai, China Covid Lockdown: Residents Complain Online Bloomberg |
 "coronavirus news" - Google News 13h "coronavirus news" - Google News 13h |
| School Takes Precautions For Hillsdale High Prom Due to COVID Concerns - KTVZ |
| School Takes Precautions For Hillsdale High Prom Due to COVID Concerns KTVZ |
 "COVID" - Google News 14h "COVID" - Google News 14h |
 | Active COVID-19 cases inch up in Ulster County, jump in Dutchess - The Daily Freeman |
| Active COVID-19 cases inch up in Ulster County, jump in Dutchess The Daily Freeman |
 "COVID-19" - Google News 14h "COVID-19" - Google News 14h |
| Disease X-19 General Issues from Michael_Novakhov (5 sites): Google Alert - Latest... |
| COVID-19 virus model showing its structure. (U.S. Centers for Disease Control and Prevention). By Reading... |
 Disease X-19 from Michael_Novakhov (12 sites) 14h Disease X-19 from Michael_Novakhov (12 sites) 14h |
| Disease X-19 General Issues from Michael_Novakhov (5 sites): Google Alert - Latest... |
| Here's the latest news from the pandemic. Shanghai reports a record daily death tally in current outbreak;... |
 Disease X-19 from Michael_Novakhov (12 sites) 14h Disease X-19 from Michael_Novakhov (12 sites) 14h |
| Disease X-19 General Issues from Michael_Novakhov (5 sites): Google Alert - sars... |
| "So this is the same virus, so SARS Coronavirus 2, so we're seeing the same symptoms," he said. Dr. Gregory... |
 Disease X-19 from Michael_Novakhov (12 sites) 14h Disease X-19 from Michael_Novakhov (12 sites) 14h |
| Disease X-19 General Issues from Michael_Novakhov (5 sites): Google Alert - Latest... |
| As cases of the coronavirus begin to rise in Illinois and parts of the U.S., due in part to the ... Get... |
 Disease X-19 from Michael_Novakhov (12 sites) 14h Disease X-19 from Michael_Novakhov (12 sites) 14h |
| Disease X-19 General Issues from Michael_Novakhov (5 sites): Google Alert - Latest... |
| RICHMOND, Va. -- COVID-19 hospitalizations in the Commonwealth increased 23% last week, according to... |
 Disease X-19 from Michael_Novakhov (12 sites) 14h Disease X-19 from Michael_Novakhov (12 sites) 14h |
| Disease X-19 General Issues from Michael_Novakhov (5 sites): Google Alert - sars... |
| A new study on Chile's national COVID-19 vaccination program, to be presented at this year's European... |
 Disease X-19 from Michael_Novakhov (12 sites) 14h Disease X-19 from Michael_Novakhov (12 sites) 14h |
| Disease X-19 General Issues from Michael_Novakhov (5 sites): Google Alert - sars... |
| The pill, S-217622, "demonstrated rapid clearance of the infectious SARS-CoV-2 virus," Shionogi said... |
 Disease X-19 from Michael_Novakhov (12 sites) 14h Disease X-19 from Michael_Novakhov (12 sites) 14h |
| Disease X-19 General Issues from Michael_Novakhov (5 sites): Google Alert - Latest... |
| The UKHSA has said that as of 22 March, 637 cases of XE had been detected in England. This is only a... |
 Disease X-19 from Michael_Novakhov (12 sites) 14h Disease X-19 from Michael_Novakhov (12 sites) 14h |
| Covid-19 forces cancelation of final 'Anastasia' show - Buffalo News |
| Covid-19 forces cancelation of final 'Anastasia' show Buffalo News |
 "Covid-19" - Google News 14h "Covid-19" - Google News 14h |
 | COVID-19 shots still work, but researchers hunt new improvements - Honolulu Star-Advertiser |
| COVID-19 shots still work, but researchers hunt new improvements Honolulu Star-Advertiser |
 "Covid-19" - Google News 14h "Covid-19" - Google News 14h |
| 'Concerned but not troubled': Upstate New York is now a Covid-19 hot spot - Buffalo... |
| 'Concerned but not troubled': Upstate New York is now a Covid-19 hot spot Buffalo News |
 "coronavirus news" - Google News 14h "coronavirus news" - Google News 14h |
| Disease X-19 General Issues from Michael_Novakhov (5 sites): Google Alert - Covid-19:... |
| The San Francisco Giants lost outfielder Mike Yastrzemski to the COVID-19 list on Sunday... Google... |
 Disease X-19 from Michael_Novakhov (12 sites) 14h Disease X-19 from Michael_Novakhov (12 sites) 14h |
| Disease X-19 Regions from Michael_Novakhov (8 sites): Google Alert - coronavirus... |
| Italy reported 70,520 Covid-19 related cases on Saturday, against 73,212 the day before, the health ministry... |
 Disease X-19 from Michael_Novakhov (12 sites) 14h Disease X-19 from Michael_Novakhov (12 sites) 14h |
| Disease X-19 Regions from Michael_Novakhov (8 sites): Google Alert - Coronavirus... |
| Ben Simmons has been ruled out of Game 4 of Brooklyn's playoff series against Boston, making it possible... |
 Disease X-19 from Michael_Novakhov (12 sites) 14h Disease X-19 from Michael_Novakhov (12 sites) 14h |
| Disease X-19 Regions from Michael_Novakhov (8 sites): Google Alert - coronavirus... |
| It's our first time bringing an Under 30 event to Botswana—indeed, to the African continent. Google... |
 Disease X-19 from Michael_Novakhov (12 sites) 14h Disease X-19 from Michael_Novakhov (12 sites) 14h |
| Disease X-19 Regions from Michael_Novakhov (8 sites): Google Alert - coronavirus... |
| Over 15,000 comments on Covid-19 draft regulations received ... disease to which more than 80% of South... |
 Disease X-19 from Michael_Novakhov (12 sites) 14h Disease X-19 from Michael_Novakhov (12 sites) 14h |
| Disease X-19 Regions from Michael_Novakhov (8 sites): Google Alert - Coronavirus... |
| Ben Simmons has been ruled out of Game 4 of Brooklyn's playoff series against Boston ... KXAN is tracking... |
 Disease X-19 from Michael_Novakhov (12 sites) 14h Disease X-19 from Michael_Novakhov (12 sites) 14h |
| Disease X-19 General Issues from Michael_Novakhov (5 sites): Google Alert - Covid-19:... |
| COVID-19 vaccinations are at a critical juncture as companies test whether new approaches like combination... |
 Disease X-19 from Michael_Novakhov (12 sites) 14h Disease X-19 from Michael_Novakhov (12 sites) 14h |
| Disease X-19 General Issues from Michael_Novakhov (5 sites): Google Alert - Covid-19:... |
| AUGUSTA, Maine (WABI) - COVID-19 hospitalizations appear to be increasing here in Maine. The Maine CDC... |
 Disease X-19 from Michael_Novakhov (12 sites) 14h Disease X-19 from Michael_Novakhov (12 sites) 14h |
| Disease X-19 Regions from Michael_Novakhov (8 sites): Google Alert - coronavirus... |
| IMOLA, Italy (AP) — Formula One champion Max Verstappen dominated Sunday ... NFL draft's 'lying season'... |
 Disease X-19 from Michael_Novakhov (12 sites) 14h Disease X-19 from Michael_Novakhov (12 sites) 14h |
| Disease X-19 Regions from Michael_Novakhov (8 sites): Google Alert - coronavirus... |
| Lazio players celebrate after Lazio's Ciro Immobile scored his side's first goal during the Serie A soccer... |
 Disease X-19 from Michael_Novakhov (12 sites) 14h Disease X-19 from Michael_Novakhov (12 sites) 14h |
| Disease X-19 Regions from Michael_Novakhov (8 sites): Google Alert - coronavirus... |
| IMOLA, Italy. Formula One champion Max Verstappen dominated Sunday in a Red Bull rout of Ferrari at the... |
 Disease X-19 from Michael_Novakhov (12 sites) 14h Disease X-19 from Michael_Novakhov (12 sites) 14h |
| Disease X-19 Regions from Michael_Novakhov (8 sites): Google Alert - coronavirus... |
| Local News · National/World · Problem Solvers · Coronavirus · Russia and Ukraine Conflict · Data Desk... |
 Disease X-19 from Michael_Novakhov (12 sites) 14h Disease X-19 from Michael_Novakhov (12 sites) 14h |
| Disease X-19 Regions from Michael_Novakhov (8 sites): Google Alert - coronavirus... |
| Fresh public outcry as Shanghai fences up Covid-hit areas ... A voter casts a ballot during the second... |
 Disease X-19 from Michael_Novakhov (12 sites) 14h Disease X-19 from Michael_Novakhov (12 sites) 14h |
 | Shanghai erects metal barriers in fight against COVID-19 - Oregon Public Broadcasting |
| Shanghai erects metal barriers in fight against COVID-19 Oregon Public Broadcasting |
 "Covid-19" - Google News 14h "Covid-19" - Google News 14h |
| Monongalia County Commission approves new round of coronavirus funding - West Virginia... |
| Monongalia County Commission approves new round of coronavirus funding West Virginia MetroNews |
 "coronavirus news" - Google News 14h "coronavirus news" - Google News 14h |
| Coronavirus News: 1,083 Fresh Covid Cases in Delhi Today; PM Warns Nation Ahead of... |
| Coronavirus News: 1,083 Fresh Covid Cases in Delhi Today; PM Warns Nation Ahead of Festivals News18 |
 "coronavirus news" - Google News 14h "coronavirus news" - Google News 14h |
| Disease X-19 Publications from Michael_Novakhov (5 sites): Google Alert - covid-19... |
| Volunteers wearing PPE disinfect a residential community at Yangpu district during the phased lockdown... |
 Disease X-19 from Michael_Novakhov (12 sites) 15h Disease X-19 from Michael_Novakhov (12 sites) 15h |
| Disease X-19 Publications from Michael_Novakhov (5 sites): Google Alert - covid-19... |
| By Katelyn Caralle, U.S. Political Reporter For Dailymail.com 12:17 EDT 24 ... emergency from the COVID-19... |
 Disease X-19 from Michael_Novakhov (12 sites) 15h Disease X-19 from Michael_Novakhov (12 sites) 15h |
 | COVID-19 cases are rising sharply again — should we worry? - Vallejo Times-Herald |
| COVID-19 cases are rising sharply again — should we worry? Vallejo Times-Herald |
 "Covid-19" - Google News 15h "Covid-19" - Google News 15h |
| How Soon After Exposure Do COVID Symptoms Start? - NBC Chicago |
| How Soon After Exposure Do COVID Symptoms Start? NBC Chicago |
 "coronavirus news" - Google News 15h "coronavirus news" - Google News 15h |
| LA County's COVID Hospitalizations Rise Slightly - NBC Southern California |
| LA County's COVID Hospitalizations Rise Slightly NBC Southern California |
 "coronavirus news" - Google News 15h "coronavirus news" - Google News 15h |
| To Europe's relief, France's Macron wins but far-right gains - News-Gazette |
| To Europe's relief, France's Macron wins but far-right gains News-Gazette |
 "coronavirus news" - Google News 15h "coronavirus news" - Google News 15h |
| Outdoor dining in Boulder to continue after coronavirus pandemic - Boulder Daily... |
| Outdoor dining in Boulder to continue after coronavirus pandemic Boulder Daily Camera |
 "coronavirus news" - Google News 15h "coronavirus news" - Google News 15h |
 | Durability of BNT162b2 vaccine against hospital and emergency department admissions... |
| submitted by /u/buddyboys [link] [comments] |
| |
| Disease X-19 Epidemiology from Michael_Novakhov (39 sites): Google Alert - coronavirus... |
| Flying with toddlers during Covid. In this week's edition of the Covid Q&A, we look at vacationing... |
 Disease X-19 from Michael_Novakhov (12 sites) 15h Disease X-19 from Michael_Novakhov (12 sites) 15h |
| Disease X-19 Epidemiology from Michael_Novakhov (39 sites): Google Alert - Sars Cov-2... |
| Farm animals have recently been identified as RT078 reservoirs. ... Antimicrobial resistance in COVID-19... |
 Disease X-19 from Michael_Novakhov (12 sites) 15h Disease X-19 from Michael_Novakhov (12 sites) 15h |
| Disease X-19 Epidemiology from Michael_Novakhov (39 sites): Google Alert - Coronavirus... |
| Further inaction is unacceptable, and Congress must promptly provide us the funds we urgently need, a... |
 Disease X-19 from Michael_Novakhov (12 sites) 15h Disease X-19 from Michael_Novakhov (12 sites) 15h |
| Disease X-19 Epidemiology from Michael_Novakhov (39 sites): Google Alert - coronavirus... |
| How is Colorado's water situation right now? We Coloradans are lucky. We are a headwater state, meaning... |
 Disease X-19 from Michael_Novakhov (12 sites) 15h Disease X-19 from Michael_Novakhov (12 sites) 15h |
| Disease X-19 Epidemiology from Michael_Novakhov (39 sites): Google Alert - Sars Cov-2... |
| Priyan Perera, a globally recognized expert on the species, says he hopes ... Isolation of SARS-CoV-2-related... |
 Disease X-19 from Michael_Novakhov (12 sites) 15h Disease X-19 from Michael_Novakhov (12 sites) 15h |
| Disease X-19 Epidemiology from Michael_Novakhov (39 sites): Google Alert - Coronavirus... |
| Moderna and Pfizer have been working on new Covid-19 vaccines designed to offer ... and digital health... |
 Disease X-19 from Michael_Novakhov (12 sites) 15h Disease X-19 from Michael_Novakhov (12 sites) 15h |
| Disease X-19 Epidemiology from Michael_Novakhov (39 sites): Google Alert - coronavirus... |
| Mosaic is required to collect water samples quarterly from several monitoring wells in the area and from... |
 Disease X-19 from Michael_Novakhov (12 sites) 15h Disease X-19 from Michael_Novakhov (12 sites) 15h |
| Disease X-19 Epidemiology from Michael_Novakhov (39 sites): Google Alert - Coronavirus... |
| Meanwhile, 25 HIV screenings were also done. ... 4 routine immunizations and 16 covid vaccines were also... |
 Disease X-19 from Michael_Novakhov (12 sites) 15h Disease X-19 from Michael_Novakhov (12 sites) 15h |
| Disease X-19 Regions from Michael_Novakhov (8 sites): Google Alert - coronavirus... |
| The NICD has reported 3,222 new COVID-19 cases that have been identified in South Africa, which brings... |
 Disease X-19 from Michael_Novakhov (12 sites) 15h Disease X-19 from Michael_Novakhov (12 sites) 15h |
| Disease X-19 Regions from Michael_Novakhov (8 sites): Google Alert - coronavirus... |
| Rhinos in Tswalu, South Africa's largest private game reserve. ... Travel groups push to end Covid tests... |
 Disease X-19 from Michael_Novakhov (12 sites) 15h Disease X-19 from Michael_Novakhov (12 sites) 15h |
| Disease X-19 Regions from Michael_Novakhov (8 sites): Google Alert - coronavirus... |
| ... Johnson Covid-19 vaccine production line during a media tour at the Aspen Pharmacare Holdings Ltd.... |
 Disease X-19 from Michael_Novakhov (12 sites) 15h Disease X-19 from Michael_Novakhov (12 sites) 15h |
 | COVID shots still work but researchers hunt new improvements - Spectrum News |
| COVID shots still work but researchers hunt new improvements Spectrum News |
 "Covid-19" - Google News 15h "Covid-19" - Google News 15h |
| Six Flags New England wraps up COVID vaccine initiative week - WWLP.com |
| Six Flags New England wraps up COVID vaccine initiative week WWLP.com |
 "coronavirus news" - Google News 15h "coronavirus news" - Google News 15h |
| Protesters Call for Chicago to Reinstate Mask Mandate Due to Rising COVID Cases -... |
| Protesters Call for Chicago to Reinstate Mask Mandate Due to Rising COVID Cases NBC Chicago |
 "COVID" - Google News 16h "COVID" - Google News 16h |
| First SF Giants player this season tests positive for COVID-19 - Santa Cruz Sentinel |
| First SF Giants player this season tests positive for COVID-19 Santa Cruz Sentinel |
 "COVID" - Google News 16h "COVID" - Google News 16h |
| CA health dept. says people exposed to COVID-19 but are asymptomatic no longer recommended... |
| CA health dept. says people exposed to COVID-19 but are asymptomatic no longer recommended to quarantine KTVU... |
 "COVID" - Google News 16h "COVID" - Google News 16h |
| Disease X-19 Publications from Michael_Novakhov (5 sites): Google Alert - coronavirus... |
| Twitter Inc. is re-examining Elon Musk's $43 billion takeover offer after he secured financing for the... |
 Disease X-19 from Michael_Novakhov (12 sites) 16h Disease X-19 from Michael_Novakhov (12 sites) 16h |
| Disease X-19 Publications from Michael_Novakhov (5 sites): Google Alert - coronavirus... |
| Twitter Inc. is re-examining Elon Musk's $43 billion takeover offer after the billionaire lined up financing... |
 Disease X-19 from Michael_Novakhov (12 sites) 16h Disease X-19 from Michael_Novakhov (12 sites) 16h |
| Disease X-19 Publications from Michael_Novakhov (5 sites): Google Alert - coronavirus... |
| (Reuters) - Twitter Inc is coming under increasing pressure from its shareholders to negotiate with Elon... |
 Disease X-19 from Michael_Novakhov (12 sites) 16h Disease X-19 from Michael_Novakhov (12 sites) 16h |
| Disease X-19 Publications from Michael_Novakhov (5 sites): Google Alert - coronavirus... |
| #GoBlue 4 - OSU 3. Watch on Twitter ... The coronavirus pandemic rages on, but is dwindling with... Read... |
 Disease X-19 from Michael_Novakhov (12 sites) 16h Disease X-19 from Michael_Novakhov (12 sites) 16h |
| Disease X-19 Publications from Michael_Novakhov (5 sites): Google Alert - coronavirus... |
| Last week, it was revealed that a San Francisco judge had determined that one of Musk's 2018 tweets about... |
 Disease X-19 from Michael_Novakhov (12 sites) 16h Disease X-19 from Michael_Novakhov (12 sites) 16h |
| Disease X-19 Publications from Michael_Novakhov (5 sites): Google Alert - new york... |
| COVID-19 is surging in Mainland China, where the virus first emerged ... New York overall has had a spike,... |
 Disease X-19 from Michael_Novakhov (12 sites) 16h Disease X-19 from Michael_Novakhov (12 sites) 16h |
| Disease X-19 Publications from Michael_Novakhov (5 sites): Google Alert - new york... |
| Shanghai authorities erected high fences outside the homes of residents who tested positive for COVID-19... |
 Disease X-19 from Michael_Novakhov (12 sites) 16h Disease X-19 from Michael_Novakhov (12 sites) 16h |
 | Ald. Sigcho-Lopez, advocates say city's COVID-19 relief money has largely gone to... |
| Ald. Sigcho-Lopez, advocates say city's COVID-19 relief money has largely gone to contractors: 'They're... |
 "Covid-19" - Google News 16h "Covid-19" - Google News 16h |
| COVID-19 cases climbing slowly in Frederick County | Coronavirus | fredericknewspost.com... |
| COVID-19 cases climbing slowly in Frederick County | Coronavirus | fredericknewspost.com Frederick News... |
 "Covid-19" - Google News 16h "Covid-19" - Google News 16h |
| COVID-19 hospitalizations in Maine see significant jump Sunday - WABI |
| COVID-19 hospitalizations in Maine see significant jump Sunday WABI |
 "coronavirus news" - Google News 16h "coronavirus news" - Google News 16h |
| A sensible shift away from COVID mask mandates - Raleigh News & Observer |
| A sensible shift away from COVID mask mandates Raleigh News & Observer |
 "coronavirus news" - Google News 16h "coronavirus news" - Google News 16h |
 | Severe Hepatitis in Pediatric COVID-19 |
| submitted by /u/PrincessGambit [link] [comments] |
| |
| COVID cases falling in Americas, but risk of further surges remains - PAHO - Reuters |
| COVID cases falling in Americas, but risk of further surges remains - PAHO Reuters |
 "COVID" - Google News 16h "COVID" - Google News 16h |
 | Texas Rangers activate Spencer Howard, Dennis Santana - The Dallas Morning News |
| Texas Rangers activate Spencer Howard, Dennis Santana The Dallas Morning News |
 "COVID-19" - Google News 16h "COVID-19" - Google News 16h |
| Disease X-19 Epidemiology from Michael_Novakhov (39 sites): Google Alert - Covid-19:... |
| ABSTRACTNumerous genes for monogenic kidney diseases. ... clinical examination for extrarenal symptoms,... |
 Disease X-19 from Michael_Novakhov (12 sites) 16h Disease X-19 from Michael_Novakhov (12 sites) 16h |
| Disease X-19 Epidemiology from Michael_Novakhov (39 sites): Google Alert - coronavirus... |
| At least 9,483 of the state's COVID-19 deaths have been among residents and employees in nursing homes... |
 Disease X-19 from Michael_Novakhov (12 sites) 16h Disease X-19 from Michael_Novakhov (12 sites) 16h |
| Disease X-19 Epidemiology from Michael_Novakhov (39 sites): Google Alert - coronavirus... |
| The coronavirus pandemic has left many moms struggling, and this writer has a message: You are not alone.Vera... |
 Disease X-19 from Michael_Novakhov (12 sites) 16h Disease X-19 from Michael_Novakhov (12 sites) 16h |
| Disease X-19 Epidemiology from Michael_Novakhov (39 sites): Google Alert - Covid-19:... |
| While the OTA performs necessary environmental impact studies before ... uncovering the genetic code... |
 Disease X-19 from Michael_Novakhov (12 sites) 16h Disease X-19 from Michael_Novakhov (12 sites) 16h |
| Disease X-19 Epidemiology from Michael_Novakhov (39 sites): Google Alert - coronavirus... |
| New Jersey on Sunday reported two new COVID-19 deaths across the state and ... staff members at nursing... |
 Disease X-19 from Michael_Novakhov (12 sites) 16h Disease X-19 from Michael_Novakhov (12 sites) 16h |
| Disease X-19 Epidemiology from Michael_Novakhov (39 sites): Google Alert - coronavirus... |
| The number of COVID-positive patients in Los Angeles County hospitals has increased by nine people to... |
 Disease X-19 from Michael_Novakhov (12 sites) 16h Disease X-19 from Michael_Novakhov (12 sites) 16h |
| Disease X-19 Epidemiology from Michael_Novakhov (39 sites): Google Alert - coronavirus... |
| In all cases, this second booster shouldn't come until at least four months have elapsed since your first... |
 Disease X-19 from Michael_Novakhov (12 sites) 16h Disease X-19 from Michael_Novakhov (12 sites) 16h |
| Disease X-19 Epidemiology from Michael_Novakhov (39 sites): Google Alert - coronavirus... |
| A report released Thursday by the America Health Care Association notes that more than 300 nursing homes... |
 Disease X-19 from Michael_Novakhov (12 sites) 16h Disease X-19 from Michael_Novakhov (12 sites) 16h |
| Disease X-19 Epidemiology from Michael_Novakhov (39 sites): Google Alert - coronavirus... |
| Internationally scientists are studying whether BA.4 and BA.5 have mutated to increase the virus' ability... |
 Disease X-19 from Michael_Novakhov (12 sites) 16h Disease X-19 from Michael_Novakhov (12 sites) 16h |
| Disease X-19 Epidemiology from Michael_Novakhov (39 sites): Google Alert - coronavirus... |
| Tourism dropped drastically during the coronavirus pandemic. Mainly because there weren't any cruises.... |
 Disease X-19 from Michael_Novakhov (12 sites) 16h Disease X-19 from Michael_Novakhov (12 sites) 16h |
| Disease X-19 General Issues from Michael_Novakhov (5 sites): Google Alert - Covid-19:... |
| Moderna and Pfizer have been working on new Covid-19 vaccines designed to offer better protection against... |
 Disease X-19 from Michael_Novakhov (12 sites) 16h Disease X-19 from Michael_Novakhov (12 sites) 16h |
| Disease X-19 General Issues from Michael_Novakhov (5 sites): Google Alert - Covid-19:... |
| The citywide 7-day positivity rate for COVID-19 infections grew to 5.79% on Friday, April 22 — a number... |
 Disease X-19 from Michael_Novakhov (12 sites) 16h Disease X-19 from Michael_Novakhov (12 sites) 16h |
| Disease X-19 General Issues from Michael_Novakhov (5 sites): Google Alert - Covid-19:... |
| DENVER — A study found that COVID-19 vaccine hesitancy waned over time for caregivers of children with... |
 Disease X-19 from Michael_Novakhov (12 sites) 16h Disease X-19 from Michael_Novakhov (12 sites) 16h |
 | Research identifies inadequate PPE management in COVID-19 testing centers as source... |
| Research identifies inadequate PPE management in COVID-19 testing centers as source of major cross-contamination News-Medical.Net |
 "Covid-19" - Google News 16h "Covid-19" - Google News 16h |
 | COVID shots still work but researchers hunt new improvements - KY3 |
| COVID shots still work but researchers hunt new improvements KY3 |
 "Covid-19" - Google News 16h "Covid-19" - Google News 16h |
| Opposition wins Slovenia vote, defeating right-wing populist - News-Gazette |
| Opposition wins Slovenia vote, defeating right-wing populist News-Gazette |
 "coronavirus news" - Google News 17h "coronavirus news" - Google News 17h |
| After spring break, CT schools should prepare for COVID surge, state warns - CT Insider |
| After spring break, CT schools should prepare for COVID surge, state warns CT Insider |
 "COVID" - Google News 17h "COVID" - Google News 17h |
| Biggest crowds since COVID flock Waterfront Park for Thunder Over Louisville - WAVE... |
| Biggest crowds since COVID flock Waterfront Park for Thunder Over Louisville WAVE 3 |
 "COVID" - Google News 17h "COVID" - Google News 17h |
| Disease X-19 and Security from Michael_Novakhov (10 sites): Google Alert - Coronavirus... |
| The WTTC's report focuses on the fact that the COVID-19 pandemic forced businesses ... "But the impact... |
 Disease X-19 from Michael_Novakhov (12 sites) 17h Disease X-19 from Michael_Novakhov (12 sites) 17h |
| Disease X-19 and Security from Michael_Novakhov (10 sites): Google Alert - Coronavirus... |
| ... cyber security partnership to tackle shared cyber threats including to ... "They outlined commitment,... |
 Disease X-19 from Michael_Novakhov (12 sites) 17h Disease X-19 from Michael_Novakhov (12 sites) 17h |
| Disease X-19 and Security from Michael_Novakhov (10 sites): Google Alert - Coronavirus... |
| Dan Lohrmann, a cybersecurity experts from Presidio, provides details on the nation's cyber defense agency,... |
 Disease X-19 from Michael_Novakhov (12 sites) 17h Disease X-19 from Michael_Novakhov (12 sites) 17h |
| Disease X-19 and Security from Michael_Novakhov (10 sites): Google Alert - Coronavirus... |
| Boston, Gateway Cities, and other municipalities with significant populations of color are disproportionately... |
 Disease X-19 from Michael_Novakhov (12 sites) 17h Disease X-19 from Michael_Novakhov (12 sites) 17h |
| China able to beat Omicron - Chinadaily.com.cn - China Daily |
| China able to beat Omicron - Chinadaily.com.cn China Daily |
 "Omicron" - Google News 17h "Omicron" - Google News 17h |
| COVID-19 vaccine protection against omicron wanes over time, study shows - News-Medical.Net |
| COVID-19 vaccine protection against omicron wanes over time, study shows News-Medical.Net |
 "Omicron" - Google News 17h "Omicron" - Google News 17h |
| New Mississippi law bans COVID-19 vaccine mandates | News, Sports, Jobs - Nashua... |
| New Mississippi law bans COVID-19 vaccine mandates | News, Sports, Jobs Nashua Telegraph |
 "coronavirus news" - Google News 17h "coronavirus news" - Google News 17h |
| Pfizer's COVID pill is poised to be among the fastest-selling treatments of all time... |
| Pfizer's COVID pill is poised to be among the fastest-selling treatments of all time Boston Herald |
 "COVID" - Google News 17h "COVID" - Google News 17h |
| Covid-19 vaccines & therapies helped push medicines spending to $407B in 2021 - MedCity... |
| Covid-19 vaccines & therapies helped push medicines spending to $407B in 2021 MedCity News |
 "COVID" - Google News 17h "COVID" - Google News 17h |
| Disease X-19 Epidemiology from Michael_Novakhov (39 sites): Google Alert - Sars-Cov-2... |
| Life slowly returns to Hong Kong as Covid restrictions reduced ... Agriculture & livestock in the... |
 Disease X-19 from Michael_Novakhov (12 sites) 17h Disease X-19 from Michael_Novakhov (12 sites) 17h |
| Disease X-19 Regions from Michael_Novakhov (8 sites): Google Alert - coronavirus... |
| COVID-19 shots still work but researchers hunt new improvements ... Kathrin Jansen told a recent meeting... |
 Disease X-19 from Michael_Novakhov (12 sites) 17h Disease X-19 from Michael_Novakhov (12 sites) 17h |
| Disease X-19 Epidemiology from Michael_Novakhov (39 sites): Google Alert - covid-19... |
| Masks remain mandatory in hospitals, elderly care facilities and on international flights. Israel has... |
 Disease X-19 from Michael_Novakhov (12 sites) 17h Disease X-19 from Michael_Novakhov (12 sites) 17h |
| Disease X-19 Epidemiology from Michael_Novakhov (39 sites): Google Alert - coronavirus... |
| A new Mississippi law says the government cannot withhold services or refuse jobs to people who choose... |
 Disease X-19 from Michael_Novakhov (12 sites) 17h Disease X-19 from Michael_Novakhov (12 sites) 17h |
| Disease X-19 Regions from Michael_Novakhov (8 sites): Google Alert - coronavirus... |
| Shanghai authorities erected high fences outside the homes of residents who tested positive for COVID-19... |
 Disease X-19 from Michael_Novakhov (12 sites) 17h Disease X-19 from Michael_Novakhov (12 sites) 17h |
| Disease X-19 Epidemiology from Michael_Novakhov (39 sites): Google Alert - coronavirus... |
| A total of 16 holidaymakers, including a pregnant woman and a six-month-old baby, as well as three pets... |
 Disease X-19 from Michael_Novakhov (12 sites) 17h Disease X-19 from Michael_Novakhov (12 sites) 17h |
| Disease X-19 Epidemiology from Michael_Novakhov (39 sites): Google Alert - coronavirus... |
| APA! has also teamed up with Thrive Pet Healthcare where adopted pets can ... COVID-19 was 3rd leading... |
 Disease X-19 from Michael_Novakhov (12 sites) 17h Disease X-19 from Michael_Novakhov (12 sites) 17h |
| Disease X-19 Epidemiology from Michael_Novakhov (39 sites): Google Alert - Coronavirus... |
| ... and reproductive health, HIV/AIDS prevention and maternal and child health. ... "During the COVID-19... |
 Disease X-19 from Michael_Novakhov (12 sites) 17h Disease X-19 from Michael_Novakhov (12 sites) 17h |
| Disease X-19 Epidemiology from Michael_Novakhov (39 sites): Google Alert - coronavirus... |
| Yastrzemski is the first Giants player to test positive for COVID-19 this season. He will remain in Washington... |
 Disease X-19 from Michael_Novakhov (12 sites) 17h Disease X-19 from Michael_Novakhov (12 sites) 17h |
| Disease X-19 Epidemiology from Michael_Novakhov (39 sites): Google Alert - coronavirus... |
| LUCKNOW: Uttar Pradesh reported 213 new Covid cases and two deaths among Covid positive patients on Sunday,... |
 Disease X-19 from Michael_Novakhov (12 sites) 17h Disease X-19 from Michael_Novakhov (12 sites) 17h |
| Disease X-19 Regions from Michael_Novakhov (8 sites): Google Alert - coronavirus... |
| News' analysis represents broadest public review ever conducted of police misconduct cases in Erie and... |
 Disease X-19 from Michael_Novakhov (12 sites) 17h Disease X-19 from Michael_Novakhov (12 sites) 17h |
| Disease X-19 Epidemiology from Michael_Novakhov (39 sites): Google Alert - Coronavirus... |
| People, some wearing protective face masks, line up for PCR and Rapid Antigen COVID-19 coronavirus tests... |
 Disease X-19 from Michael_Novakhov (12 sites) 17h Disease X-19 from Michael_Novakhov (12 sites) 17h |
| COVID-19 hospitalizations increase by 12 in Maine - CentralMaine.com - Kennebec Journal... |
| COVID-19 hospitalizations increase by 12 in Maine - CentralMaine.com Kennebec Journal and Morning Sentinel |
 "Covid-19" - Google News 17h "Covid-19" - Google News 17h |
| Start your week smart: Ukraine, French elections, Tyson Fury, Covid-19, Orrin Hatch... |
| Start your week smart: Ukraine, French elections, Tyson Fury, Covid-19, Orrin Hatch - ABC17NEWS ABC17News.com |
 "Covid-19" - Google News 17h "Covid-19" - Google News 17h |
| Omicron variant dominant in Chandigarh, says health department - Hindustan Times |
| Omicron variant dominant in Chandigarh, says health department Hindustan Times |
 "Omicron" - Google News 17h "Omicron" - Google News 17h |
 | Covid-19: No further deaths and 366 new cases recorded - BBC |
| Covid-19: No further deaths and 366 new cases recorded BBC |
 "coronavirus news" - Google News 18h "coronavirus news" - Google News 18h |
| Second Covid-19 Vaccine Boosters: Getting It Now Versus Waiting Until Fall - Forbes |
| Second Covid-19 Vaccine Boosters: Getting It Now Versus Waiting Until Fall Forbes |
 "COVID" - Google News 18h "COVID" - Google News 18h |
| CDC: COVID 3rd-highest cause of death in 2021 - WHNT News 19 |
| CDC: COVID 3rd-highest cause of death in 2021 WHNT News 19 |
 "COVID" - Google News 18h "COVID" - Google News 18h |
| Disease X-19 and Security from Michael_Novakhov (10 sites): Google Alert - International... |
| He studies how bioscience technologies can be weaponized. "What COVID really brought into the light is... |
 Disease X-19 from Michael_Novakhov (12 sites) 18h Disease X-19 from Michael_Novakhov (12 sites) 18h |
| Disease X-19 Regions from Michael_Novakhov (8 sites): Google Alert - Coronavirus... |
| Ben Simmons is still being evaluated before the Nets determine whether he will make his season debut... |
 Disease X-19 from Michael_Novakhov (12 sites) 18h Disease X-19 from Michael_Novakhov (12 sites) 18h |
| Disease X-19 Regions from Michael_Novakhov (8 sites): Google Alert - coronavirus... |
| It also has expressed concerns that the U.S. might remove Iran's ... Stay informed daily on the latest... |
 Disease X-19 from Michael_Novakhov (12 sites) 18h Disease X-19 from Michael_Novakhov (12 sites) 18h |
| Disease X-19 and Security from Michael_Novakhov (10 sites): Google Alert - Coronavirus... |
| But first they rode their motorcycles in a 50-mile loop around the Southern Berkshires, also to honor... |
 Disease X-19 from Michael_Novakhov (12 sites) 18h Disease X-19 from Michael_Novakhov (12 sites) 18h |
| Disease X-19 and Security from Michael_Novakhov (10 sites): Google Alert - Coronavirus... |
| Survivors of a doomed migrant boat blamed the Lebanese navy on Sunday for ... and advice on COVID-19... |
 Disease X-19 from Michael_Novakhov (12 sites) 18h Disease X-19 from Michael_Novakhov (12 sites) 18h |
| Disease X-19 General Issues from Michael_Novakhov (5 sites): Google Alert - Covid-19:... |
| HILLSDALE, MI - The first fall semester of the COVID-19 pandemic saw mixed enrollment results for Michigan... |
 Disease X-19 from Michael_Novakhov (12 sites) 18h Disease X-19 from Michael_Novakhov (12 sites) 18h |
| Disease X-19 General Issues from Michael_Novakhov (5 sites): Google Alert - sars... |
| LISBON, Portugal — An overall ninefold increase in COVID-19 antibody ... according to data from the UK... |
 Disease X-19 from Michael_Novakhov (12 sites) 18h Disease X-19 from Michael_Novakhov (12 sites) 18h |
| Disease X-19 and Security from Michael_Novakhov (10 sites): Google Alert - Coronavirus... |
| Shanghai erects metal barriers in fight against COVID-19 ... Three U.S. Navy Sailors who served on the... |
 Disease X-19 from Michael_Novakhov (12 sites) 18h Disease X-19 from Michael_Novakhov (12 sites) 18h |
| Disease X-19 and Security from Michael_Novakhov (10 sites): Google Alert - Coronavirus... |
| Top Stories · More Stories · WPRI.com Video · More from WPRI.com · Pinpoint Weather 12 · Coronavirus:... |
 Disease X-19 from Michael_Novakhov (12 sites) 18h Disease X-19 from Michael_Novakhov (12 sites) 18h |
| Disease X-19 Regions from Michael_Novakhov (8 sites): Google Alert - coronavirus... |
| The White House Covid response coordinator Ashish Jha appeared to undercut the Biden administration's... |
 Disease X-19 from Michael_Novakhov (12 sites) 18h Disease X-19 from Michael_Novakhov (12 sites) 18h |
| Disease X-19 and Security from Michael_Novakhov (10 sites): Google Alert - Coronavirus... |
| Water Rescue · Mass. FFs, EMS providers help teen stuck in chest-deep mud · U.S. Navy plane crashes in... |
 Disease X-19 from Michael_Novakhov (12 sites) 18h Disease X-19 from Michael_Novakhov (12 sites) 18h |
| Disease X-19 General Issues from Michael_Novakhov (5 sites): Google Alert - Covid-19:... |
| Masks remain mandatory in hospitals, elderly care facilities and on international flights. Israel has... |
 Disease X-19 from Michael_Novakhov (12 sites) 18h Disease X-19 from Michael_Novakhov (12 sites) 18h |
| Disease X-19 and Security from Michael_Novakhov (10 sites): Google Alert - Coronavirus... |
| The White House Covid response coordinator Ashish Jha appeared to undercut the Biden administration's... |
 Disease X-19 from Michael_Novakhov (12 sites) 18h Disease X-19 from Michael_Novakhov (12 sites) 18h |
| Disease X-19 Regions from Michael_Novakhov (8 sites): Google Alert - Coronavirus... |
| The citywide 7-day positivity rate for COVID-19 infections grew to 5.79% on Friday, April 22 — a number... |
 Disease X-19 from Michael_Novakhov (12 sites) 18h Disease X-19 from Michael_Novakhov (12 sites) 18h |
| Disease X-19 Regions from Michael_Novakhov (8 sites): Google Alert - Coronavirus... |
| That conversation is completely not occurring," said Brooklyn mother Melissa Keaton. Two years after... |
 Disease X-19 from Michael_Novakhov (12 sites) 18h Disease X-19 from Michael_Novakhov (12 sites) 18h |
| Disease X-19 and Security from Michael_Novakhov (10 sites): Google Alert - Coronavirus... |
| A historic trial within the ranks of the U.S. military has ended with the first-ever conviction of an... |
 Disease X-19 from Michael_Novakhov (12 sites) 18h Disease X-19 from Michael_Novakhov (12 sites) 18h |
| Disease X-19 General Issues from Michael_Novakhov (5 sites): Google Alert - sars... |
| Aria Bendix / Coronavirus / Updated 11 hours ago ... actually a very effective way of preventing acquisition... |
 Disease X-19 from Michael_Novakhov (12 sites) 18h Disease X-19 from Michael_Novakhov (12 sites) 18h |
| Disease X-19 General Issues from Michael_Novakhov (5 sites): Google Alert - coronavirus:... |
| 31, though orders could be extended at that time based on the number of coronavirus cases. An outdoor... |
 Disease X-19 from Michael_Novakhov (12 sites) 18h Disease X-19 from Michael_Novakhov (12 sites) 18h |
 | What experts told me to do after my positive COVID-19 at-home test - San Antonio... |
| What experts told me to do after my positive COVID-19 at-home test San Antonio Current |
 "Covid-19" - Google News 18h "Covid-19" - Google News 18h |
| China able to beat Omicron - Chinadaily.com.cn - China Daily |
| China able to beat Omicron - Chinadaily.com.cn China Daily |
 "Omicron" - Google News 18h "Omicron" - Google News 18h |
| Mike Yastrzemski tests positive for COVID-19 - MLB.com |
| Mike Yastrzemski tests positive for COVID-19 MLB.com |
 "coronavirus news" - Google News 18h "coronavirus news" - Google News 18h |
| COVID shots still work but researchers hunt new improvements - WXYZ 7 Action News... |
| COVID shots still work but researchers hunt new improvements WXYZ 7 Action News Detroit |
 "coronavirus news" - Google News 18h "coronavirus news" - Google News 18h |
| WHO recommends COVID-19 drug and urges transparency around pricing - UN News |
| WHO recommends COVID-19 drug and urges transparency around pricing UN News |
 "coronavirus news" - Google News 18h "coronavirus news" - Google News 18h |
| Learning to Live with COVID - Dan's Papers |
| Learning to Live with COVID Dan's Papers |
 "COVID" - Google News 18h "COVID" - Google News 18h |
| The pandemic inspired a cartoonist to explore their Wuhanese roots and queer identity... |
| The pandemic inspired a cartoonist to explore their Wuhanese roots and queer identity Wisconsin Public... |
 "covid -19 origins" - Google News 18h "covid -19 origins" - Google News 18h |
| N.J. reports 1527 COVID cases, 2 new deaths. State falls to 8th most deaths per capita... |
| N.J. reports 1527 COVID cases, 2 new deaths. State falls to 8th most deaths per capita in U.S. NJ.com |
 "COVID" - Google News 19h "COVID" - Google News 19h |
| Researchers testing combination shots as a possible new kind of COVID booster - PBS... |
| Researchers testing combination shots as a possible new kind of COVID booster PBS NewsHour |
 "COVID" - Google News 19h "COVID" - Google News 19h |
| Disease X-19 Publications from Michael_Novakhov (5 sites): Google Alert - coronavirus... |
| On Saturday Musk admitted on Twitter that he asked Bill Gates, ... safe medicines that help combat quick-spreading... |
 Disease X-19 from Michael_Novakhov (12 sites) 19h Disease X-19 from Michael_Novakhov (12 sites) 19h |
| Disease X-19 Publications from Michael_Novakhov (5 sites): Google Alert - coronavirus... |
| Are journalism and Twitter headed for splitsville? by Joe Ferullo, opinion contributor - 04/24/22 12:30... |
 Disease X-19 from Michael_Novakhov (12 sites) 19h Disease X-19 from Michael_Novakhov (12 sites) 19h |
| Disease X-19 Regions from Michael_Novakhov (8 sites): Google Alert - coronavirus... |
| Italy reported 56263 new COVID-19 related cases on Sunday, against 70520 the day before, the health ministry... |
 Disease X-19 from Michael_Novakhov (12 sites) 19h Disease X-19 from Michael_Novakhov (12 sites) 19h |
| Disease X-19 Regions from Michael_Novakhov (8 sites): Google Alert - coronavirus... |
| Officials say 98 African migrants and refugees rescued and five remain missing after boats trying to... |
 Disease X-19 from Michael_Novakhov (12 sites) 19h Disease X-19 from Michael_Novakhov (12 sites) 19h |
| Disease X-19 Regions from Michael_Novakhov (8 sites): Google Alert - coronavirus... |
| Customer Chiara Valenzano takes pictures of her dishes as she has lunch at This Is Not a Sushi Bar restaurant,... |
 Disease X-19 from Michael_Novakhov (12 sites) 19h Disease X-19 from Michael_Novakhov (12 sites) 19h |
 | COVID-19 shots still work but researchers hunt new improvements - Florida Politics |
| COVID-19 shots still work but researchers hunt new improvements Florida Politics |
 "Covid-19" - Google News 19h "Covid-19" - Google News 19h |
 | New Mississippi law bans COVID-19 vaccine mandates - Clarion Ledger |
| New Mississippi law bans COVID-19 vaccine mandates Clarion Ledger |
 "Covid-19" - Google News 19h "Covid-19" - Google News 19h |
| Empty classrooms and quiet hallways: California's rural far north grapples with declining... |
| Empty classrooms and quiet hallways: California's rural far north grapples with declining enrollment Capital... |
 "covid -19 origins" - Google News 19h "covid -19 origins" - Google News 19h |
| CDC Report: COVID-19 Was Third Leading Cause of Death in 2021 - U.S. News & World... |
| CDC Report: COVID-19 Was Third Leading Cause of Death in 2021 U.S. News & World Report |
 "coronavirus news" - Google News 19h "coronavirus news" - Google News 19h |
 | White House Advisor Calls For 'Caution, But Not Overreacting' As Covid Cases Jump... |
| White House Advisor Calls For 'Caution, But Not Overreacting' As Covid Cases Jump 50% Forbes |
 "COVID" - Google News 19h "COVID" - Google News 19h |
 | New York Is Failing Its COVID-Orphaned Kids - New York Magazine |
| New York Is Failing Its COVID-Orphaned Kids New York Magazine |
 "COVID" - Google News 19h "COVID" - Google News 19h |
 | Giants' Mike Yastrzemski placed on COVID IL after positive test - NBC Sports |
| Giants' Mike Yastrzemski placed on COVID IL after positive test NBC Sports |
 "COVID" - Google News 19h "COVID" - Google News 19h |
 | Bucks' Luca Vildoza: Dealing with non-COVID illness - CBS Sports |
| Bucks' Luca Vildoza: Dealing with non-COVID illness CBS Sports |
 "COVID" - Google News 19h "COVID" - Google News 19h |
| Disease X-19 Epidemiology from Michael_Novakhov (39 sites): Google Alert - Covid-19:... |
| During the development of this Preimplantation Genetic Screening research report, the driving factors... |
 Disease X-19 from Michael_Novakhov (12 sites) 19h Disease X-19 from Michael_Novakhov (12 sites) 19h |
| Disease X-19 Epidemiology from Michael_Novakhov (39 sites): Google Alert - coronavirus... |
| THE STUDY. The researchers used the BAMSE project, the Swedish abbreviation for Children, Allergy, Milieu,... |
 Disease X-19 from Michael_Novakhov (12 sites) 19h Disease X-19 from Michael_Novakhov (12 sites) 19h |
| Disease X-19 Epidemiology from Michael_Novakhov (39 sites): Google Alert - coronavirus... |
| ... the Swedish abbreviation for Children, Allergy, Milieu, Stockholm, Epidemiology, to identify cases... |
 Disease X-19 from Michael_Novakhov (12 sites) 19h Disease X-19 from Michael_Novakhov (12 sites) 19h |
| Disease X-19 and Security from Michael_Novakhov (10 sites): Google Alert - coronavirus... |
| BJP leader Kirit Somaiya said on Sunday that the Thackeray government was using police like the mafia... |
 Disease X-19 from Michael_Novakhov (12 sites) 19h Disease X-19 from Michael_Novakhov (12 sites) 19h |
| Disease X-19 Epidemiology from Michael_Novakhov (39 sites): Google Alert - coronavirus... |
| "Children are equally susceptible to COVID as adults,'' said Dr. Suresh Kumar Panuganti, lead consultant... |
 Disease X-19 from Michael_Novakhov (12 sites) 19h Disease X-19 from Michael_Novakhov (12 sites) 19h |
| Here are the latest COVID-19 numbers in Pennsylvania - Sunday April 24 - WNEP Scranton/Wilkes-Barre |
| Here are the latest COVID-19 numbers in Pennsylvania - Sunday April 24 WNEP Scranton/Wilkes-Barre |
 "COVID-19" - Google News 19h "COVID-19" - Google News 19h |
 | Covid-19 case rates increased in all Greater Cleveland counties over last 7 days... |
| Covid-19 case rates increased in all Greater Cleveland counties over last 7 days cleveland.com |
 "COVID-19" - Google News 19h "COVID-19" - Google News 19h |
| Macron vs Le Pen in French presidential election runoff - News-Gazette |
| Macron vs Le Pen in French presidential election runoff News-Gazette |
 "coronavirus news" - Google News 20h "coronavirus news" - Google News 20h |
| Disease X-19 General Issues from Michael_Novakhov (5 sites): Google Alert - sars... |
| The feds drop the COVID-19 testing requirements for travellers, ... JAMA: Association of Short-term Air... |
 Disease X-19 from Michael_Novakhov (12 sites) 20h Disease X-19 from Michael_Novakhov (12 sites) 20h |
| Disease X-19 General Issues from Michael_Novakhov (5 sites): Google Alert - sars... |
| The pill, S-217622, "demonstrated rapid clearance of the infectious SARS-CoV-2 virus," Shionogi said... |
 Disease X-19 from Michael_Novakhov (12 sites) 20h Disease X-19 from Michael_Novakhov (12 sites) 20h |
| Disease X-19 Epidemiology from Michael_Novakhov (39 sites): Google Alert - Sars Cov-2... |
| Risk for death around four times higher from COVID-19 than flu, ... Serological Evidence of SARS-CoV-2... |
 Disease X-19 from Michael_Novakhov (12 sites) 20h Disease X-19 from Michael_Novakhov (12 sites) 20h |
| Disease X-19 Epidemiology from Michael_Novakhov (39 sites): Google Alert - coronavirus... |
| But the challenge will come once the weather starts to cool and immunity against infection starts to... |
 Disease X-19 from Michael_Novakhov (12 sites) 20h Disease X-19 from Michael_Novakhov (12 sites) 20h |
| Disease X-19 Epidemiology from Michael_Novakhov (39 sites): Google Alert - coronavirus... |
| COVID-19: Resources & Latest News. WTVA 9 News; Download News & Weather Apps ... Jan 25, 2022.... |
 Disease X-19 from Michael_Novakhov (12 sites) 20h Disease X-19 from Michael_Novakhov (12 sites) 20h |
| Disease X-19 General Issues from Michael_Novakhov (5 sites): Google Alert - sars... |
| A new study shows that waiting longer intervals between COVID-19 vaccines ... SIREN study (SARS-CoV-2... |
 Disease X-19 from Michael_Novakhov (12 sites) 20h Disease X-19 from Michael_Novakhov (12 sites) 20h |
| Disease X-19 Epidemiology from Michael_Novakhov (39 sites): Google Alert - coronavirus... |
| A new study shows that waiting longer intervals between COVID-19 vaccines can boost antibodies by up... |
 Disease X-19 from Michael_Novakhov (12 sites) 20h Disease X-19 from Michael_Novakhov (12 sites) 20h |
| Disease X-19 Epidemiology from Michael_Novakhov (39 sites): Google Alert - coronavirus... |
| World Immunization week (April 24-30) reminds me how very fortunate I am to live where ample vaccines... |
 Disease X-19 from Michael_Novakhov (12 sites) 20h Disease X-19 from Michael_Novakhov (12 sites) 20h |
| Disease X-19 Epidemiology from Michael_Novakhov (39 sites): Google Alert - coronavirus... |
| But some people -- those with severely weakened immune systems -- need more doses up-front for a better... |
 Disease X-19 from Michael_Novakhov (12 sites) 20h Disease X-19 from Michael_Novakhov (12 sites) 20h |
| Disease X-19 Publications from Michael_Novakhov (5 sites): Google Alert - new york... |
| She spent two weeks at Morgan Stanley Children's Hospital in New York City after undergoing open heart... |
 Disease X-19 from Michael_Novakhov (12 sites) 20h Disease X-19 from Michael_Novakhov (12 sites) 20h |
| Disease X-19 General Issues from Michael_Novakhov (5 sites): Google Alert - sars... |
| The COVID pill, S-217622, "demonstrated rapid clearance of the infectious SARS-CoV-2 virus in Phase-2b... |
 Disease X-19 from Michael_Novakhov (12 sites) 20h Disease X-19 from Michael_Novakhov (12 sites) 20h |
| Disease X-19 Publications from Michael_Novakhov (5 sites): Google Alert - new york... |
| ... switch to online classes and scale back large gatherings in response to upticks in coronavirus infections.... |
 Disease X-19 from Michael_Novakhov (12 sites) 20h Disease X-19 from Michael_Novakhov (12 sites) 20h |
| Disease X-19 Epidemiology from Michael_Novakhov (39 sites): Google Alert - coronavirus... |
| "Public needs to be made aware that once the immunity level comes down and especially among those who... |
 Disease X-19 from Michael_Novakhov (12 sites) 20h Disease X-19 from Michael_Novakhov (12 sites) 20h |
| Disease X-19 General Issues from Michael_Novakhov (5 sites): Google Alert - sars... |
| Moderna and Pfizer are testing 2-in-1 Covid-19 protection that they ... 46 people who got SARS-CoV-2... |
 Disease X-19 from Michael_Novakhov (12 sites) 20h Disease X-19 from Michael_Novakhov (12 sites) 20h |
 | COVID-19 shots still work but researchers hunt new improvements - WPTV News Channel... |
| COVID-19 shots still work but researchers hunt new improvements WPTV News Channel 5 West Palm |
 "Covid-19" - Google News 20h "Covid-19" - Google News 20h |
 | Crunching the COVID-19 Numbers: Hospitalizations and deaths still low as BA.2 variant... |
| Crunching the COVID-19 Numbers: Hospitalizations and deaths still low as BA.2 variant keeps spreading... |
 "COVID-19" - Google News 20h "COVID-19" - Google News 20h |
 | Correlation Between Mask Compliance and COVID-19 Outcomes in Europe |
| submitted by /u/MahtMan [link] [comments] |
| |
 | Montelukast Inhibits Platelet Activation Induced by Plasma From COVID-19 Patients |
| submitted by /u/PrincessGambit [link] [comments] |
| |
 | Platelet activation by SARS-CoV-2 implicates the release of active tissue factor... |
| submitted by /u/PrincessGambit [link] [comments] |
| |
| Cook Islands records first COVID death - Medical Xpress |
| Cook Islands records first COVID death Medical Xpress |
 "coronavirus news" - Google News 20h "coronavirus news" - Google News 20h |
| Disease X-19 General Issues from Michael_Novakhov (5 sites): Google Alert - Latest... |
| Data from the Zoe tracker app has shown that changes to the skin, fingers, toes, mouth and tongue can... |
 Disease X-19 from Michael_Novakhov (12 sites) 20h Disease X-19 from Michael_Novakhov (12 sites) 20h |
| Disease X-19 General Issues from Michael_Novakhov (5 sites): Google Alert - Latest... |
| The number of new COVID cases in Pennsylvania, along with deaths and hospitalizations from the coronavirus... |
 Disease X-19 from Michael_Novakhov (12 sites) 20h Disease X-19 from Michael_Novakhov (12 sites) 20h |
| Disease X-19 General Issues from Michael_Novakhov (5 sites): Google Alert - Latest... |
| The latest figures come a day after the county reported another 2,056 infections Friday, raising the... |
 Disease X-19 from Michael_Novakhov (12 sites) 20h Disease X-19 from Michael_Novakhov (12 sites) 20h |
| Disease X-19 General Issues from Michael_Novakhov (5 sites): Google Alert - Latest... |
| COVID-19 vaccinations are at a critical juncture as companies test whether ... Updating the vaccine recipe... |
 Disease X-19 from Michael_Novakhov (12 sites) 20h Disease X-19 from Michael_Novakhov (12 sites) 20h |
| Disease X-19 General Issues from Michael_Novakhov (5 sites): Google Alert - Latest... |
| The latest coronavirus news from Canada and around the world Sunday. This file will be updated throughout... |
 Disease X-19 from Michael_Novakhov (12 sites) 20h Disease X-19 from Michael_Novakhov (12 sites) 20h |
| Disease X-19 General Issues from Michael_Novakhov (5 sites): Google Alert - coronavirus:... |
| The latest coronavirus news from Canada and around the world Sunday. This file will be updated throughout... |
 Disease X-19 from Michael_Novakhov (12 sites) 20h Disease X-19 from Michael_Novakhov (12 sites) 20h |
| Disease X-19 General Issues from Michael_Novakhov (5 sites): Google Alert - coronavirus:... |
| Across the country, many cities and provinces have enforced some version of a lockdown in an attempt... |
 Disease X-19 from Michael_Novakhov (12 sites) 20h Disease X-19 from Michael_Novakhov (12 sites) 20h |
| Disease X-19 General Issues from Michael_Novakhov (5 sites): Google Alert - Latest... |
| Across the country, many cities and provinces have enforced some version of a lockdown in an attempt... |
 Disease X-19 from Michael_Novakhov (12 sites) 20h Disease X-19 from Michael_Novakhov (12 sites) 20h |
| Disease X-19 General Issues from Michael_Novakhov (5 sites): Google Alert - coronavirus:... |
| Investors are gearing up for a week of big ticket economic data, including a first look at economic growth... |
 Disease X-19 from Michael_Novakhov (12 sites) 20h Disease X-19 from Michael_Novakhov (12 sites) 20h |
| Disease X-19 General Issues from Michael_Novakhov (5 sites): Google Alert - Covid-19:... |
| ... 2022, in a report from the county's Department of Public Health are the latest illustration of how... |
 Disease X-19 from Michael_Novakhov (12 sites) 20h Disease X-19 from Michael_Novakhov (12 sites) 20h |
| Gottlieb sees 'transition year' for COVID - The Hill |
| Gottlieb sees 'transition year' for COVID The Hill |
 "COVID" - Google News 20h "COVID" - Google News 20h |
| Rays Place Jeffrey Springs On Covid-IL, Reinstate Yandy Diaz - MLB Trade Rumors |
| Rays Place Jeffrey Springs On Covid-IL, Reinstate Yandy Diaz MLB Trade Rumors |
 "COVID" - Google News 20h "COVID" - Google News 20h |
 | COVID-19 vaccine hesitancy in autism caregivers decreased over time - Healio |
| COVID-19 vaccine hesitancy in autism caregivers decreased over time Healio |
 "COVID-19" - Google News 20h "COVID-19" - Google News 20h |
| Another COVID-19 wave 'almost baked in' for the fall: top Ont. science adviser –... |
| Another COVID-19 wave 'almost baked in' for the fall: top Ont. science adviser – KION546 KION |
 "COVID-19" - Google News 20h "COVID-19" - Google News 20h |
| Overdoses, not COVID-19, drive spike in LA homeless deaths - WesternSlopeNow |
| Overdoses, not COVID-19, drive spike in LA homeless deaths WesternSlopeNow |
 "COVID-19" - Google News 20h "COVID-19" - Google News 20h |
| First SF Giants player this season tests positive for COVID-19 - The Mercury News |
| First SF Giants player this season tests positive for COVID-19 The Mercury News |
 "coronavirus news" - Google News 21h "coronavirus news" - Google News 21h |
| DOH adds 1,100 new COVID cases; deaths up 89 percent in last week - Sunbury Daily... |
| DOH adds 1,100 new COVID cases; deaths up 89 percent in last week Sunbury Daily Item |
 "COVID" - Google News 21h "COVID" - Google News 21h |
| Mike Yastrzemski Tests Positive For Covid-19 - MLB Trade Rumors |
| Mike Yastrzemski Tests Positive For Covid-19 MLB Trade Rumors |
 "COVID" - Google News 21h "COVID" - Google News 21h |
| US stockpiles covid treatment - Northwest Arkansas Democrat-Gazette |
| US stockpiles covid treatment Northwest Arkansas Democrat-Gazette |
 "COVID" - Google News 21h "COVID" - Google News 21h |
| Educational grace bills would consider COVID's impact on learning - The Morning Sun |
| Educational grace bills would consider COVID's impact on learning The Morning Sun |
 "COVID" - Google News 21h "COVID" - Google News 21h |
 | San Francisco Giants place OF Mike Yastrzemski on COVID-19 injured list - ESPN |
| San Francisco Giants place OF Mike Yastrzemski on COVID-19 injured list ESPN |
 "COVID-19" - Google News 21h "COVID-19" - Google News 21h |
 | St. Peter's back to restricted visitation amid COVID-19 increase - Times Union |
| St. Peter's back to restricted visitation amid COVID-19 increase Times Union |
 "COVID-19" - Google News 21h "COVID-19" - Google News 21h |
 | COVID shots still work but researchers hunt new improvements - Arizona's Family |
| COVID shots still work but researchers hunt new improvements Arizona's Family |
 "COVID-19" - Google News 21h "COVID-19" - Google News 21h |
| Start your week smart: Ukraine, French elections, Tyson Fury, Covid-19, Orrin Hatch... |
| Start your week smart: Ukraine, French elections, Tyson Fury, Covid-19, Orrin Hatch Henry Herald |
 "COVID-19" - Google News 21h "COVID-19" - Google News 21h |
 | BA.2 blamed for rising COVID-19 cases in LA County - CBS News |
| BA.2 blamed for rising COVID-19 cases in LA County CBS News |
 "COVID-19" - Google News 21h "COVID-19" - Google News 21h |
| Disease X-19 Epidemiology from Michael_Novakhov (39 sites): Google Alert - coronavirus... |
| ... Senior Covid inoculations, per HHS, saving senior lives not returning to nursing homes, educators... |
 Disease X-19 from Michael_Novakhov (12 sites) 21h Disease X-19 from Michael_Novakhov (12 sites) 21h |
| Disease X-19 Epidemiology from Michael_Novakhov (39 sites): Google Alert - coronavirus... |
| Investors are gearing up for a week of big ticket economic data, including a first look at economic growth... |
 Disease X-19 from Michael_Novakhov (12 sites) 21h Disease X-19 from Michael_Novakhov (12 sites) 21h |
| Disease X-19 Epidemiology from Michael_Novakhov (39 sites): Google Alert - Coronavirus,... |
| If you have a question for the MTA about subways, buses, commuter rails and more, email askthemta[@]amny.com.... |
 Disease X-19 from Michael_Novakhov (12 sites) 21h Disease X-19 from Michael_Novakhov (12 sites) 21h |
| Disease X-19 Epidemiology from Michael_Novakhov (39 sites): Google Alert - coronavirus... |
| Coronavirus constraints had severely limited attendance on the past two occasions. This year major Jewish,... |
 Disease X-19 from Michael_Novakhov (12 sites) 21h Disease X-19 from Michael_Novakhov (12 sites) 21h |
| Disease X-19 Epidemiology from Michael_Novakhov (39 sites): Google Alert - coronavirus... |
| During this COCA Call, presenters will discuss post-COVID conditions (PCC), an umbrella term for the... |
 Disease X-19 from Michael_Novakhov (12 sites) 21h Disease X-19 from Michael_Novakhov (12 sites) 21h |
| Disease X-19 Publications from Michael_Novakhov (5 sites): Google Alert - Coronavirus... |
| Most people hit early with coronavirus lost their smell. ... Loss of smell and taste was a distinguishing... |
 Disease X-19 from Michael_Novakhov (12 sites) 21h Disease X-19 from Michael_Novakhov (12 sites) 21h |
| Disease X-19 Epidemiology from Michael_Novakhov (39 sites): Google Alert - coronavirus... |
| Nursing homes close. On Thursday, the American Health Care Association and National Center for Assisted... |
 Disease X-19 from Michael_Novakhov (12 sites) 21h Disease X-19 from Michael_Novakhov (12 sites) 21h |
| Disease X-19 Epidemiology from Michael_Novakhov (39 sites): Google Alert - coronavirus... |
| The numbers used in this story can be found in COVID-19 of the Ontario Department of Health. Daily epidemiology... |
 Disease X-19 from Michael_Novakhov (12 sites) 21h Disease X-19 from Michael_Novakhov (12 sites) 21h |
| Disease X-19 Epidemiology from Michael_Novakhov (39 sites): Google Alert - coronavirus... |
| ... tried to ram patrol car, officer fired shots in Trenton. Updated Jan 17, 2022. Cuomo's exit isn't... |
 Disease X-19 from Michael_Novakhov (12 sites) 21h Disease X-19 from Michael_Novakhov (12 sites) 21h |
| Disease X-19 Epidemiology from Michael_Novakhov (39 sites): Google Alert - coronavirus... |
| COVID-19 vaccinations are at a critical juncture as companies test whether ... Vaccination triggers development... |
 Disease X-19 from Michael_Novakhov (12 sites) 21h Disease X-19 from Michael_Novakhov (12 sites) 21h |
| Disease X-19 Regions from Michael_Novakhov (8 sites): Google Alert - coronavirus... |
| The tiny South Pacific nation of the Cook Islands reported its first coronavirus-related death Sunday,... |
 Disease X-19 from Michael_Novakhov (12 sites) 21h Disease X-19 from Michael_Novakhov (12 sites) 21h |
| Disease X-19 Regions from Michael_Novakhov (8 sites): Google Alert - coronavirus... |
| Israel is considering reducing viral testing at Ben Gurion Airport in light of reduced rates of Covid-19,... |
 Disease X-19 from Michael_Novakhov (12 sites) 21h Disease X-19 from Michael_Novakhov (12 sites) 21h |
| Disease X-19 Regions from Michael_Novakhov (8 sites): Google Alert - coronavirus... |
| Italian politicians, religious figures join iftar in Brescia ... one of the cities hardest hit by the... |
 Disease X-19 from Michael_Novakhov (12 sites) 21h Disease X-19 from Michael_Novakhov (12 sites) 21h |
| Ontario COVID-19 news: province reports 6 new deaths; ICU occupancy remains stable... |
| Ontario COVID-19 news: province reports 6 new deaths; ICU occupancy remains stable CP24 Toronto's Breaking... |
 "coronavirus news" - Google News 21h "coronavirus news" - Google News 21h |
| Cleveland Guardians activate Owen Miller from COVID list; Konner Pilkington optioned... |
| Cleveland Guardians activate Owen Miller from COVID list; Konner Pilkington optioned to Triple-A cleveland.com |
 "COVID" - Google News 21h "COVID" - Google News 21h |
| Public transportation mask mandate lifted, as COVID-19 case counts in region remain... |
| Public transportation mask mandate lifted, as COVID-19 case counts in region remain low Wicked Local |
 "COVID" - Google News 21h "COVID" - Google News 21h |
| COVID shots still work, but researchers hunt new improvements - Fortune |
| COVID shots still work, but researchers hunt new improvements Fortune |
 "COVID" - Google News 21h "COVID" - Google News 21h |
| COVID-19 Presenting as a Seizure: A Kenyan Case Report - Cureus |
| COVID-19 Presenting as a Seizure: A Kenyan Case Report Cureus |
 "Covid-19" - Google News 21h "Covid-19" - Google News 21h |
 | Rays' Jeffrey Springs: Goes on COVID-19-related IL - CBS Sports |
| Rays' Jeffrey Springs: Goes on COVID-19-related IL CBS Sports |
 "COVID-19" - Google News 21h "COVID-19" - Google News 21h |
| Disease X-19 Regions from Michael_Novakhov (8 sites): Google Alert - Coronavirus... |
| COVID-19 vaccinations are at a critical juncture as companies test whether new approaches like combination... |
 Disease X-19 from Michael_Novakhov (12 sites) 22h Disease X-19 from Michael_Novakhov (12 sites) 22h |
| Disease X-19 Regions from Michael_Novakhov (8 sites): Google Alert - Coronavirus... |
| MTA conductor Tramell Thompson joined 'Fox & Friends' to discuss the push against the policy as Brooklyn... |
 Disease X-19 from Michael_Novakhov (12 sites) 22h Disease X-19 from Michael_Novakhov (12 sites) 22h |
| Disease X-19 Regions from Michael_Novakhov (8 sites): Google Alert - Coronavirus... |
| China reported 21,796 new community-transmitted COVID-19 infections on Sunday, with the vast majority... |
 Disease X-19 from Michael_Novakhov (12 sites) 22h Disease X-19 from Michael_Novakhov (12 sites) 22h |
| Disease X-19 Regions from Michael_Novakhov (8 sites): Google Alert - coronavirus... |
| TEHRAN – A team of Iranian researchers has managed to register a worldwide patent for an anti-coronavirus... |
 Disease X-19 from Michael_Novakhov (12 sites) 22h Disease X-19 from Michael_Novakhov (12 sites) 22h |
| Singapore cannot let valuable lessons from COVID-19, 'for which we have paid dearly',... |
| Singapore cannot let valuable lessons from COVID-19, 'for which we have paid dearly', go to waste: PM... |
 "coronavirus news" - Google News 22h "coronavirus news" - Google News 22h |
| COVID-19 hospitalizations increase by 12 in Maine - Portland Press Herald - Press... |
| COVID-19 hospitalizations increase by 12 in Maine - Portland Press Herald Press Herald |
 "COVID-19" - Google News 22h "COVID-19" - Google News 22h |
 | While other schools struggle, Hillsdale College enrollment has surged during COVID-19.... |
| While other schools struggle, Hillsdale College enrollment has surged during COVID-19. Here's why MLive.com |
 "COVID-19" - Google News 22h "COVID-19" - Google News 22h |
 | COVID shots still work but researchers hunt new improvements - WTVG |
| COVID shots still work but researchers hunt new improvements WTVG |
 "COVID-19" - Google News 22h "COVID-19" - Google News 22h |
| New and Improved; Omicron Sub-Subvariants - http://hamodia.com |
| New and Improved; Omicron Sub-Subvariants http://hamodia.com |
 "Omicron" - Google News 22h "Omicron" - Google News 22h |
| Shanghai, China, to Northeast USA and Puerto Rico: New impacts of Omicron BA.2 -... |
| Shanghai, China, to Northeast USA and Puerto Rico: New impacts of Omicron BA.2 IDSA |
 "Omicron" - Google News 22h "Omicron" - Google News 22h |
| Opinion | The Tennessee Law Making School Board Culture Wars Even Worse - The New... |
| Opinion | The Tennessee Law Making School Board Culture Wars Even Worse The New York Times |
 "covid -19 origins" - Google News 22h "covid -19 origins" - Google News 22h |
| Disease X-19 General Issues from Michael_Novakhov (5 sites): Google Alert - coronavirus:... |
| Here's the latest news from the pandemic. Shanghai reports a record daily death tally in current outbreak;... |
 Disease X-19 from Michael_Novakhov (12 sites) 22h Disease X-19 from Michael_Novakhov (12 sites) 22h |
| How COVID Changed How We Eat - Sierra Club |
| How COVID Changed How We Eat Sierra Club |
 "COVID" - Google News 22h "COVID" - Google News 22h |
| Educational grace bills would consider COVID's impact on learning - The Macomb Daily |
| Educational grace bills would consider COVID's impact on learning The Macomb Daily |
 "COVID" - Google News 22h "COVID" - Google News 22h |
 | Lakeshore baseball honors 2020 seniors whose season was canceled by COVID-19 - NOLA.com |
| Lakeshore baseball honors 2020 seniors whose season was canceled by COVID-19 NOLA.com |
 "Covid-19" - Google News 22h "Covid-19" - Google News 22h |
 | Why the WHO took two years to say COVID is airborne - Nature.com |
| Why the WHO took two years to say COVID is airborne Nature.com |
 "Covid-19" - Google News 22h "Covid-19" - Google News 22h |
 | White House official: US must respond to rising COVID-19 cases 'with care and caution,... |
| White House official: US must respond to rising COVID-19 cases 'with care and caution, but not overreacting' The... |
 "COVID-19" - Google News 22h "COVID-19" - Google News 22h |
| Disease X-19 Epidemiology from Michael_Novakhov (39 sites): Google Alert - coronavirus... |
| Despite success in preventing serious illness and death, there's growing pressure to develop vaccines... |
 Disease X-19 from Michael_Novakhov (12 sites) 23h Disease X-19 from Michael_Novakhov (12 sites) 23h |
| Disease X-19 Epidemiology from Michael_Novakhov (39 sites): Google Alert - Coronavirus... |
| Meanwhile, Volunteers and low-level government workers in Shanghai have ... bans father from taking son... |
 Disease X-19 from Michael_Novakhov (12 sites) 23h Disease X-19 from Michael_Novakhov (12 sites) 23h |
| Disease X-19 Epidemiology from Michael_Novakhov (39 sites): Google Alert - coronavirus... |
| The latest statistics mean this weekend has seen no deaths recorded across both Saturday and Sunday.... |
 Disease X-19 from Michael_Novakhov (12 sites) 23h Disease X-19 from Michael_Novakhov (12 sites) 23h |
| Disease X-19 Epidemiology from Michael_Novakhov (39 sites): Google Alert - Coronavirus... |
| Healthcare workers are among the first to brook the wearing of full personal ... and transitioning to... |
 Disease X-19 from Michael_Novakhov (12 sites) 23h Disease X-19 from Michael_Novakhov (12 sites) 23h |
| Disease X-19 Epidemiology from Michael_Novakhov (39 sites): Google Alert - Covid-19:... |
| BFA's takeaways add confidence to global cooperation amid COVID-19. April 23, 2022. Defying headwinds... |
 Disease X-19 from Michael_Novakhov (12 sites) 23h Disease X-19 from Michael_Novakhov (12 sites) 23h |
| Disease X-19 Epidemiology from Michael_Novakhov (39 sites): Google Alert - Covid-19:... |
| This recently released analysis throws light on critical market ... NOTE: Our team is studying Covid-19... |
 Disease X-19 from Michael_Novakhov (12 sites) 23h Disease X-19 from Michael_Novakhov (12 sites) 23h |
| Disease X-19 Epidemiology from Michael_Novakhov (39 sites): Google Alert - coronavirus... |
| COVID-19 vaccines still offer strong protection against severe illness and death, but Moderna and Pfizer... |
 Disease X-19 from Michael_Novakhov (12 sites) 23h Disease X-19 from Michael_Novakhov (12 sites) 23h |
| Disease X-19 Epidemiology from Michael_Novakhov (39 sites): Google Alert - coronavirus... |
| What will bring us together? Fighting the virus didn't. Herd immunity is no longer a realistic hope.... |
 Disease X-19 from Michael_Novakhov (12 sites) 23h Disease X-19 from Michael_Novakhov (12 sites) 23h |
| Disease X-19 Epidemiology from Michael_Novakhov (39 sites): Google Alert - coronavirus... |
| COVID mutation over the past months, coupled with a waning immunity among the older population, increases... |
 Disease X-19 from Michael_Novakhov (12 sites) 23h Disease X-19 from Michael_Novakhov (12 sites) 23h |
| Israel lifts indoor mask mandate as coronavirus cases drop - The Associated Press |
| Israel lifts indoor mask mandate as coronavirus cases drop The Associated Press |
 "coronavirus news" - Google News 23h "coronavirus news" - Google News 23h |
| OC ICUs' COVID-19 cases far from surge highs, but is it too soon to get hopes up?... |
| OC ICUs' COVID-19 cases far from surge highs, but is it too soon to get hopes up? OCRegister |
 "COVID" - Google News 23h "COVID" - Google News 23h |
| Covid Will Boost The Economy, And It Can Also Boost Your Career—Says Economist Matthew... |
| Covid Will Boost The Economy, And It Can Also Boost Your Career—Says Economist Matthew E. Kahn Forbes |
 "COVID" - Google News 23h "COVID" - Google News 23h |
 | Post-COVID-19 Multisystem Inflammatory Syndrome in Children and Adults: What Happens... |
| Post-COVID-19 Multisystem Inflammatory Syndrome in Children and Adults: What Happens After Discharge? Cureus |
 "Covid-19" - Google News 23h "Covid-19" - Google News 23h |
 | Oxford BioMedica Sees Lower 2022 Revenue on Suspension of Covid-19 Vaccine With AstraZeneca... |
| Oxford BioMedica Sees Lower 2022 Revenue on Suspension of Covid-19 Vaccine With AstraZeneca MarketWatch |
 "Covid-19" - Google News 23h "Covid-19" - Google News 23h |
| New Infections Below 100000 for 4th Day as Omicron Slows - The Korea Bizwire |
| New Infections Below 100000 for 4th Day as Omicron Slows The Korea Bizwire |
 "Omicron" - Google News 23h "Omicron" - Google News 23h |
 | Dr. Ashish Jha predicts what's next with Covid-19 - CNN |
| Dr. Ashish Jha predicts what's next with Covid-19 CNN |
 "COVID-19" - Google News 23h "COVID-19" - Google News 23h |
| Disease X-19 Epidemiology from Michael_Novakhov (39 sites): Google Alert - coronavirus... |
| In Mayfield, a candle factory, a nursing home and government buildings were destroyed. Homes were ripped... |
 Disease X-19 from Michael_Novakhov (12 sites) 23h Disease X-19 from Michael_Novakhov (12 sites) 23h |
| Disease X-19 and Security from Michael_Novakhov (10 sites): Google Alert - Coronavirus... |
| COVID shots still work but researchers hunt new improvements ... US military drops appeal of Hawaii order... |
 Disease X-19 from Michael_Novakhov (12 sites) 23h Disease X-19 from Michael_Novakhov (12 sites) 23h |
| Disease X-19 General Issues from Michael_Novakhov (5 sites): Google Alert - Covid-19:... |
| China reported 21,796 new community transmitted COVID-19 infections on Sunday, with the vast majority... |
 Disease X-19 from Michael_Novakhov (12 sites) 23h Disease X-19 from Michael_Novakhov (12 sites) 23h |
| Disease X-19 and Security from Michael_Novakhov (10 sites): Google Alert - Coronavirus... |
| TRIPOLI, Lebanon (AP) — The Lebanese military Sunday recovered the bodies of five ... Overdoses, not... |
 Disease X-19 from Michael_Novakhov (12 sites) 23h Disease X-19 from Michael_Novakhov (12 sites) 23h |
| Disease X-19 and Security from Michael_Novakhov (10 sites): Google Alert - Coronavirus... |
| U.S. Air Force Maj. Gen. William T. Cooley, Air Force Research Laboratory commander, delivers remarks... |
 Disease X-19 from Michael_Novakhov (12 sites) 23h Disease X-19 from Michael_Novakhov (12 sites) 23h |
| Disease X-19 and Security from Michael_Novakhov (10 sites): Google Alert - Coronavirus... |
| Some parents are reconsidering travel plans after the U.S. dropped its mask mandate for airplanes. Photographer:... |
 Disease X-19 from Michael_Novakhov (12 sites) 23h Disease X-19 from Michael_Novakhov (12 sites) 23h |
| Disease X-19 Epidemiology from Michael_Novakhov (39 sites): Google Alert - coronavirus... |
| COVID-19 vaccinations are at a critical juncture as companies test ... of antibodies that can fend off... |
 Disease X-19 from Michael_Novakhov (12 sites) 23h Disease X-19 from Michael_Novakhov (12 sites) 23h |
| Disease X-19 Epidemiology from Michael_Novakhov (39 sites): Google Alert - coronavirus... |
| COVID-19 vaccinations are at a critical juncture as companies test ... modest levels of antibodies capable... |
 Disease X-19 from Michael_Novakhov (12 sites) 23h Disease X-19 from Michael_Novakhov (12 sites) 23h |
| Disease X-19 Epidemiology from Michael_Novakhov (39 sites): Google Alert - coronavirus... |
| COVID-19 vaccinations are at a critical juncture as companies test whether new approaches like combination... |
 Disease X-19 from Michael_Novakhov (12 sites) 23h Disease X-19 from Michael_Novakhov (12 sites) 23h |
| Disease X-19 Epidemiology from Michael_Novakhov (39 sites): Google Alert - coronavirus... |
| COVID-19 vaccinations are at a critical juncture as companies test ... recipients developed modest levels... |
 Disease X-19 from Michael_Novakhov (12 sites) 23h Disease X-19 from Michael_Novakhov (12 sites) 23h |
| Disease X-19 Epidemiology from Michael_Novakhov (39 sites): Google Alert - Coronavirus... |
| COVID-19 vaccines still offer strong protection against severe illness and death, but Moderna and Pfizer... |
 Disease X-19 from Michael_Novakhov (12 sites) 23h Disease X-19 from Michael_Novakhov (12 sites) 23h |
| Disease X-19 General Issues from Michael_Novakhov (5 sites): Google Alert - Latest... |
| ... COVID-19 newsletter to stay up-to-date on the latest coronavirus news ... seven of which are part... |
 Disease X-19 from Michael_Novakhov (12 sites) 23h Disease X-19 from Michael_Novakhov (12 sites) 23h |
| Disease X-19 Epidemiology from Michael_Novakhov (39 sites): Google Alert - Coronavirus... |
| Shanghai authorities battling an outbreak of Covid-19 have erected mesh ... has fuelled frustration over... |
 Disease X-19 from Michael_Novakhov (12 sites) 23h Disease X-19 from Michael_Novakhov (12 sites) 23h |
| Disease X-19 Epidemiology from Michael_Novakhov (39 sites): Google Alert - covid-19... |
| Julius R. Paner, the town's senior tourism operations officer, has issued an advisory that prohibits... |
 Disease X-19 from Michael_Novakhov (12 sites) 23h Disease X-19 from Michael_Novakhov (12 sites) 23h |
| Disease X-19 and Security from Michael_Novakhov (10 sites): Google Alert - Coronavirus... |
| Putin threatening 'high-risk cyber attacks' says expert ... with a series of cyberattacks aimed at institutions... |
 Disease X-19 from Michael_Novakhov (12 sites) 23h Disease X-19 from Michael_Novakhov (12 sites) 23h |
| Disease X-19 Epidemiology from Michael_Novakhov (39 sites): Google Alert - covid-19... |
| Beijing reports four newly confirmed COVID-19 cases and 10 silent ... an increase of 9.1 percent from... |
 Disease X-19 from Michael_Novakhov (12 sites) 23h Disease X-19 from Michael_Novakhov (12 sites) 23h |
| Disease X-19 Epidemiology from Michael_Novakhov (39 sites): Google Alert - coronavirus... |
| FILE – A healthcare worker fills a syringe with the Pfizer COVID-19 vaccine at Jackson Memorial Hospital... |
 Disease X-19 from Michael_Novakhov (12 sites) 23h Disease X-19 from Michael_Novakhov (12 sites) 23h |
| Start your week smart: Ukraine, French elections, Tyson Fury, Covid-19, Orrin Hatch... |
| Start your week smart: Ukraine, French elections, Tyson Fury, Covid-19, Orrin Hatch - Local News 8 LocalNews8.com |
 "Covid-19" - Google News 23h "Covid-19" - Google News 23h |
 | Nearly 100 test positive for COVID-19 after California prom - The Associated Press... |
| Nearly 100 test positive for COVID-19 after California prom The Associated Press - en Español |
 "Covid-19" - Google News 23h "Covid-19" - Google News 23h |
| With less societal masking, how to avoid catching COVID - NPR Illinois |
| With less societal masking, how to avoid catching COVID NPR Illinois |
 "COVID" - Google News 23h "COVID" - Google News 23h |
| Bedside table: Real-life COVID events make this novel gripping reading - Press Herald |
| Bedside table: Real-life COVID events make this novel gripping reading Press Herald |
 "COVID" - Google News 23h "COVID" - Google News 23h |
 | Liège-Bastogne-Liège a test for Brandon McNulty after COVID-19 illness - VeloNews |
| Liège-Bastogne-Liège a test for Brandon McNulty after COVID-19 illness VeloNews |
 "COVID-19" - Google News 23h "COVID-19" - Google News 23h |
 | COVID-19 Information - April 24, 2022 - Bonner County Daily Bee |
| COVID-19 Information - April 24, 2022 Bonner County Daily Bee |
 "COVID-19" - Google News 23h "COVID-19" - Google News 23h |
| Disease X-19 Regions from Michael_Novakhov (8 sites): Google Alert - coronavirus... |
| The global coronavirus caseload has topped 509.1 million, ... Germany, France, South Korea and Italy... |
 Disease X-19 from Michael_Novakhov (12 sites) 1d Disease X-19 from Michael_Novakhov (12 sites) 1d |
| Disease X-19 Regions from Michael_Novakhov (8 sites): Google Alert - coronavirus... |
| After extensive studies of how COVID spreads, scientists and policy ... classrooms in Italy found that... |
 Disease X-19 from Michael_Novakhov (12 sites) 1d Disease X-19 from Michael_Novakhov (12 sites) 1d |
Comments
Post a Comment